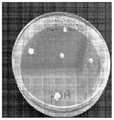

相关申请的交叉引用CROSS-REFERENCE TO RELATED APPLICATIONS
本申请要求2019年10月1日提交的美国临时申请号62/909,159的权益,所述临时申请以引用的方式整体并入本文。This application claims the benefit of US Provisional Application No. 62/909,159, filed October 1, 2019, which is incorporated herein by reference in its entirety.
背景技术Background technique
色胺衍生的物质,如真菌中的裸盖菇素和脱磷酸裸盖菇素是具有已知的致幻和其它药用效果的天然药物。药理学作用由经修饰的色胺引起,其中裸盖菇素是这些真菌的主要化学成分。这种前药样天然产物在口服摄入后变得迅速去磷酸化,从而产生实际精神药物脱磷酸裸盖菇素,它也由真菌少量产生。色胺衍生的物质引起了制药业的关注,因为临床研究显示在治疗晚期癌症患者的存在性焦虑和尼古丁成瘾方面有积极趋势。最近,正在进行研究以探讨裸盖菇素用于治疗抑郁症的用途。具有经修饰的治疗组分谱的真菌可用于生产色胺衍生的物质和/或还可用于生产提供所需药物谱的经遗传修饰的真菌。Tryptamine-derived substances such as psilocybin and dephosphorylated psilocybin in fungi are natural medicines with known hallucinogenic and other medicinal effects. The pharmacological effects are caused by modified tryptamines, of which psilocybin is the main chemical constituent of these fungi. This prodrug-like natural product becomes rapidly dephosphorylated upon oral ingestion, resulting in the actual psychoactive drug psilocybin, which is also produced in small amounts by fungi. Tryptamine-derived substances have attracted the attention of the pharmaceutical industry because clinical studies have shown positive trends in the treatment of existential anxiety and nicotine addiction in patients with advanced cancer. More recently, research is underway to explore the use of psilocybin for the treatment of depression. Fungi with modified therapeutic component profiles can be used to produce tryptamine-derived substances and/or can also be used to produce genetically modified fungi that provide a desired drug profile.
发明内容SUMMARY OF THE INVENTION
本文提供了一种包含遗传修饰的经遗传修饰的生物体或其细胞或组织,所述遗传修饰导致选自以下的化合物:Provided herein is a genetically modified organism or cell or tissue thereof comprising a genetic modification resulting in a compound selected from the group consisting of:
它们的衍生物或类似物的产生与没有所述遗传修饰的可比对照生物体中所述相同化合物的产生相比增加。本文还提供了一种包含核酸内切酶介导的遗传修饰的经遗传修饰的生物体,所述遗传修饰导致化合物其衍生物或类似物的量与没有所述遗传修饰的可比对照生物体中所述相同化合物的量相比增加。在一些情况下,所述生物体是真菌、酵母、细菌、动物或昆虫。在本文所述的实施方案中,所述式I化合物是二甲基色胺(DMT),所述式II化合物是裸盖菇素,所述式III化合物是脱磷酸裸盖菇素,并且所述式IV化合物是色胺。 The production of their derivatives or analogs is increased compared to the production of the same compounds in a comparable control organism without the genetic modification. Also provided herein is a genetically modified organism comprising an endonuclease-mediated genetic modification that results in a compound The amount of its derivative or analog is increased compared to the amount of the same compound in a comparable control organism without the genetic modification. In some cases, the organism is a fungus, yeast, bacteria, animal or insect. In embodiments described herein, the compound of formula I is dimethyltryptamine (DMT), the compound of formula II is psilocybin, the compound of formula III is psilocybin dephosphorylated, and the The compound of formula IV is tryptamine.
本文提供了一种用于增加生物体中DMT)、This paper provides a method for increasing the DMT),
(式III,脱磷酸裸盖菇素)或它们的衍生物或类似物的产生的方法,所述方法包括向所述生物体引入遗传修饰,其中所述遗传修饰导致与没有所述修饰的可比对照生物体相比,所述相同化合物的产生增加。本文提供了一种用于增加生物体中(式I,DMT)、(式II,裸盖菇素)、(式III,脱磷酸裸盖菇素)、(式IV,色胺)或它们的衍生物或类似物的产生的方法,所述方法包括引入对所述生物体的遗传修饰,其中所述遗传修饰导致与没有所述修饰的可比对照生物体相比,所述相同化合物的产生增加,其中所述生物体是真菌,并且其中所述真菌来自担子菌门。 A method for the production of (Formula III, psilocybin dephosphorylated) or derivatives or analogs thereof, said method comprising introducing into said organism a genetic modification, wherein said genetic modification results in a comparable performance as without said modification The production of the same compounds is increased compared to control organisms. This paper provides a method for increasing the (Formula I, DMT), (Formula II, psilocybin), (Formula III, dephosphorylated psilocybin), A method for the production of (formula IV, tryptamine) or derivatives or analogs thereof, said method comprising introducing a genetic modification to said organism, wherein said genetic modification results in a comparable control organism without said modification In comparison, the production of the same compound is increased, wherein the organism is a fungus, and wherein the fungus is from the phylum Basidiomycota.
在一些情况下,本文所述的经遗传修饰的生物体是植物。在一些情况下,本文所述的经遗传修饰的生物体是细菌。在一些情况下,细菌是农杆菌。在一些情况下,本文提供的经遗传修饰的生物体是真菌。在一些情况下,所述真菌是担子菌门真菌。在一些情况下,所述担子菌门真菌可选自由以下组成的组:裸盖菇属、锥盖伞属、裸伞属、斑褶菇属、光柄菇属和球盖菇属。在一些情况下,真菌是暗蓝斑褶菇。在一些情况下,真菌是古巴斑褶菇。在一些情况下,真菌是白灵侧耳。In some cases, the genetically modified organisms described herein are plants. In some cases, the genetically modified organisms described herein are bacteria. In some cases, the bacterium is Agrobacterium. In some cases, the genetically modified organisms provided herein are fungi. In some cases, the fungus is a Basidiomycota fungus. In some cases, the Basidiomycota fungi can be selected from the group consisting of Psilocybe, Cone, Pseudo, Pleurotus, Pleurotus, and Spheromus. In some cases, the fungus is Pleurotus leucocephalus. In some cases, the fungus is Cuban Mushrooms. In some cases, the fungus is Bailing Pleurotus.
在一个方面,本文所述的经遗传修饰的生物体包含遗传修饰,所述遗传修饰是基因或基因的启动子或增强子中或邻近的改变,并且其中所述基因编码非PLP依赖性磷脂酰丝氨酸脱羧酶、色氨酸脱羧酶(TDC)、5-甲基硫代核糖家族小分子激酶、4-羟色胺激酶、I类甲基转移酶、易化子型转运蛋白PsiT1或易化子型转运蛋白PsiT2。In one aspect, the genetically modified organisms described herein comprise a genetic modification that is an alteration in or adjacent to a gene or a promoter or enhancer of a gene, and wherein the gene encodes a PLP-independent phosphatidyl Serine decarboxylase, tryptophan decarboxylase (TDC), 5-methylthioribose family small molecule kinase, serotonin kinase, class I methyltransferase, facilitator-type transporter PsiT1 or facilitator-type transporter Protein PsiT2.
在一个方面,本文所述的生物体中的遗传修饰导致以下至少一者:与没有所述遗传修饰的可比对照生物体相比,所述经遗传修饰的生物体中(a)色氨酸脱羧增加,(b)色胺4-羟基化增加,(c)4-羟色胺O-磷酸化增加,以及(d)通过连续N-甲基化的裸盖菇素产生增加且脱磷酸裸盖菇素中间体的表达降低。在一些情况下,遗传修饰导致与没有所述遗传修饰的可比对照生物体相比,所述经遗传修饰的生物体中(i)色氨酸脱羧酶基因、裸盖菇素相关的羟化酶基因、裸盖菇素相关的N-甲基转移酶基因或裸盖菇素相关的磷酸转移酶基因的表达上调;(ii)非裸盖菇素色胺的合成减少;或(iii)色氨酸的产生增加。In one aspect, a genetic modification in an organism described herein results in at least one of: (a) decarboxylation of tryptophan in the genetically modified organism compared to a comparable control organism without the genetic modification increased, (b) increased tryptamine 4-hydroxylation, (c) increased 4-hydroxytryptamine O-phosphorylation, and (d) increased psilocybin production via sequential N-methylation and dephosphorylated psilocybin The expression of the intermediate is reduced. In some cases, the genetic modification results in (i) a tryptophan decarboxylase gene, psilocybin-related hydroxylase, in the genetically modified organism compared to a comparable control organism without the genetic modification Up-regulation of expression of genes, psilocybin-related N-methyltransferase genes or psilocybin-related phosphotransferase genes; (ii) decreased synthesis of non-psilocybin tryptamines; or (iii) tryptophan Acid production increases.
在一个方面,遗传修饰可位于目标基因的启动子或增强子区域中,或与目标基因相关。在一些情况下,所述遗传修饰导致基因的表达上调。在一个方面,本文所述的目标基因编码非PLP性磷脂酰丝氨酸脱羧酶、色氨酸脱羧酶(TDC)、5-甲基硫代核糖家族小分子激酶、4-羟色胺激酶或I类甲基转移酶。一些情况下,本文所述的目标基因包含与SEQ ID NO:1的至少75%、至少85%、至少90%、至少95%或至少99%同一性。一些情况下,本文所述的目标基因包含与SEQ ID NO:2的至少75%、至少85%、至少90%、至少95%或至少99%同一性。一些情况下,本文所述的目标基因包含与SEQ ID NO:3的至少75%、至少85%、至少90%、至少95%或至少99%同一性。在一些情况下,本文所述的目标基因编码I类甲基转移酶。在一些情况下,I类甲基转移酶包含罗斯曼折叠(Rossmann-fold)。在一些情况下,I类甲基转移酶可以是去甲芽孢杆菌素(norbaeocystin)甲基转移酶。在一些情况下,本文所述的目标基因包含与SEQ ID NO:4的至少75%、至少85%、至少90%、至少95%或至少99%同一性。在一些情况下,本文所述的目标基因包含与SEQ ID NO:5的至少75%、至少85%、至少90%、至少95%或至少99%同一性。在一些情况下,本文所述的目标基因包含与SEQ ID NO:6的至少75%、至少85%、至少90%、至少95%或至少99%同一性。在一些情况下,本文所述的目标基因包含与SEQ ID NO:7的至少75%、至少85%、至少90%、至少95%或至少99%同一性。在一些情况下,本文所述的目标基因包含与SEQ ID NO:8的至少75%、至少85%、至少90%、至少95%或至少99%同一性。在一些情况下,本文所述的目标基因包含与SEQ ID NO:9的至少75%、至少85%、至少90%、至少95%或至少99%同一性。在一些情况下,本文所述的目标基因包含与SEQ ID NO:10的至少75%、至少85%、至少90%、至少95%或至少99%同一性。在一些情况下,本文所述的目标基因包含与SEQ ID NO:11的至少75%、至少85%、至少90%、至少95%或至少99%同一性。在一些情况下,本文所述的目标基因包含与SEQ ID NO:12的至少75%、至少85%、至少90%、至少95%或至少99%同一性。在一些情况下,本文所述的目标基因包含与SEQ ID NO:13的至少75%、至少85%、至少90%、至少95%或至少99%同一性。在一些情况下,本文所述的目标基因包含与SEQ ID NO:14的至少75%、至少85%、至少90%、至少95%或至少99%同一性。In one aspect, the genetic modification can be located in the promoter or enhancer region of the gene of interest, or associated with the gene of interest. In some cases, the genetic modification results in up-regulation of gene expression. In one aspect, the gene of interest described herein encodes a non-PLP phosphatidylserine decarboxylase, tryptophan decarboxylase (TDC), 5-methylthioribose family small molecule kinase, serotonin kinase, or class I methyl group transferase. In some cases, a gene of interest described herein comprises at least 75%, at least 85%, at least 90%, at least 95%, or at least 99% identity to SEQ ID NO:1. In some cases, the gene of interest described herein comprises at least 75%, at least 85%, at least 90%, at least 95%, or at least 99% identity to SEQ ID NO:2. In some cases, a gene of interest described herein comprises at least 75%, at least 85%, at least 90%, at least 95%, or at least 99% identity to SEQ ID NO:3. In some cases, the gene of interest described herein encodes a class I methyltransferase. In some cases, the class I methyltransferases comprise a Rossmann-fold. In some cases, the Class I methyltransferase can be a norbaeocystin methyltransferase. In some cases, a gene of interest described herein comprises at least 75%, at least 85%, at least 90%, at least 95%, or at least 99% identity to SEQ ID NO:4. In some cases, a gene of interest described herein comprises at least 75%, at least 85%, at least 90%, at least 95%, or at least 99% identity to SEQ ID NO:5. In some cases, a gene of interest described herein comprises at least 75%, at least 85%, at least 90%, at least 95%, or at least 99% identity to SEQ ID NO:6. In some cases, a gene of interest described herein comprises at least 75%, at least 85%, at least 90%, at least 95%, or at least 99% identity to SEQ ID NO:7. In some cases, a gene of interest described herein comprises at least 75%, at least 85%, at least 90%, at least 95%, or at least 99% identity to SEQ ID NO:8. In some cases, a gene of interest described herein comprises at least 75%, at least 85%, at least 90%, at least 95%, or at least 99% identity to SEQ ID NO:9. In some cases, a gene of interest described herein comprises at least 75%, at least 85%, at least 90%, at least 95%, or at least 99% identity to SEQ ID NO:10. In some cases, a gene of interest described herein comprises at least 75%, at least 85%, at least 90%, at least 95%, or at least 99% identity to SEQ ID NO:11. In some cases, a gene of interest described herein comprises at least 75%, at least 85%, at least 90%, at least 95%, or at least 99% identity to SEQ ID NO:12. In some cases, a gene of interest described herein comprises at least 75%, at least 85%, at least 90%, at least 95%, or at least 99% identity to SEQ ID NO:13. In some cases, a gene of interest described herein comprises at least 75%, at least 85%, at least 90%, at least 95%, or at least 99% identity to SEQ ID NO:14.
在一些情况下,基因可以是PsiD基因、PsiM基因、PsiH基因、PsiK基因、PsiR基因、PsiT1基因或PsiT2基因,或它们的任何部分。在一些情况下,与没有所述遗传修饰的可比对照生物体相比,在经遗传修饰的生物体中基因的表达被上调至少1.1倍、至少1.2倍、至少1.5倍、至少2倍、至少2.5倍、至少3倍、至少3.5倍、至少4倍或至少5倍。在一些情况下,本文所述的经遗传修饰的生物体中的遗传修饰包括选自由以下组成的组的基因的改变:吲哚胺2,3-双加氧酶(IDO)、色氨酸2,3-双加氧酶(TDO)和TrpM。在一些情况下,遗传修饰可位于所述基因的编码区中。在一些情况下,遗传修饰包括选自由以下组成的组的基因的改变:磷酸-2-脱氢-3-脱氧庚酸醛缩酶、3-脱氢奎尼酸合酶、3-脱氢奎尼酸脱水酶、莽草酸脱氢酶、3-磷酸莽草酸1-羧基乙烯基转移酶、莽草酸激酶1、莽草酸激酶2、分支酸合酶、色氨酸合酶α链、色氨酸合酶β链、邻氨基苯甲酸磷酸核糖基转移酶和邻氨基苯甲酸合酶。In some cases, the gene can be a PsiD gene, a PsiM gene, a PsiH gene, a PsiK gene, a PsiR gene, a PsiT1 gene, or a PsiT2 gene, or any portion thereof. In some cases, the expression of a gene is up-regulated by at least 1.1-fold, at least 1.2-fold, at least 1.5-fold, at least 2-fold, at least 2.5-fold in the genetically modified organism compared to a comparable control organism without the genetic modification times, at least 3 times, at least 3.5 times, at least 4 times, or at least 5 times. In some cases, the genetic modification in the genetically modified organisms described herein includes alterations in a gene selected from the group consisting of
在一个方面,遗传修饰可位于基因的启动子区域中。在一些情况下,经遗传修饰的生物体包含与没有所述遗传修饰的可比对照生物体相比,按干重测量的多25%的(式IV)。在一些情况下,经遗传修饰的生物体包含与没有所述遗传修饰的可比对照生物体相比,按干重测量的多25%的裸盖菇素。在一些情况下,经遗传修饰的生物体包含与没有所述遗传修饰的可比对照生物体相比,按干重测量的多10%的脱磷酸裸盖菇素。In one aspect, the genetic modification can be located in the promoter region of the gene. In some cases, the genetically modified organism comprises 25% more, as measured by dry weight, compared to a comparable control organism without the genetic modification (Formula IV). In some cases, the genetically modified organism comprises 25% more psilocybin, measured by dry weight, than a comparable control organism without the genetic modification. In some cases, the genetically modified organism comprises 10% more psilocybin dephosphorylated by dry weight as compared to a comparable control organism without the genetic modification.
在一些情况下,可通过使生物体的细胞与核酸内切酶系统接触来进行遗传修饰。在一个方面,核酸内切酶系统包含CRISPR酶、TALE-核酸酶、基于转座子的核酸酶、锌指核酸酶、大范围核酸酶、argonaute、Mega-TAL或DNA引导的核酸酶。在一个方面,DNA引导的核酸酶包含argonaute。在一些情况下,核酸内切酶系统包含CRISPR酶和引导多核苷酸,所述引导多核苷酸与所述基因或与所述基因相关的启动子或增强子中或邻近的靶序列杂交。在一些情况下,靶序列的长度可以是至少18个核苷酸、至少19个核苷酸、至少20个核苷酸、至少21个核苷酸或至少22个核苷酸。在一些情况下,靶序列的长度是至多17个核苷酸。在一些情况下,靶序列可与SEQ ID NO:1-14中的至少一个或其互补序列杂交。在一些情况下,引导多核苷酸可以是经化学修饰的。在一个方面,引导多核苷酸是单引导RNA(sgRNA)。在一个方面,引导多核苷酸可以是包含RNA和DNA的嵌合单引导。在一些情况下,引导多核苷酸可与SEQ ID NO:1-14中的至少一个或其互补序列杂交。In some cases, genetic modification can be made by contacting cells of the organism with an endonuclease system. In one aspect, the endonuclease system comprises a CRISPR enzyme, TALE-nuclease, transposon-based nuclease, zinc finger nuclease, meganuclease, argonaute, Mega-TAL, or DNA-guided nuclease. In one aspect, the DNA-guided nuclease comprises an argonaute. In some cases, the endonuclease system comprises a CRISPR enzyme and a guide polynucleotide that hybridizes to a target sequence in or adjacent to the gene or a promoter or enhancer associated with the gene. In some cases, the target sequence can be at least 18 nucleotides, at least 19 nucleotides, at least 20 nucleotides, at least 21 nucleotides, or at least 22 nucleotides in length. In some cases, the target sequence is up to 17 nucleotides in length. In some cases, the target sequence can hybridize to at least one of SEQ ID NOs: 1-14 or the complement thereof. In some cases, the guide polynucleotide can be chemically modified. In one aspect, the guide polynucleotide is a single guide RNA (sgRNA). In one aspect, the guide polynucleotide can be a chimeric single guide comprising RNA and DNA. In some cases, the guide polynucleotide can hybridize to at least one of SEQ ID NOs: 1-14 or the complement thereof.
在一些情况下,CRISPR酶可以是Cas蛋白或其变体或衍生物。在一些情况下,Cas蛋白包括Cas1、Cas1B、Cas2、Cas3、Cas4、Cas5、Cas5d、Cas5t、Cas5h、Cas5a、Cas6、Cas7、Cas8、Cas9、Cas10、Csy1、Csy2、Csy3、Csy4、Cse1、Cse2、Cse3、Cse4、Cse5e、Csc1、Csc2、Csa5、Csn1、Csn2、Csm1、Csm2、Csm3、Csm4、Csm5、Csm6、Cmr1、Cmr3、Cmr4、Cmr5、Cmr6、Csb1、Csb2、Csb3、Csx17、Csx14、Csx10、Csx16、CsaX、Csx3、Csx1、Csx1S、Csf1、Csf2、CsO、Csf4、Csd1、Csd2、Cst1、Cst2、Csh1、Csh2、Csa1、Csa2、Csa3、Csa4、Csa5、C2c1、C2c2、C2c3、Cpf1、CARF、DinG、它们的同系物或它们的经修饰型式。在一些情况下,Cas蛋白可以是Cas9。在一些情况下,Cas9是与规范PAM结合的经修饰的Cas9。在一些情况下,Cas9识别非规范PAM。在一些情况下,引导多核苷酸结合距PAM 3-10个核苷酸的靶序列。在一些情况下,与引导多核苷酸偶联的CRISPR酶可作为RNP递送至经遗传修饰的生物体中。在一些情况下,与引导多核苷酸偶联的CRISPR酶可通过编码所述CRISPR酶和所述引导多核苷酸的mRNA递送至经遗传修饰的生物体中。In some cases, the CRISPR enzyme can be a Cas protein or a variant or derivative thereof. In some cases, the Cas protein includes Cas1, Cas1B, Cas2, Cas3, Cas4, Cas5, Cas5d, Cas5t, Cas5h, Cas5a, Cas6, Cas7, Cas8, Cas9, Cas10, Csy1, Csy2, Csy3, Csy4, Cse1, Cse2, Cse3, Cse4, Cse5e, Csc1, Csc2, Csa5, Csn1, Csn2, Csm1, Csm2, Csm3, Csm4, Csm5, Csm6, Cmr1, Cmr3, Cmr4, Cmr5, Cmr6, Csb1, Csb2, Csb3, Csx17, Csx14, Csx10, Csx16, CsaX, Csx3, Csx1, Csx1S, Csf1, Csf2, CsO, Csf4, Csd1, Csd2, Cst1, Cst2, Csh1, Csh2, Csa1, Csa2, Csa3, Csa4, Csa5, C2c1, C2c2, C2c3, Cpf1, CARF, DinG, their homologs or their modified versions. In some cases, the Cas protein can be Cas9. In some cases, the Cas9 is a modified Cas9 that binds to a canonical PAM. In some cases, Cas9 recognizes non-canonical PAMs. In some cases, the guide polynucleotide binds to a target sequence 3-10 nucleotides from the PAM. In some cases, a CRISPR enzyme coupled to a guide polynucleotide can be delivered as an RNP into a genetically modified organism. In some cases, a CRISPR enzyme coupled to a guide polynucleotide can be delivered into a genetically modified organism via mRNA encoding the CRISPR enzyme and the guide polynucleotide.
在一些情况下,与引导多核苷酸偶联的CRISPR酶可通过包含编码所述CRISPR酶和所述引导多核苷酸的核酸的载体递送至经遗传修饰的生物体中。在一个方面,载体可以是二元载体或Ti质粒。在一个方面,载体还包含选择标记物或报告基因。在一些情况下,RNP、复合物或载体可通过电穿孔、显微注射、机械细胞变形、脂质纳米粒子、AAV、慢病毒、农杆菌介导的转化、生物射弹粒子轰击或原生质体转化进行递送。在一些情况下,RNP、mRNA或载体还包含供体多核苷酸或编码所述供体多核苷酸的核酸。在一个方面,供体多核苷酸包含与位于靶序列侧翼的序列的同源性。在一个方面,供体多核苷酸还包含条形码、报告基因或选择标记物。In some cases, a CRISPR enzyme coupled to a guide polynucleotide can be delivered into a genetically modified organism by a vector comprising nucleic acid encoding the CRISPR enzyme and the guide polynucleotide. In one aspect, the vector can be a binary vector or a Ti plasmid. In one aspect, the vector further comprises a selectable marker or reporter gene. In some cases, the RNP, complex or vector can be transformed by electroporation, microinjection, mechanical cell deformation, lipid nanoparticles, AAV, lentivirus, Agrobacterium-mediated transformation, biolistic particle bombardment, or protoplast transformation to deliver. In some cases, the RNP, mRNA or vector further comprises a donor polynucleotide or nucleic acid encoding the donor polynucleotide. In one aspect, the donor polynucleotide comprises homology to sequences flanking the target sequence. In one aspect, the donor polynucleotide further comprises a barcode, reporter gene or selectable marker.
在另一个方面,所述经遗传修饰的生物体包含外源核苷酸。在一些情况下,所述外源核苷酸包含顺式作用启动子序列。在一些情况下,所述外源核苷酸导致与不含所述外源核苷酸的可比对照生物体相比,所述经遗传修饰的生物体中色氨酸脱羧、色胺4-羟基化、4-羟色胺O-磷酸化或在没有脱磷酸裸盖菇素中间体的情况下通过连续N-甲基化的裸盖菇素产生增加。在一些情况下,所述外源核苷酸导致与没有所述外源核苷酸的可比对照生物体相比,所述经遗传修饰的生物体中(i)色氨酸脱羧酶基因、裸盖菇素相关的羟化酶基因、裸盖菇素相关的N-甲基转移酶基因或裸盖菇素相关的磷酸转移酶基因的表达上调;(ii)非裸盖菇素色胺的合成减少;或(iii)色氨酸的产生增加。在一些情况下,所述外源核苷酸编码非PLP依赖性磷脂酰丝氨酸脱羧酶、色氨酸脱羧酶(TDC)、推定单加氧酶、5-甲基硫代核糖家族小分子激酶或4-羟色胺激酶。In another aspect, the genetically modified organism comprises exogenous nucleotides. In some cases, the exogenous nucleotide comprises a cis-acting promoter sequence. In some cases, the exogenous nucleotide results in decarboxylation of tryptophan, tryptophan 4-hydroxyl in the genetically modified organism as compared to a comparable control organism without the exogenous nucleotide Increased production of psilocybin by continuous N-methylation, serotonin O-phosphorylation, or in the absence of dephosphorylated psilocybin intermediates. In some cases, the exogenous nucleotide results in (i) a tryptophan decarboxylase gene, naked, in the genetically modified organism as compared to a comparable control organism without the exogenous nucleotide Up-regulated expression of psilocybin-related hydroxylase gene, psilocybin-related N-methyltransferase gene or psilocybin-related phosphotransferase gene; (ii) synthesis of non-psilocybin tryptamine decrease; or (iii) increase in tryptophan production. In some cases, the exogenous nucleotide encodes a PLP-independent phosphatidylserine decarboxylase, tryptophan decarboxylase (TDC), putative monooxygenase, 5-methylthioribose family small molecule kinase, or 4-hydroxytryptamine kinase.
在一些情况下,所述核苷酸并入质粒中。在一些情况下,所述质粒是pGWB5或pGHGWY。在一些情况下,所述质粒通过电穿孔、显微注射、机械细胞变形、脂质纳米粒子、AAV、慢病毒、农杆菌介导的转化、生物射弹粒子轰击或原生质体转化递送至所述经遗传修饰的生物体中。在一些情况下,所述质粒还包含条形码、报告基因或选择标记物。在一些情况下,所述质粒还包含启动子。在一些情况下,所述启动子是35S、GPD、EF1a、肌动蛋白或CcDED1。In some cases, the nucleotides are incorporated into a plasmid. In some cases, the plasmid is pGWB5 or pGHGWY. In some cases, the plasmid is delivered to the said plasmid by electroporation, microinjection, mechanical cell deformation, lipid nanoparticles, AAV, lentivirus, Agrobacterium-mediated transformation, biolistic particle bombardment, or protoplast transformation in genetically modified organisms. In some cases, the plasmid further comprises a barcode, reporter gene or selectable marker. In some cases, the plasmid also includes a promoter. In some cases, the promoter is 35S, GPD, EF1a, actin, or CcDED1.
在本文所述的实施方案中,经遗传修饰的生物体可以是多细胞或单细胞生物体。在某些实施方案中,所述生物体可以是单个植物或真菌细胞。本文所述的实施方案还包括细胞群体,例如来自本文所述的真菌物种的细胞群体。In the embodiments described herein, the genetically modified organism can be a multicellular or unicellular organism. In certain embodiments, the organism can be a single plant or fungal cell. Embodiments described herein also include cell populations, eg, cell populations from the fungal species described herein.
本文提供了一种用于基因组编辑的药盒,所述药盒包括本文提供的组合物。本文还提供了一种包含本文提供的组合物的细胞。细胞可以是植物细胞。在一些情况下,细胞是真菌细胞。在一些情况下,细胞是细菌细胞。在一些情况下,细胞是动物细胞。在一些情况下,细胞是昆虫细胞。本文提供了一种药物组合物,所述药物组合物包含经遗传修饰的生物体的提取物、经遗传修饰的细胞、组合物或细胞。在一个方面,药物组合物还包含药学上可接受的赋形剂、稀释剂或载体。在一些情况下,药学上可接受的赋形剂是脂质。Provided herein is a kit for genome editing comprising a composition provided herein. Also provided herein is a cell comprising the composition provided herein. The cells can be plant cells. In some cases, the cells are fungal cells. In some cases, the cells are bacterial cells. In some cases, the cells are animal cells. In some cases, the cells are insect cells. Provided herein is a pharmaceutical composition comprising an extract of a genetically modified organism, a genetically modified cell, a composition or a cell. In one aspect, the pharmaceutical composition further comprises a pharmaceutically acceptable excipient, diluent or carrier. In some cases, the pharmaceutically acceptable excipient is a lipid.
本文提供了一种营养食品组合物,所述营养食品组合物包含经遗传修饰的生物体的提取物、经遗传修饰的细胞、组合物或细胞。本文提供了一种食品补充剂组合物,所述食品补充剂组合物包含经遗传修饰的生物体的提取物、经遗传修饰的细胞、组合物或细胞。在一个方面,营养食品组合物或食品补充剂可呈口服形式、透皮形式、油制剂、可食用食品、食品基质、水性分散液、乳液、溶液、悬浮液、酏剂、凝胶、糖浆、气雾剂、喷雾剂、粉末、片剂、锭剂、凝胶、洗剂、糊剂、配制棒、香膏、乳膏或软膏形式。Provided herein is a nutraceutical composition comprising an extract of a genetically modified organism, a genetically modified cell, a composition or a cell. Provided herein is a food supplement composition comprising an extract of a genetically modified organism, a genetically modified cell, a composition or a cell. In one aspect, the nutraceutical composition or food supplement can be in oral form, transdermal form, oil formulation, edible food, food base, aqueous dispersion, emulsion, solution, suspension, elixir, gel, syrup, In the form of aerosol, spray, powder, tablet, lozenge, gel, lotion, paste, stick, balm, cream or ointment.
本文提供了一种治疗疾病或疾患的方法,所述方法包括向受试者施用药物组合物、营养食品组合物或食品补充剂。在一个方面,疾病或疾患选自由以下组成的组:抑郁、焦虑、创伤后应激障碍、成瘾或分离相关的副作用、心理困扰以及精神障碍和疾患。Provided herein is a method of treating a disease or disorder comprising administering to a subject a pharmaceutical composition, nutraceutical composition or food supplement. In one aspect, the disease or disorder is selected from the group consisting of depression, anxiety, post-traumatic stress disorder, addiction or separation-related side effects, psychological distress, and mental disorders and disorders.
在某些实施方案中,如本文所述的经遗传修饰的生物体可以是真菌、酵母、植物、动物、细菌。在一些情况下,真菌是蘑菇。在一些情况下,蘑菇可产生以下中的至少一者:二甲基色胺(DMT)、裸盖菇素、脱磷酸裸盖菇素和/或它们的任何组合。In certain embodiments, the genetically modified organisms as described herein can be fungi, yeast, plants, animals, bacteria. In some cases, the fungus is a mushroom. In some cases, the mushroom can produce at least one of dimethyltryptamine (DMT), psilocybin, psilocybin dephosphorylated, and/or any combination thereof.
以引用的方式并入incorporated by reference
本说明书中提及的所有公布、专利和专利申请以引用的方式并入本文,就如每个单独的公布、专利或专利申请被具体地和单独地指出以引用的方式并入的程度一样。All publications, patents and patent applications mentioned in this specification are incorporated herein by reference to the same extent as if each individual publication, patent or patent application was specifically and individually indicated to be incorporated by reference.
附图说明Description of drawings
本发明的新颖特征在随附权利要求书中具体阐述。通过参考以下阐述使用本发明原理的说明性实施方案的详细描述和附图将获得对本发明的特征和优点的更好理解,在附图中:The novel features of the invention are set forth with particularity in the appended claims. A better understanding of the features and advantages of the present invention will be obtained by reference to the following detailed description and accompanying drawings, which illustrate illustrative embodiments that employ the principles of the invention, in which:
图1示出用于古巴裸盖菇(I)和暗蓝裸盖菇(II)中的生物合成的同线基因座(Psi)的示意图。参与酶促合成的基因以粗体标记。簇包括激酶(PsiK)、甲基转移酶(PsiM)、色氨酸脱羧酶(PsiD)和P450单加氧酶(PsiH)的基因。此外,编码并示出两种易化子型转运蛋白(PsiT1和PsiT2)和推定转录调控因子(PsiR)。假定基因以浅灰色示出。内含子未示出。Figure 1 shows a schematic representation of the syntenic loci (Psi) used for biosynthesis in Psilocybe cuban (I) and Psilocybe indigo (II). Genes involved in enzymatic synthesis are marked in bold. The cluster includes genes for kinase (PsiK), methyltransferase (PsiM), tryptophan decarboxylase (PsiD), and P450 monooxygenase (PsiH). In addition, two facilitator-type transporters (PsiT1 and PsiT2) and putative transcriptional regulators (PsiR) are encoded and shown. Putative genes are shown in light grey. Introns are not shown.
图2描绘代表性的裸盖菇素体外生物合成途径。Figure 2 depicts a representative psilocybin biosynthetic pathway in vitro.
图3示出用于本文所述的经遗传修饰的生物体和细胞的代表性载体构建体,所述载体构建体在35S启动子控制下过表达Psi基因:图3A示出在35S启动子控制下过表达PsiD基因的代表性载体;图3B示出在35S启动子控制下过表达PsiH基因的代表性载体;图3C示出在35S启动子控制下过表达PsiK基因的代表性载体;图3D示出在35S启动子控制下过表达PsiM基因的代表性载体。Figure 3 shows representative vector constructs for the genetically modified organisms and cells described herein that overexpress the Psi gene under the control of the 35S promoter: Figure 3A shows that the Psi gene is under the control of the 35S promoter A representative vector for overexpressing the PsiD gene under the control of the 35S promoter; Figure 3B shows a representative vector for overexpressing the PsiH gene under the control of the 35S promoter; Figure 3C shows a representative vector for overexpressing the PsiK gene under the control of the 35S promoter; Figure 3D A representative vector overexpressing the PsiM gene under the control of the 35S promoter is shown.
图4示出用于本文所述的经遗传修饰的生物体和细胞的代表性载体构建体,所述载体构建体在真菌特异性过表达启动子的控制下过表达基因:图4A示出具有CcDED1启动子的代表性载体;图4B示出具有GPD启动子的代表性载体。Figure 4 shows representative vector constructs for the genetically modified organisms and cells described herein that overexpress genes under the control of fungal specific overexpression promoters: Figure 4A shows a A representative vector of the CcDED1 promoter; Figure 4B shows a representative vector with the GPD promoter.
图5示出古巴裸盖菇中Psi基因过表达的策略和工作流程。图5A示出一组具有不同强度的不同启动子的表达载体。图5B示出分离的原生质体和提取的菌褶组织。图5C示出用质粒DNA或农杆菌并入选择转化。图5D示出成体蘑菇的再生。图5E示出分析经遗传修饰的蘑菇的裸盖菇素含量。Figure 5 shows the strategy and workflow for Psi gene overexpression in psilocybin. Figure 5A shows a set of expression vectors with different promoters of different strengths. Figure 5B shows isolated protoplasts and extracted gill tissue. Figure 5C shows transformation with plasmid DNA or Agrobacterium incorporation selection. Figure 5D shows the regeneration of adult mushrooms. Figure 5E shows analysis of genetically modified mushrooms for psilocybin content.
图6示出用于组织提取和转化的生长古巴裸盖菇:将古巴裸盖菇在室温下在PDA琼脂(图6A和图6B)以及还在大麦-珍珠岩堆肥(图6C)中生长7天。Figure 6 shows the growth of psilocybin for tissue extraction and transformation: psilocybin was grown at room temperature on PDA agar (Figures 6A and 6B) and also in barley-perlite compost (Figure 6C) 7 sky.
具体实施方式Detailed ways
除非上下文另外明确规定,否则如在说明书和权利要求中所用,单数形式“一个/种(a/an)”和“所述”包括复数个提及物。例如,术语“嵌合跨膜受体多肽”包括多个嵌合跨膜受体多肽。As used in the specification and the claims, the singular forms "a/an" and "the" include plural referents unless the context clearly dictates otherwise. For example, the term "chimeric transmembrane receptor polypeptide" includes a plurality of chimeric transmembrane receptor polypeptides.
术语“约”或“大约”意指由本领域普通技术人员测定的特定值处于可接受的误差范围内,所述误差范围可部分取决于所述值的测量或测定方式,即测量系统的限制。例如,根据本领域的实践,“约”可意指在1个或超过1个标准偏差内。可替代地,“约”可意指给定值的至多20%、至多10%、至多5%或至多1%的范围。可替代地,特别是关于生物系统或方法,所述术语可意指在值的一个数量级以内,优选在5倍以内,且更优选在2倍以内。当特定值在申请和权利要求书中描述时,除非另外规定,否则应假定术语“约”意指在特定值的可接受误差范围内。The term "about" or "approximately" means that a particular value, as determined by one of ordinary skill in the art, is within an acceptable error range, which may depend in part on how the value is measured or determined, ie, limitations of the measurement system. For example, "about" can mean within 1 or more than 1 standard deviation, according to the practice in the art. Alternatively, "about" may mean a range of up to 20%, up to 10%, up to 5%, or up to 1% of the given value. Alternatively, particularly with respect to biological systems or methods, the term may mean within an order of magnitude, preferably within 5-fold, and more preferably within 2-fold of the value. When a particular value is described in the application and claims, unless otherwise specified, the term "about" should be assumed to mean within an acceptable error range for the particular value.
如本文所用,“细胞”通常可指生物细胞。细胞可以是活生物体的基本结构、功能和/或生物单元。细胞可源自具有一个或多个细胞的任何生物体。一些非限制性实例包括:原核细胞、真核细胞、细菌细胞、古细菌细胞、单细胞真核生物的细胞、原生动物细胞、来自植物的细胞、藻类细胞、海藻、真菌细胞、动物细胞、来自无脊椎动物的细胞、来自脊椎动物的细胞、来自哺乳动物的细胞等。有时细胞并非源自天然生物体(例如,细胞可以是合成制造的,有时称为人工细胞)。As used herein, "cell" can generally refer to a biological cell. A cell can be the basic structural, functional and/or biological unit of a living organism. Cells can be derived from any organism having one or more cells. Some non-limiting examples include: prokaryotic cells, eukaryotic cells, bacterial cells, archaeal cells, cells of unicellular eukaryotes, protozoan cells, cells from plants, algal cells, algae, fungal cells, animal cells, cells from Invertebrate cells, vertebrate cells, mammalian cells, etc. Sometimes cells are not derived from natural organisms (eg, cells can be manufactured synthetically, sometimes referred to as artificial cells).
如本文所用,术语“基因”是指可参与编码RNA转录物的核酸(例如,DNA,如基因组DNA和cDNA)及其相应的核苷酸序列。如本文关于基因组DNA所用的术语包括插入非编码区以及调控区并且可包括5'和3'端。在一些使用中,所述术语涵盖转录序列,包括5'和3'非翻译区(5'-UTR和3'-UTR)、外显子和内含子。在一些基因中,转录区域可含有编码多肽的“开放阅读框”。在所述术语的一些使用中,“基因”仅包含编码多肽所必需的编码序列(例如,“开放阅读框”或“编码区”)。在一些情况下,基因不编码多肽,例如核糖体RNA基因(rRNA)和转移RNA(tRNA)基因。在一些情况下,术语“基因”不仅包括转录序列,而且此外还包括非转录区域,包括上游和下游调控区、增强子和启动子。基因可指“内源性基因”或生物体的基因组中的其天然位置的天然基因。基因可指“外源性基因”或非天然基因。非天然基因可指通常在宿主生物体中不存在、但可通过基因转移引入宿主生物体中的基因。非天然基因也可指不在生物体的基因组中的其天然位置的基因。非天然基因也可指包含突变、插入和/或缺失的天然存在的核酸或多肽序列(例如,非天然序列)。As used herein, the term "gene" refers to a nucleic acid (eg, DNA, such as genomic DNA and cDNA) that can participate in encoding RNA transcripts and its corresponding nucleotide sequence. The terms as used herein with respect to genomic DNA include insertions into non-coding regions as well as regulatory regions and may include both 5' and 3' ends. In some uses, the term encompasses transcribed sequences, including 5' and 3' untranslated regions (5'-UTR and 3'-UTR), exons, and introns. In some genes, the transcribed region may contain an "open reading frame" that encodes a polypeptide. In some uses of the term, a "gene" comprises only the coding sequence (eg, an "open reading frame" or "coding region") necessary to encode a polypeptide. In some cases, the genes do not encode polypeptides, such as ribosomal RNA genes (rRNA) and transfer RNA (tRNA) genes. In some instances, the term "gene" includes not only transcribed sequences, but also non-transcribed regions, including upstream and downstream regulatory regions, enhancers, and promoters. A gene may refer to an "endogenous gene" or a native gene in its natural location in the genome of an organism. A gene may refer to an "exogenous gene" or a non-native gene. A non-native gene can refer to a gene that is not normally present in the host organism, but can be introduced into the host organism by gene transfer. A non-native gene can also refer to a gene that is not in its natural location in the genome of an organism. A non-native gene may also refer to a naturally occurring nucleic acid or polypeptide sequence (eg, a non-native sequence) that contains mutations, insertions, and/or deletions.
如本文所用,术语“核苷酸”通常是指碱基-糖-磷酸组合。核苷酸可包含合成核苷酸。核苷酸可包含合成核苷酸类似物。核苷酸可以是核酸序列的单体单元(例如脱氧核糖核酸(DNA)和核糖核酸(RNA))。术语核苷酸可包括核糖核苷三磷酸腺苷三磷酸(ATP)、尿苷三磷酸(UTP)、胞嘧啶三磷酸(CTP)、鸟苷三磷酸(GTP)和脱氧核糖核苷三磷酸,如dATP、dCTP、dITP、dUTP、dGTP、dTTP或它们的衍生物。此类衍生物可包括例如[αS]dATP、7-脱氮-dGTP和7-脱氮-dATP,以及赋予含有它们的核酸分子核酸酶抗性的核苷酸衍生物。如本文所用的术语核苷酸可指双脱氧核糖核苷三磷酸(ddNTP)以及它们的衍生物。双脱氧核糖核苷三磷酸的说明性实例可包括但不限于ddATP、ddCTP、ddGTP、ddITP和ddTTP。核苷酸可未标记或通过众所周知的技术可检测地标记。也可用量子点进行标记。可检测标记可包括例如放射性同位素、荧光标记、化学发光标记、生物发光标记和酶标记。核苷酸的荧光标记可包括但不限于荧光素、5-羧基荧光素(FAM)、2'7'-二甲氧基-4'5-二氯-6-羧基荧光素(JOE)、罗丹明、6-羧基罗丹明(R6G)、N,N,N',N'-四甲基-6-羧基罗丹明(TAMRA)、6-羧基-X-罗丹明(ROX)、4-(4'二甲基氨基苯基偶氮基)苯甲酸(DABCYL)、瀑布蓝(Cascade Blue)、俄勒冈绿、德克萨斯红、花青和5-(2'-氨基乙基)氨基萘-1-磺酸(EDANS)。荧光标记的核苷酸的具体实例可包括可从Perkin Elmer,Foster City,Calif获得的[R6G]dUTP、[TAMRA]dUTP、[R110]dCTP、[R6G]dCTP、[TAMRA]dCTP、[JOE]ddATP、[R6G]ddATP、[FAM]ddCTP、[R110]ddCTP、[TAMRA]ddGTP、[ROX]ddTTP、[dR6G]ddATP、[dR110]ddCTP、[dTAMRA]ddGTP和[dROX]ddTTP;可从Amersham,Arlington Heights,Ill.获得的FluoroLink脱氧核苷酸、FluoroLink Cy3-dCTP、FluoroLink Cy5-dCTP、FluoroLink Fluor X-dCTP、FluoroLink Cy3-dUTP和FluoroLink Cy5-dUTP;可从Boehringer Mannheim,Indianapolis,Ind.获得的荧光素-15-dATP、荧光素-12-dUTP、四甲基-罗丹明-6-dUTP、IR770-9-dATP、荧光素-12-ddUTP、荧光素-12-UTP和荧光素-15-2'-dATP;以及可从Molecular Probes,Eugene,Oreg.获得的染色体标记的核苷酸、BODIPY-FL-14-UTP、BODIPY-FL-4-UTP、BODIPY-TMR-14-UTP、BODIPY-TMR-14-dUTP、BODIPY-TR-14-UTP、BODIPY-TR-14-dUTP、瀑布蓝7-UTP、瀑布蓝7-dUTP、荧光素-12-UTP、荧光素-12-dUTP、俄勒冈绿488-5-dUTP、罗丹明绿-5-UTP、罗丹明绿-5-dUTP、四甲基罗丹明-6-UTP、四甲基罗丹明-6-dUTP、德克萨斯红-5-UTP、德克萨斯红-5-dUTP和德克萨斯红-12-dUTP。核苷酸也可通过化学修饰进行标记或标示。化学修饰的单核苷酸可以是生物素-dNTP。生物素化dNTP的一些非限制性实例可包括生物素-dATP(例如,bio-N6-ddATP、生物素-14-dATP)、生物素-dCTP(例如,生物素-11-dCTP、生物素-14-dCTP)和生物素-dUTP(例如生物素-11-dUTP、生物素-16-dUTP、生物素-20-dUTP)。As used herein, the term "nucleotide" generally refers to a base-sugar-phosphate combination. Nucleotides may comprise synthetic nucleotides. Nucleotides may comprise synthetic nucleotide analogs. Nucleotides can be monomeric units of nucleic acid sequences (eg, deoxyribonucleic acid (DNA) and ribonucleic acid (RNA)). The term nucleotide may include ribonucleoside triphosphate adenosine triphosphate (ATP), uridine triphosphate (UTP), cytosine triphosphate (CTP), guanosine triphosphate (GTP) and deoxyribonucleoside triphosphates such as dATP, dCTP, dITP, dUTP, dGTP, dTTP or derivatives thereof. Such derivatives may include, for example, [αS]dATP, 7-deaza-dGTP, and 7-deaza-dATP, as well as nucleotide derivatives that confer nuclease resistance to nucleic acid molecules containing them. The term nucleotide as used herein may refer to dideoxyribonucleoside triphosphates (ddNTPs) and their derivatives. Illustrative examples of dideoxyribonucleoside triphosphates may include, but are not limited to, ddATP, ddCTP, ddGTP, ddITP, and ddTTP. Nucleotides can be unlabeled or detectably labeled by well-known techniques. Quantum dots can also be used for labeling. Detectable labels can include, for example, radioisotopes, fluorescent labels, chemiluminescent labels, bioluminescent labels, and enzymatic labels. Fluorescent labels of nucleotides may include, but are not limited to, fluorescein, 5-carboxyfluorescein (FAM), 2'7'-dimethoxy-4'5-dichloro-6-carboxyfluorescein (JOE), rhodane Ming, 6-carboxyrhodamine (R6G), N,N,N',N'-tetramethyl-6-carboxyrhodamine (TAMRA), 6-carboxy-X-rhodamine (ROX), 4-(4 'Dimethylaminophenylazo)benzoic acid (DABCYL), Cascade Blue, Oregon Green, Texas Red, Cyanine and 5-(2'-aminoethyl)aminonaphthalene-1 - Sulfonic acid (EDANS). Specific examples of fluorescently labeled nucleotides may include [R6G]dUTP, [TAMRA]dUTP, [R110]dCTP, [R6G]dCTP, [TAMRA]dCTP, [JOE] available from Perkin Elmer, Foster City, Calif. ddATP, [R6G]ddATP, [FAM]ddCTP, [R110]ddCTP, [TAMRA]ddGTP, [ROX]ddTTP, [dR6G]ddATP, [dR110]ddCTP, [dTAMRA]ddGTP, and [dROX]ddTTP; available from Amersham FluoroLink Deoxynucleotides, FluoroLink Cy3-dCTP, FluoroLink Cy5-dCTP, FluoroLink Fluor X-dCTP, FluoroLink Cy3-dUTP, and FluoroLink Cy5-dUTP, available from Arlington Heights, Ill.; available from Boehringer Mannheim, Indianapolis, Ind. Fluorescein-15-dATP, Fluorescein-12-dUTP, Tetramethyl-rhodamine-6-dUTP, IR770-9-dATP, Fluorescein-12-ddUTP, Fluorescein-12-UTP and Fluorescein-15 -2'-dATP; and chromosomally labeled nucleotides available from Molecular Probes, Eugene, Oreg., BODIPY-FL-14-UTP, BODIPY-FL-4-UTP, BODIPY-TMR-14-UTP, BODIPY -TMR-14-dUTP, BODIPY-TR-14-UTP, BODIPY-TR-14-dUTP, Waterfall Blue 7-UTP, Waterfall Blue 7-dUTP, Fluorescein-12-UTP, Fluorescein-12-dUTP, Oregon Green 488-5-dUTP, Rhodamine Green-5-UTP, Rhodamine Green-5-dUTP, Tetramethylrhodamine-6-UTP, Tetramethylrhodamine-6-dUTP, Texas Red-5 -UTP, Texas Red-5-dUTP and Texas Red-12-dUTP. Nucleotides can also be labeled or labeled by chemical modification. The chemically modified mononucleotide can be a biotin-dNTP. Some non-limiting examples of biotinylated dNTPs can include biotin-dATP (eg, bio-N6-ddATP, biotin-14-dATP), biotin-dCTP (eg, biotin-11-dCTP, biotin- 14-dCTP) and biotin-dUTP (eg, biotin-11-dUTP, biotin-16-dUTP, biotin-20-dUTP).
提及两个核苷酸序列之间的序列同一性百分比是指当比对时,在比较两个序列时相同的核苷酸的百分比。这种比对和同源性或序列同一性百分比可使用本领域中已知的软件程序来确定,例如在Current Protocols in Molecular Biology(F.M.Ausubel等人编,1987)增刊30(以引用的方式并入)的第7.7.18节中描述的那些软件程序。通过Smith-Waterman同源性搜索算法使用仿射空位搜索,空位开放罚分为12和空位延伸罚分为2、BLOSUM矩阵为62来确定优选的比对。Smith-Waterman同源性搜索算法公开于Smith和Waterman(1981)Adv.Appl.Math.2:482-489(以引用的方式并入)中。Reference to percent sequence identity between two nucleotide sequences refers to the percent of nucleotides that are identical when the two sequences are compared when aligned. Such alignment and percent homology or sequence identity can be determined using software programs known in the art, for example in Current Protocols in Molecular Biology (F.M. Ausubel et al., eds., 1987) Supplement 30 (incorporated by reference). those software programs described in Section 7.7.18 of entry). Preferred alignments were determined by the Smith-Waterman homology search algorithm using an affine gap search with a gap opening penalty of 12 and a gap extension penalty of 2 and a BLOSUM matrix of 62. The Smith-Waterman homology search algorithm is disclosed in Smith and Waterman (1981) Adv. Appl. Math. 2:482-489 (incorporated by reference).
如本文所用,术语“植物”包括整株植物和植物的任何后代、细胞、组织或部分。可在本公开中使用的植物的类别通常可与适于诱变的高等植物和低等植物的类别一样广泛,包括被子植物(单子叶植物和双子叶植物)、裸子植物、蕨类植物和多细胞藻类。因此,“植物”包括双子叶植物和单子叶植物。术语“植物部分”包括植物的任何部分,包括例如但不限于:种子(包括成熟种子和未成熟种子);植物插条;植物细胞;植物细胞培养物;植物器官(例如,花粉、胚、花、果实、芽、叶、根、茎和外植体)。植物组织或植物器官可以是种子、原生质体、愈伤组织或可组构成结构或功能单元的任何其它植物细胞组。植物细胞或组织培养物可能能够再生具有从其获得细胞或组织的植物的生理学和形态学特征的植物,以及再生具有与所述植物基本相同基因型的植物。相比之下,一些植物细胞不能再生来产生植物。植物细胞或组织培养物中的可再生细胞可以是胚、原生质体、分生组织细胞、愈伤组织、花粉、叶、花药、根、根尖、穗丝、花、籽粒、穗、穗轴、外壳或茎。As used herein, the term "plant" includes the whole plant and any progeny, cell, tissue or part of the plant. The class of plants that can be used in the present disclosure can generally be as broad as the class of higher and lower plants suitable for mutagenesis, including angiosperms (monocotyledonous and dicotyledonous), gymnosperms, ferns, and polyps. Cell algae. Thus, "plant" includes both dicotyledonous and monocotyledonous plants. The term "plant part" includes any part of a plant, including, for example, but not limited to: seeds (including mature and immature seeds); plant cuttings; plant cells; plant cell cultures; plant organs (eg, pollen, embryo, flower , fruits, shoots, leaves, roots, stems and explants). A plant tissue or plant organ can be a seed, protoplast, callus, or any other group of plant cells that can be organized into structural or functional units. Plant cell or tissue cultures may be capable of regenerating plants having the physiological and morphological characteristics of the plants from which the cells or tissues were obtained, as well as regenerating plants having substantially the same genotype as the plants. By contrast, some plant cells cannot regenerate to produce plants. The regenerable cells in a plant cell or tissue culture can be embryos, protoplasts, meristem cells, callus, pollen, leaves, anthers, roots, root tips, silks, flowers, kernels, ears, cobs, husk or stem.
如本文所用,术语“转基因”是指已经并入宿主基因组中或能够在宿主细胞中自主复制并且能够引起一个或多个编码序列的表达的DNA区段。示例性转基因将为宿主细胞或从所述宿主细胞再生的植物提供相对于对应的非转化细胞或植物新颖的表型。转基因可通过遗传转化直接引入植物中,或者可从用所述DNA区段转化的任何上一代植物继承。在一些情况下,转基因可以是条形码。在一些情况下,转基因可以是标记物。As used herein, the term "transgene" refers to a DNA segment that has been incorporated into the host genome or that is capable of autonomous replication in a host cell and capable of causing expression of one or more coding sequences. Exemplary transgenes will provide host cells or plants regenerated from such host cells with novel phenotypes relative to corresponding non-transformed cells or plants. Transgenes can be introduced directly into plants by genetic transformation, or can be inherited from any previous generation of plants transformed with the DNA segments. In some cases, the transgene can be a barcode. In some cases, a transgene can be a marker.
如本文所用,转基因生物体通常是指重组生物体,其中通过插入、缺失、取代或其它核苷酸序列操作来修饰生物体的基因组内的所需DNA序列或遗传基因座。As used herein, a transgenic organism generally refers to a recombinant organism in which a desired DNA sequence or genetic locus within the organism's genome is modified by insertion, deletion, substitution, or other manipulation of nucleotide sequences.
如本文所用,术语“转基因植物”是指源自其的任何后代的植物或子代植物,其中所述植物或其子代的DNA含有不是天然存在于同一品系的非转基因植物中的引入的外源性DNA区段。所述转基因植物此外可含有对被转化植物来说天然的序列,但是其中已经改变了“外源性”基因以改变所述基因的表达水平或模式,例如,通过使用一个或多个异源调控或其它元件。As used herein, the term "transgenic plant" refers to a plant or progeny plant derived from any progeny therefrom, wherein the DNA of the plant or progeny contains an introduced extraneous explant that does not naturally occur in a non-transgenic plant of the same line. source DNA segment. The transgenic plant may additionally contain sequences native to the transformed plant, but in which an "exogenous" gene has been altered to alter the level or pattern of expression of the gene, for example, by the use of one or more heterologous regulators or other elements.
载体可以是用作将遗传物质人工携带至细胞中的媒介物的多核苷酸(例如,DNA或RNA),在细胞中它可复制和/或表达。在一些方面,载体是二元载体或Ti质粒。这样的多核苷酸可呈例如质粒、YAC、粘粒、噬菌粒、BAC、病毒或线性DNA(例如,线性PCR产物),或可用于将多核苷酸序列转移至另一个细胞中的任何其它类型的构建体的形式。载体(或其部分)可瞬时地(即,未整合到基因组中)或稳定地(即,整合到基因组中)存在于靶细胞中。在一些方面,载体还可包含选择标记物或报告基因。A vector can be a polynucleotide (eg, DNA or RNA) that serves as a vehicle for artificially carrying genetic material into a cell, where it can be replicated and/or expressed. In some aspects, the vector is a binary vector or a Ti plasmid. Such polynucleotides can be in the form of, for example, plasmids, YACs, cosmids, phagemids, BACs, viruses, or linear DNA (eg, linear PCR products), or any other that can be used to transfer a polynucleotide sequence into another cell Type of construct in the form. The vector (or portion thereof) may be present in the target cell transiently (ie, not integrated into the genome) or stably (ie, integrated into the genome). In some aspects, the vector may also contain a selectable marker or reporter gene.
除非另有说明,否则本文公开的一些方法的实施采用免疫学、生物化学、化学、分子生物学、微生物学、细胞生物学、基因组学和重组DNA的常规技术,所述技术在本领域的技术范围内。参见例如Sambrook和Green,Molecular Cloning:A Laboratory Manual,第4版(2012);系列Current Protocols in Molecular Biology(F.M.Ausubel,等人编辑);系列Methods In Enzymology(Academic Press,Inc.),PCR 2:A Practical Approach(M.J.MacPherson,B.D.Hames和G.R.Taylor编辑(1995));Harlow和Lane,编辑(1988)Antibodies,A Laboratory Manual,and Culture of Animal Cells:A Manual of BasicTechnique and Specialized Applications,第6版(R.I.Freshney,编辑(2010))。Unless otherwise stated, some of the methods disclosed herein are performed using conventional techniques of immunology, biochemistry, chemistry, molecular biology, microbiology, cell biology, genomics, and recombinant DNA, which are within the skill in the art within the range. See, eg, Sambrook and Green, Molecular Cloning: A Laboratory Manual, 4th Ed. (2012); series Current Protocols in Molecular Biology (F.M. Ausubel, et al. eds.); series Methods In Enzymology (Academic Press, Inc.), PCR 2: A Practical Approach (M.J. MacPherson, edited by B.D. Hames and G.R. Taylor (1995)); Harlow and Lane, edited (1988) Antibodies, A Laboratory Manual, and Culture of Animal Cells: A Manual of BasicTechnique and Specialized Applications, 6th ed. ( R.I. Freshney, ed. (2010)).
本公开提供了产生增加量的色胺衍生的物质(如裸盖菇素和脱磷酸裸盖菇素)的经遗传修饰的生物体,以及用于产生所述经遗传修饰的生物体的表达盒、载体、组合物和材料以及方法。本文还提供了利用成簇规律间隔的短回文重复序列(CRISPR)、Argonaut、锌指、TALEN或其它基于核酸酶的技术制造经遗传修饰的生物体的方法和用于产生所述经遗传修饰的生物体的试剂。本文提供的组合物和方法可用于产生具有增加的色胺衍生的物质产生的真菌或植物。本文提供的组合物可用于各种用途,包括但不限于治疗性用途、预防性用途、姑息治疗用途和娱乐性用途。The present disclosure provides genetically modified organisms that produce increased amounts of tryptamine-derived substances, such as psilocybin and psilocybin dephosphorylated, and expression cassettes for producing the genetically modified organisms , carriers, compositions and materials and methods. Also provided herein are methods for making genetically modified organisms using Clustered Regularly Interspaced Short Palindromic Repeats (CRISPR), Argonaut, Zinc Finger, TALEN or other nuclease-based technologies and methods for producing the genetically modified organisms biological reagents. The compositions and methods provided herein can be used to produce fungi or plants with increased production of tryptamine-derived substances. The compositions provided herein can be used for a variety of uses including, but not limited to, therapeutic, prophylactic, palliative, and recreational uses.
裸盖菇属蘑菇含有痕量的裸盖菇素(0.1–1.7%)(表1)。由于在蘑菇中的稀有性和昂贵的合成生产过程,裸盖菇素的生产是昂贵的。裸盖菇素的研究价格是每克7,000美元至10,000美元。Psilocybe genus mushrooms contain trace amounts of psilocybin (0.1–1.7%) (Table 1). The production of psilocybin is expensive due to its rarity in mushrooms and the expensive synthetic production process. The research price for psilocybin is $7,000 to $10,000 per gram.
表1.裸盖菇素在裸盖菇属蘑菇中以痕量(0.1-1.7%)存在。Table 1. Psilocybin is present in trace amounts (0.1-1.7%) in psilocybin mushrooms.
平均含量并且可能在不同地区因环境条件而异Average content and may vary in different regions due to environmental conditions
裸盖菇素的结构已经已知了60年,但直到最近才鉴定了裸盖菇素生物合成酶。这促进了现在增强蘑菇内的这种精神药物化合物的产生的机会,以推进对裸盖菇素的医疗用途的研究。可通过现有技术植物CRISPR工程化平台提高裸盖菇素生产的产率、效力和功效。证明蘑菇中裸盖菇素产生从1%至10%的10倍增加(菌丝体干质量%)将对所述行业具有重要价值。The structure of psilocybin has been known for 60 years, but only recently has the psilocybin biosynthesis enzyme been identified. This promotes the opportunity now to enhance the production of this psychoactive compound within mushrooms to advance research into the medical use of psilocybin. Yield, potency and efficacy of psilocybin production can be enhanced by prior art plant CRISPR engineering platforms. Demonstrating a 10-fold increase in psilocybin production from 1% to 10% in mushrooms (% by dry mass of mycelium) would be of great value to the industry.
经遗传修饰的生物体Genetically Modified Organisms
本文提供了用于修饰生物体中的生物合成途径以增加所述生物体中裸盖菇素和脱磷酸裸盖菇素的产生的方法和组合物。在本文提供的实施方案中,使用基因编辑,增加早期、中间和/或后期前体化合物如色胺和色胺衍生物(如二甲基色胺)的产生以产生所需的最终产物如裸盖菇素和脱磷酸裸盖菇素。Provided herein are methods and compositions for modifying biosynthetic pathways in an organism to increase the production of psilocybin and psilocybin dephosphorylated in the organism. In the embodiments provided herein, gene editing is used to increase the production of early, intermediate and/or late precursor compounds such as tryptamine and tryptamine derivatives (eg dimethyltryptamine) to produce the desired end product such as naked psilocybin and dephosphorylated psilocybin.
此外,提供了用于使用基因编辑关闭色氨酸消耗的特异性途径,以产生具有较高色胺和/或色胺相关物质如裸盖菇素和脱磷酸裸盖菇素表达水平的经遗传修饰的生物体的方法和组合物。In addition, specific pathways for turning off tryptophan depletion using gene editing are provided to generate genetically engineered genes with higher expression levels of tryptamine and/or tryptamine-related substances such as psilocybin and psilocybin dephosphorylate Methods and compositions of modified organisms.
如本文所述的经遗传修饰的生物体可以是植物、动物、细菌、酵母或真菌。在一些情况下,真菌是蘑菇。裸盖菇属、锥盖伞属、裸伞属、斑褶菇属、光柄菇属和球盖菇属的特定蘑菇产生精神活性色胺衍生的物质(例如如本文所述的裸盖菇素或脱磷酸裸盖菇素),所述色胺衍生的物质的产生通过本文所述的遗传修饰而增强。在一些情况下,如本文所述的经遗传修饰的生物体是选自暗蓝斑褶菇、古巴斑褶菇和白灵侧耳的蘑菇。Genetically modified organisms as described herein can be plants, animals, bacteria, yeast or fungi. In some cases, the fungus is a mushroom. Certain mushrooms of the genera Psilocybe, Psilocybe, Psilocybe, Pleurotus, Pleurotus, and Globule produce psychoactive tryptamine-derived substances (eg, psilocybin as described herein) or dephosphorylated psilocybin), the production of the tryptamine-derived species is enhanced by the genetic modifications described herein. In some cases, the genetically modified organism as described herein is a mushroom selected from the group consisting of Pleurotus coleus, Pleurotus cuban, and Pleurotus pelvis.
在本文所述的实施方案中是增强L-色氨酸或4-羟基-L-色氨酸转化为色胺的经遗传修饰的细胞或生物体。在一些情况下,经遗传修饰的细胞或生物体包含遗传修饰,所述遗传修饰抑制或最小化4-羟基-L-色氨酸或色氨酸的替代消耗途径,从而增强色胺和任选的色胺下游衍生物如裸盖菇素和脱磷酸裸盖菇素的形成。在一些情况下,这种增强是通过引入或上调与色氨酸脱羧酶PsiD的表达或活性相关的基因来实现的。In the embodiments described herein are genetically modified cells or organisms that enhance the conversion of L-tryptophan or 4-hydroxy-L-tryptophan to tryptamine. In some cases, the genetically modified cell or organism comprises a genetic modification that inhibits or minimizes alternative consumption pathways of 4-hydroxy-L-tryptophan or tryptophan, thereby enhancing tryptophan and optionally formation of downstream derivatives of tryptamine such as psilocybin and dephosphorylated psilocybin. In some cases, this enhancement is achieved by introducing or up-regulating a gene associated with the expression or activity of the tryptophan decarboxylase PsiD.
在一些情况下是经遗传修饰的细胞或生物体,其中通过引入或上调与色胺转化为4-羟色胺相关的基因(例如P450单加氧酶PsiH)来实现脱磷酸裸盖菇素或裸盖菇素的产生增强。在一些情况下,是通过上调与色胺、色氨酸或4-羟色胺转化为去甲芽孢杆菌素相关的基因而具有增强的去甲芽孢杆菌素产生的经遗传修饰的细胞或生物体。在一些情况下,这种上调是通过上调或引入4-羟色胺激酶PsiK、通过修饰与所述基因相关的启动子或增强子序列或将所述基因敲入所述细胞或生物体中来实现的。In some cases is a genetically modified cell or organism in which dephosphorylation of psilocybin or naked cap is achieved by introducing or up-regulating a gene involved in the conversion of tryptamine to serotonin (eg P450 monooxygenase PsiH) Mushroom production is enhanced. In some cases, it is a genetically modified cell or organism that has enhanced norbacin production by upregulating genes associated with the conversion of tryptamine, tryptophan, or serotonin to norbacin. In some cases, the up-regulation is achieved by up-regulation or introduction of the serotonin kinase PsiK, by modifying a promoter or enhancer sequence associated with the gene, or by knocking the gene into the cell or organism .
在一些情况下是经遗传修饰的细胞或生物体,其中通过引入或上调与去甲芽孢杆菌素转化为芽孢杆菌素(baeocystin)相关的基因或通过增加芽孢杆菌素的产生来实现脱磷酸裸盖菇素或裸盖菇素的产生增强。在一些情况下,通过修饰与所述基因相关的启动子或增强子序列或将所述基因敲入所述细胞或生物体中来增加去甲芽孢杆菌素甲基转移酶基因的合成而实现所述上调。In some cases is a genetically modified cell or organism in which dephosphorylated naked caps are achieved by introducing or up-regulating genes involved in the conversion of norbacillin to baeocystin or by increasing baeocystin production Increased production of mushroom or psilocybin. In some cases, the desired effect is achieved by modifying a promoter or enhancer sequence associated with the gene or by knocking the gene into the cell or organism to increase the synthesis of the nobacillin methyltransferase gene above mentioned.
在某些实施方案中,如本文所述的色氨酸脱羧酶基因可以是PsiD(表3中提供了代表性mRNA序列)。在一些情况下,编码色氨酸脱羧酶的基因可包含与SEQ ID NO:1的约50%、60%、70%、80%、90%、95%、96%、97%、98%、99%或高达约100%序列同一性。酶PsiD可以是49.6kDa的酶并且属于非PLP依赖性磷脂酰丝氨酸脱羧酶家族。在某些实施方案中,通过对所述基因中的或与所述基因相关的启动子或增强子序列进行遗传编辑来上调细胞或生物体中的PsiD。在某些实施方案中,通过使用本文所述的基因编辑技术将PsiD基因引入经遗传修饰的细胞或生物体中来在所述细胞或生物体中上调或合成PsiD。In certain embodiments, a tryptophan decarboxylase gene as described herein can be PsiD (representative mRNA sequences are provided in Table 3). In some cases, the gene encoding tryptophan decarboxylase may comprise about 50%, 60%, 70%, 80%, 90%, 95%, 96%, 97%, 98%, 99% or up to about 100% sequence identity. The enzyme PsiD may be a 49.6 kDa enzyme and belongs to the family of PLP-independent phosphatidylserine decarboxylases. In certain embodiments, PsiD in a cell or organism is up-regulated by genetic editing of a promoter or enhancer sequence in or associated with the gene. In certain embodiments, PsiD is up-regulated or synthesized in a genetically modified cell or organism by introducing the PsiD gene into the cell or organism using the gene editing techniques described herein.
在一些情况下,本文所述的经遗传修饰的细胞或生物体包含P450单加氧酶PsiH基因表达的上调(表3中提供了代表性mRNA序列)。在一些情况下,编码单加氧酶的基因可包含与SEQ ID NO:2的约50%、60%、70%、80%、90%、95%、96%、97%、98%、99%或高达约100%序列同一性。在某些实施方案中,通过对所述基因中的或与所述基因相关的启动子或增强子序列进行遗传编辑来上调细胞或生物体中的PsiH。在某些实施方案中,通过使用本文所述的基因编辑技术将PsiH基因引入经遗传修饰的细胞或生物体中来在所述细胞或生物体中上调或合成PsiH。In some cases, the genetically modified cells or organisms described herein comprise upregulation of P450 monooxygenase PsiH gene expression (representative mRNA sequences are provided in Table 3). In some cases, the gene encoding a monooxygenase may comprise about 50%, 60%, 70%, 80%, 90%, 95%, 96%, 97%, 98%, 99% identical to SEQ ID NO:2 % or up to about 100% sequence identity. In certain embodiments, PsiH in a cell or organism is up-regulated by genetic editing of a promoter or enhancer sequence in or associated with the gene. In certain embodiments, PsiH is up-regulated or synthesized in a genetically modified cell or organism by introducing the PsiH gene into the cell or organism using the gene editing techniques described herein.
在一些情况下,本文所述的经遗传修饰的细胞或生物体包含4-羟色胺激酶PsiK基因表达的上调(表3中提供了代表性mRNA序列)。在一些情况下,编码4-羟色胺激酶的基因可包含与SEQ ID NO:3的约50%、60%、70%、80%、90%、95%、96%、97%、98%、99%或高达约100%序列同一性。在某些实施方案中,通过对所述基因中的或与所述基因相关的启动子或增强子序列进行遗传编辑来上调细胞或生物体中的PsiK。在某些实施方案中,通过使用本文所述的基因编辑技术将PsiK基因,例如Seq ID NO:3的基因引入经遗传修饰的细胞或生物体中来在所述细胞或生物体中上调或合成PsiK。In some cases, the genetically modified cells or organisms described herein comprise upregulation of serotonin kinase PsiK gene expression (representative mRNA sequences are provided in Table 3). In some cases, the gene encoding serotonin kinase can comprise about 50%, 60%, 70%, 80%, 90%, 95%, 96%, 97%, 98%, 99% identical to SEQ ID NO:3 % or up to about 100% sequence identity. In certain embodiments, PsiK in a cell or organism is up-regulated by genetic editing of a promoter or enhancer sequence in or associated with the gene. In certain embodiments, a PsiK gene, eg, the gene of Seq ID NO: 3, is up-regulated or synthesized in a genetically modified cell or organism by using the gene editing techniques described herein to introduce the gene into the cell or organism PsiK.
在一些情况下,本文所述的经遗传修饰的细胞或生物体包含去甲芽孢杆菌素甲基转移酶PsiM基因表达的上调(表3中提供了代表性mRNA序列)。在一些情况下,编码所述甲基转移酶的基因可包含与SEQ ID NO:4中的任一个的约50%、60%、70%、80%、90%、95%、96%、97%、98%、99%或高达约100%序列同一性。在某些实施方案中,通过对所述基因中的或与所述基因相关的启动子或增强子序列进行遗传编辑来上调细胞或生物体中的PsiM。在某些实施方案中,通过使用本文所述的基因编辑技术将PsiM基因,例如Seq ID NO:4的基因引入经遗传修饰的细胞或生物体中来在所述细胞或生物体中上调或合成PsiM。在某些情况下,将具有氨基序列GVDIGTGAS的包含罗斯曼折叠的I类甲基转移酶基因或其衍生物引入所述细胞或生物体中以增加裸盖菇素产生。In some cases, the genetically modified cells or organisms described herein comprise up-regulation of the expression of the nobacillin methyltransferase PsiM gene (representative mRNA sequences are provided in Table 3). In some cases, the gene encoding the methyltransferase can comprise about 50%, 60%, 70%, 80%, 90%, 95%, 96%, 97% of any of SEQ ID NO:4 %, 98%, 99% or up to about 100% sequence identity. In certain embodiments, PsiM in a cell or organism is up-regulated by genetic editing of a promoter or enhancer sequence in or associated with the gene. In certain embodiments, a PsiM gene, eg, the gene of Seq ID NO:4, is up-regulated or synthesized in a genetically modified cell or organism by using the gene editing techniques described herein to introduce the gene into the cell or organism PsiM. In certain instances, a Rothmann fold-containing class I methyltransferase gene or derivative thereof having the amino sequence GVDIGTGAS is introduced into the cell or organism to increase psilocybin production.
可在本文所述的生物体和细胞中修饰影响真菌或其它生物体中所产生的裸盖菇素的产生和累积的其它推定转录调控因子和转运蛋白。在一些情况下,推定转录调控因子可促进本文所述的甲基转移酶、羟化酶、单加氧酶、激酶或脱羧酶(例如PsiD、PsiH、PsiK或PsiM)的转录或翻译。在一些情况下,推定转录调控因子可促进下调酶,如本文所述的甲基转移酶、羟化酶、单加氧酶、激酶或脱羧酶(例如PsiD、PsiH、PsiK或PsiM)的转录或翻译。Other putative transcriptional regulators and transporters that affect the production and accumulation of psilocybin produced in fungi or other organisms can be modified in the organisms and cells described herein. In some cases, a putative transcriptional regulator can promote transcription or translation of a methyltransferase, hydroxylase, monooxygenase, kinase, or decarboxylase (eg, PsiD, PsiH, PsiK, or PsiM) described herein. In some cases, putative transcriptional regulators can promote transcription of down-regulated enzymes, such as methyltransferases, hydroxylases, monooxygenases, kinases, or decarboxylases (eg, PsiD, PsiH, PsiK, or PsiM) described herein, or translate.
在某些实施方案中,本文公开的遗传修饰技术可用于通过对基因中的或与所述基因相关的启动子或增强子序列进行遗传编辑或通过引入一种或多种所述基因或其同源物的额外拷贝来增强易化子家族转运蛋白(PsiT1和PsiT2,或螺旋-环-螺旋(HLH)-结构域转录调控因子(PsiR)的表达。它还可在确保所合成的裸盖菇素在真菌和其它生物体中正确地转运和定位方面发挥作用。在某些实施方案中,通过对基因中的或与所述基因相关的启动子或增强子序列进行遗传编辑来上调细胞或生物体中的PsiR、PsiT1或PsiT2。在某些实施方案中,通过使用本文所述的基因编辑技术将PsiR、PsiT1或PsiT2基因,例如Seq ID NO:5的基因引入经遗传修饰的细胞或生物体中来在所述细胞或生物体中上调或合成PsiR、PsiT1或PsiT2。In certain embodiments, the genetic modification techniques disclosed herein can be used by genetically editing promoter or enhancer sequences in or associated with a gene or by introducing one or more of the genes or their equivalents. additional copies of the source to enhance the expression of the facilitator family transporters (PsiT1 and PsiT2, or the helix-loop-helix (HLH)-domain transcriptional regulator (PsiR). In fungi and other organisms, proteins play a role in their correct transport and localization. In certain embodiments, the upregulation of cells or organisms is accomplished by genetic editing of promoter or enhancer sequences in or associated with the gene. PsiR, PsiT1 or PsiT2 in the body. In certain embodiments, a PsiR, PsiT1 or PsiT2 gene, such as the gene of Seq ID NO: 5, is introduced into a genetically modified cell or organism by using the gene editing techniques described herein Zhonglai upregulates or synthesizes PsiR, PsiT1 or PsiT2 in the cell or organism.
编码PsiT2的基因的代表性序列在表3中列出。在一些情况下,编码PsiT2的基因可包含与SEQ ID NO:5中的任一个的约50%、60%、70%、80%、90%、95%、96%、97%、98%、99%或高达约100序列同一性。A representative sequence of the gene encoding PsiT2 is listed in Table 3. In some cases, the gene encoding PsiT2 may comprise about 50%, 60%, 70%, 80%, 90%, 95%, 96%, 97%, 98%, 80%, 90%, 95%, 96%, 97%, 98%, 99% or up to about 100 sequence identity.
上述基因可通过本文中所公开的遗传修饰技术进行修饰,以增加参与裸盖菇素生物合成途径的酶、推定调控因子和推定转运蛋白的产生,或在本文所述的经遗传修饰的细胞或生物体中从头产生此类酶、调控因子和转运蛋白。例如,可增加沿裸盖菇素生物合成途径的特异性酶的表达水平以增加色胺、4-羟基色胺、芽孢杆菌素、去甲芽孢杆菌素和裸盖菇素中的一者或多者的产生。在一些情况下,遗传修饰位于本文所述的一种或多种基因的或与所述一种或多种基因相关的启动子或增强子区域中。The above genes can be modified by the genetic modification techniques disclosed herein to increase the production of enzymes, putative regulators and putative transporters involved in the psilocybin biosynthetic pathway, or in the genetically modified cells described herein or Such enzymes, regulators and transporters are produced de novo in the organism. For example, the expression levels of specific enzymes along the psilocybin biosynthetic pathway can be increased to increase one or more of tryptamine, 4-hydroxytryptamine, bacillus, norbacillus, and psilocybin generation of. In some cases, the genetic modification is in a promoter or enhancer region of or associated with one or more genes described herein.
在某些实施方案中,通过本文所述的遗传修饰技术对与还利用色氨酸和/或4-羟基-L-色氨酸的途径相关的基因进行修饰以下调或敲除这些基因,从而减少这些途径的色氨酸消耗和/或4-羟基-L-色氨酸消耗。下调或敲除的基因可包括例如吲哚胺2,3-双加氧酶(IDO)、色氨酸2,3-双加氧酶(TDO)和TrpM。TrpM是对色氨酸具有单甲基化和二甲基化活性、但不是裸盖菇素生物合成途径的一部分的甲基转移酶。本文所述的经遗传修饰的生物体或细胞中诸如IDO、TDO、TrpM的基因的下调或敲除导致色氨酸和/或4-羟基-L-色氨酸用于裸盖菇素生产的可用性增加。In certain embodiments, genes associated with pathways that also utilize tryptophan and/or 4-hydroxy-L-tryptophan are modified to downregulate or knock out these genes by the genetic modification techniques described herein, thereby Reduce tryptophan consumption and/or 4-hydroxy-L-tryptophan consumption by these pathways. Genes down-regulated or knocked out can include, for example,
在某些实施方案中是包含修饰的经遗传修饰的细胞或生物体,所述修饰导致色氨酸和/或4-羟基-L-色氨酸的产生增加。这些修饰包括编码磷酸-2-脱氢-3-脱氧庚酸醛缩酶、3-脱氢奎尼酸合酶、3-脱氢奎尼酸脱水酶、莽草酸脱氢酶、3-磷酸莽草酸1-羧基乙烯基转移酶、莽草酸激酶1、莽草酸激酶2、分支酸合酶、色氨酸合酶α链、色氨酸合酶β链、邻氨基苯甲酸磷酸核糖基转移酶或邻氨基苯甲酸合酶组分的基因的上调。这些基因的上调是通过修饰基因中的或与所述基因相关的启动子或增强子或通过增加所述生物体或细胞中所述基因的拷贝数来增加所述基因的产生而实现的。In certain embodiments are genetically modified cells or organisms comprising modifications that result in increased production of tryptophan and/or 4-hydroxy-L-tryptophan. These modifications include encoding phospho-2-dehydro-3-deoxyheptanoate aldolase, 3-dehydroquinate synthase, 3-dehydroquinate dehydratase, shikimate dehydrogenase, 3-phosphoshikimate Oxalate 1-carboxyvinyltransferase,
通过增加这些酶的表达,产生更多的底物色氨酸和/或4-羟基-L-色氨酸,从而增加裸盖菇素和/或脱磷酸裸盖菇素产生。By increasing the expression of these enzymes, more substrate tryptophan and/or 4-hydroxy-L-tryptophan are produced, thereby increasing psilocybin and/or dephosphorylated psilocybin production.
本文提供了用于表征裸盖菇素生物合成途径和酶的方法和组合物。在本文提供的实施方案中,通过对三种不同的裸盖菇素阳性(PS+)蘑菇同核体基因组进行测序来鉴定候选裸盖菇素基因:暗蓝裸盖菇(Ps.cyanescens)、暗蓝斑褶菇(Pa.(=灰斑褶菇属(Copelandia))cyanescens)和变色龙裸伞(Gy.Dilepis)。在某些实施方案中,五种基因全部簇集在PS+基因组中:色氨酸脱羧酶(PsiD);裸盖菇素相关的N-甲基转移酶(PsiM);裸盖菇素相关的羟化酶(PsiH);裸盖菇素相关的磷酸转移酶(PsiK);裸盖菇素相关的转运蛋白(PsiT)。在某些实施方案中,PsiD(反应中的第一个关键步骤且唯一一个不产生药物预定化合物的步骤)对产生色氨酸的色胺具有特异性脱羧酶活性。在某些实施方案中,簇之间的基因复制涉及用于遗传修饰的替代或网状途径。Provided herein are methods and compositions for characterizing psilocybin biosynthetic pathways and enzymes. In the embodiments provided herein, candidate psilocybin genes were identified by sequencing three different psilocybin-positive (PS+ ) mushroom homokaryotic genomes: Ps. cyanescens, Ps. Pa. (= Copelandia) cyanescens and Gy. Dilepis. In certain embodiments, all five genes are clustered in the PS+ genome: tryptophan decarboxylase (PsiD); psilocybin-related N-methyltransferase (PsiM); psilocybin-related Hydroxylase (PsiH); psilocybin-related phosphotransferase (PsiK); psilocybin-related transporter (PsiT). In certain embodiments, PsiD (the first critical step in the reaction and the only step that does not produce the drug-predetermined compound) has specific decarboxylase activity on tryptophan-producing tryptophan. In certain embodiments, gene duplication between clusters involves alternative or reticular pathways for genetic modification.
在本文所述的实施方案中,PS+簇内的基因的编码序列已从数种蘑菇中鉴定并如本文所提供。在某些实施方案中,还存在关于这些基因的内含子或外显子结构的信息(表2中提供了基因的代表性列表)。In the embodiments described herein, coding sequences for genes within the PS+ cluster have been identified from several mushrooms and are provided herein. In certain embodiments, information about the intron or exon structure of these genes is also present (a representative list of genes is provided in Table 2).
表2:古巴裸盖菇和暗蓝裸盖菇中裸盖菇素生物合成基因的长度和内含子数量。如果一个单元格中存在两个值,则第一个值是指古巴裸盖菇的相应基因,并且第二个值是指暗蓝裸盖菇的相应基因。使用Augustus算法预测暗蓝裸盖菇基因和古巴裸盖菇的PsiR、PsiT1和PsiT2的值。Table 2: Length and number of introns of psilocybin biosynthesis genes in Psilocybe cuban and Psilocybe dulcis. If there are two values in a cell, the first value refers to the corresponding gene for Psilocybe cuban, and the second value refers to the corresponding gene for Psilocybe dwarf. The Augustus algorithm was used to predict the values of PsiR, PsiT1 and PsiT2 for the Psilocybe dulcis gene and Psilocybe cuban.
表3:在本文所述的经遗传修饰的细胞或生物体中表达增强的基因的基因序列。通过修饰基因中的或与基因相关的启动子或增强子或通过在所述细胞或生物体中引入基因拷贝来增强表达。Table 3: Gene sequences of genes whose expression is enhanced in the genetically modified cells or organisms described herein. Expression is enhanced by modifying a promoter or enhancer in or associated with a gene or by introducing a copy of the gene in the cell or organism.
在一些情况下,使用本文所述的任何核酸递送平台,真菌或任何其它生物体(包括但不限于细胞)的基因组破坏的效率可导致如通过核酸或蛋白质分析测量的基因或其部分的约20%、25%、30%、35%、40%、45%、50%、55%、60%、65%、70%、75%、80%、85%、90%、91%,92%、93%、94%、95%、96%、97%、98%、99%、99.5%、99.9%或高达约100%破坏。In some cases, using any of the nucleic acid delivery platforms described herein, the efficiency of genome disruption of a fungus or any other organism (including but not limited to cells) can result in about 20 percent of a gene or portion thereof as measured by nucleic acid or protein analysis. %, 25%, 30%, 35%, 40%, 45%, 50%, 55%, 60%, 65%, 70%, 75%, 80%, 85%, 90%, 91%, 92%, 93%, 94%, 95%, 96%, 97%, 98%, 99%, 99.5%, 99.9% or up to about 100% failure.
在一些情况下,经遗传修饰的真菌和其它生物体包含与没有遗传修饰的可比对照相比,通过真菌的干重测量的多约10%、20%、25%、30%、35%、40%、45%、50%、55%、60%、65%、70%、75%、80%、85%、90%、91%、92%、93%、94%、95%、96%、97%、98%、99%、100%、125%、150%、175%、200%和高达400%的式I-IV中任一者的化合物。In some cases, the genetically modified fungi and other organisms comprise about 10%, 20%, 25%, 30%, 35%, 40% more as measured by dry weight of the fungus compared to a comparable control without the genetic modification %, 45%, 50%, 55%, 60%, 65%, 70%, 75%, 80%, 85%, 90%, 91%, 92%, 93%, 94%, 95%, 96%, 97%, 98%, 99%, 100%, 125%, 150%, 175%, 200% and up to 400% of the compounds of any of formulae I-IV.
在一些情况下,经遗传修饰的真菌和其它生物体包含与没有遗传修饰的可比对照相比,通过真菌的干重测量的多约10%、20%、25%、30%、35%、40%、45%、50%、55%、60%、65%、70%、75%、80%、85%、90%、91%、92%、93%、94%、95%、96%、97%、98%、99%、100%、125%、150%、175%、200%和高达400%的二甲基色胺(DMT)。In some cases, the genetically modified fungi and other organisms comprise about 10%, 20%, 25%, 30%, 35%, 40% more as measured by dry weight of the fungus compared to a comparable control without the genetic modification %, 45%, 50%, 55%, 60%, 65%, 70%, 75%, 80%, 85%, 90%, 91%, 92%, 93%, 94%, 95%, 96%, 97%, 98%, 99%, 100%, 125%, 150%, 175%, 200% and up to 400% Dimethyltryptamine (DMT).
在一些情况下,经遗传修饰的真菌和其它生物体包含与没有遗传修饰的可比对照相比,通过真菌的干重测量的多约10%、20%、25%、30%、35%、40%、45%、50%、55%、60%、65%、70%、75%、80%、85%、90%、91%、92%、93%、94%、95%、96%、97%、98%、99%、100%、125%、150%、175%、200%和高达400%的裸盖菇素。In some cases, the genetically modified fungi and other organisms comprise about 10%, 20%, 25%, 30%, 35%, 40% more as measured by dry weight of the fungus compared to a comparable control without the genetic modification %, 45%, 50%, 55%, 60%, 65%, 70%, 75%, 80%, 85%, 90%, 91%, 92%, 93%, 94%, 95%, 96%, 97%, 98%, 99%, 100%, 125%, 150%, 175%, 200% and up to 400% psilocybin.
在一些情况下,经遗传修饰的真菌和其它生物体包含与没有遗传修饰的可比对照相比,通过真菌的干重测量的多约10%、20%、25%、30%、35%、40%、45%、50%、55%、60%、65%、70%、75%、80%、85%、90%、91%、92%、93%、94%、95%、96%、97%、98%、99%、100%、125%、150%、175%、200%和高达400%的脱磷酸裸盖菇素。In some cases, the genetically modified fungi and other organisms comprise about 10%, 20%, 25%, 30%, 35%, 40% more as measured by dry weight of the fungus compared to a comparable control without the genetic modification %, 45%, 50%, 55%, 60%, 65%, 70%, 75%, 80%, 85%, 90%, 91%, 92%, 93%, 94%, 95%, 96%, 97%, 98%, 99%, 100%, 125%, 150%, 175%, 200% and up to 400% dephosphorylated psilocybin.
可使用各种方法来鉴定用于裸盖菇素和/或脱磷酸裸盖菇素生物合成途径中的基因编辑的潜在靶标。在一些情况下,可使用以下中的任一者:生物信息学、gRNA设计、CRISPR试剂构建、植物转化、植物再生和/或基因分型。生物信息学可包括基因作图、基因比对和拷贝数分析以及基因注释。gRNA设计可包括gRNA分组,以基于大麻基因组内的靶基因特异性和脱靶来设计用于预期功能、等级和选择的引导簇。CRISPR试剂构建可包括产生可感染的AGRO试剂,以共同递送已进行了大麻密码子优化的Cas9和gRNA。植物转化和再生可包括用CRISPR AGRO(例如愈伤组织)感染植物组织,分离大麻原生质体和转化RNP试剂的技术,和/或开发从转化组织获得生长中小植株的技术。基因分型可包括分离植物DNA和分析靶序列。功能分析可包括分析植物组织中的大麻素含量和定量相关的大麻素。Various methods can be used to identify potential targets for gene editing in the psilocybin and/or dephosphorylated psilocybin biosynthetic pathways. In some cases, any of the following: bioinformatics, gRNA design, CRISPR reagent construction, plant transformation, plant regeneration, and/or genotyping can be used. Bioinformatics can include gene mapping, gene alignment and copy number analysis, and gene annotation. gRNA design can include grouping of gRNAs to design guide clusters for intended function, rank and selection based on target gene specificity and off-target within the cannabis genome. CRISPR reagent construction can include the generation of infectious AGRO reagents to co-deliver cannabinoid codon-optimized Cas9 and gRNA. Plant transformation and regeneration can include infecting plant tissue with CRISPR AGRO (eg, callus), techniques for isolating cannabis protoplasts and transforming RNP reagents, and/or developing techniques for obtaining growing plantlets from transformed tissue. Genotyping can include isolating plant DNA and analyzing target sequences. Functional analysis may include analysis of cannabinoid content in plant tissue and quantification of related cannabinoids.
上文公开的不同的遗传修饰方法可用于其它生物体,如不同的植物、大肠杆菌和其它合适的细菌或酵母,以产生裸盖菇素和/或脱磷酸裸盖菇素的最终产物。在所公开的遗传工程化的真菌和其它生物体中,裸盖菇素和/或脱磷酸裸盖菇素的量与没有这种公开的遗传修饰的可比对照真菌或生物体相比增加约5%、10%、15%、20%、25%、30%、35%、40%、45%、50%、55%、60%、65%、70%、75%、80%、85%、90%、95%、100%、125%、150%、175%、200%、300%或高达400%。The various genetic modification methods disclosed above can be used in other organisms, such as various plants, E. coli and other suitable bacteria or yeast, to produce psilocybin and/or dephosphorylated psilocybin final products. In the disclosed genetically engineered fungi and other organisms, the amount of psilocybin and/or psilocybin dephosphorylate is increased by about 5 compared to a comparable control fungus or organism without such disclosed genetic modification %, 10%, 15%, 20%, 25%, 30%, 35%, 40%, 45%, 50%, 55%, 60%, 65%, 70%, 75%, 80%, 85%, 90%, 95%, 100%, 125%, 150%, 175%, 200%, 300% or up to 400%.
遗传工程化genetic engineering
本文提供的可以是基因组工程化系统。基因组工程化系统可包括以下中的任一者:成簇规律间隔的短回文重复序列(CRISPR)酶、转录激活因子样效应物(TALE)-核酸酶、基于转座子的核酸酶、锌指核酸酶、大范围核酸酶、argonaute或Mega-TAL。在一些方面,基因组编辑系统可利用包含DNA、RNA或它们的组合的引导多核酸。在一些情况下,引导可以是引导DNA或引导RNA。Provided herein can be a genome engineered system. The genome engineering system can include any of the following: Clustered Regularly Interspaced Short Palindromic Repeats (CRISPR) enzymes, Transcription Activator-Like Effector (TALE)-nucleases, transposon-based nucleases, zinc Refers to nuclease, meganuclease, argonaute or Mega-TAL. In some aspects, genome editing systems can utilize guide polynucleic acids comprising DNA, RNA, or combinations thereof. In some cases, the guide can be guide DNA or guide RNA.
I.成簇规律间隔的短回文重复序列(CRISPR)I. Clustered Regularly Interspaced Short Palindromic Repeats (CRISPR)
在一些情况下,可使用CRISPR系统或其部分进行遗传工程化。CRISPR系统可以是包含引导多核苷酸或编码所述引导多核苷酸的核酸和CRISPR酶或编码所述CRISPR酶的核酸的多组分系统。CRISPR系统还可包含对CRISPR组分或CRISPR组分中的任一者的任何部分的任何修饰。In some cases, the CRISPR system or portion thereof can be used for genetic engineering. The CRISPR system may be a multi-component system comprising a guide polynucleotide or nucleic acid encoding the guide polynucleotide and a CRISPR enzyme or nucleic acid encoding the CRISPR enzyme. The CRISPR system may also comprise any modification to the CRISPR component or any portion of any of the CRISPR components.
本文所述的方法可利用CRISPR系统。存在至少五种类型的CRISPR系统,其全部并入引导RNA和Cas蛋白和编码多核苷酸。CRISPR系统的一般机制和最新进展在Cong,L.等人,“Multiplex genome engineering using CRISPR systems,”Science,339(6121):819-823(2013);Fu,Y.等人,“High-frequency off-target mutagenesis induced by CRISPR-Casnucleases in human cells,”Nature Biotechnology,31,822–826(2013);Chu,VT等人“Increasing the efficiency of homology-directed repair for CRISPR-Cas9-induced precise gene editing in mammalian cells,”Nature Biotechnology 33,543–548(2015);Shmakov,S.等人,“Discovery and functional characterization ofdiverse Class 2CRISPR-Cas systems,”Molecular Cell,60,1-13(2015);Makarova,KS等人,“An updated evolutionary classification of CRISPR-Cas systems,”,NatureReviews Microbiology,13,1-15(2015)中进行了论述。靶DNA的位点特异性裂解在通过1)引导RNA与靶DNA(也称为原型间隔区)之间的碱基配对互补性和2)靶DNA中称为原型间隔区相邻基序(PAM)的短基序确定的位置处发生。PAM可以是规范PAM或非规范PAM。例如,工程化的细胞(如植物细胞)可使用CRISPR系统,例如II型CRISPR系统产生。本文公开的方法中使用的Cas酶可以是催化DNA裂解的Cas9。源自酿脓链球菌的Cas9或任何密切相关的Cas9的酶促作用可在靶位点序列处产生双链断裂,所述靶位点序列与引导序列的约20个核苷酸杂交并且在靶序列的约20个核苷酸之后具有原型间隔区相邻基序(PAM)。在一些方面,可杂交少于20个核苷酸。在一些方面,可杂交多于20个核苷酸。本文提供的可以是在基因组上破坏THCA合酶的活性,包括将包含至少一种核定位信号的至少一种RNA引导的核酸内切酶或编码包含至少一种核定位信号的至少一种RNA引导的核酸内切酶的核酸、编码至少一种引导RNA的至少一种引导核酸引入大麻和/或火麻植物或其细胞中。在一些方面,可培养经修饰的植物或其部分。The methods described herein can utilize the CRISPR system. There are at least five types of CRISPR systems, all of which incorporate guide RNAs and Cas proteins and encoding polynucleotides. The general mechanism and recent progress of CRISPR systems are in Cong, L. et al., "Multiplex genome engineering using CRISPR systems," Science, 339(6121):819-823 (2013); Fu, Y. et al., "High-frequency off-target mutagenesis induced by CRISPR-Casnucleases in human cells,"Nature Biotechnology,31,822–826(2013);Chu,VT et al."Increasing the efficiency of homology-directed repair for CRISPR-Cas9-induced precise gene editing in mammalian cells , "Nature Biotechnology 33, 543–548 (2015); Shmakov, S. et al., "Discovery and functional characterization of diverse Class 2CRISPR-Cas systems," Molecular Cell, 60, 1-13 (2015); Makarova, KS et al., " Discussed in An updated evolutionary classification of CRISPR-Cas systems,", Nature Reviews Microbiology, 13, 1-15 (2015). Site-specific cleavage of target DNA occurs through 1) base-pairing complementarity between guide RNA and target DNA (also known as protospacer) and 2) a protospacer adjacent motif (PAM) in the target DNA ) at the position determined by the short motif. PAM can be canonical PAM or non-canonical PAM. For example, engineered cells (eg, plant cells) can be generated using a CRISPR system, eg, a Type II CRISPR system. The Cas enzyme used in the methods disclosed herein can be Cas9, which catalyzes DNA cleavage. The enzymatic action of Cas9 derived from S. pyogenes or any closely related Cas9 can create a double-strand break at the target site sequence that hybridizes to about 20 nucleotides of the leader sequence and is at the target site. About 20 nucleotides of the sequence are followed by a protospacer adjacent motif (PAM). In some aspects, less than 20 nucleotides can hybridize. In some aspects, more than 20 nucleotides can hybridize. Provided herein can be genomically disrupting THCA synthase activity comprising directing at least one RNA-guided endonuclease comprising at least one nuclear localization signal or encoding at least one RNA comprising at least one nuclear localization signal The nucleic acid of the endonuclease, at least one guide nucleic acid encoding at least one guide RNA is introduced into the cannabis and/or hemp plants or cells thereof. In some aspects, modified plants or parts thereof can be cultivated.
成簇规律间隔的短回文重复序列(CRISPR)酶Clustered regularly interspaced short palindromic repeats (CRISPR) enzymes
CRISPR酶可包含或者可以是Cas酶。在一些方面,编码Cas蛋白或其部分的核酸可用于本文提供的实施方案中。Cas酶的非限制性实例包括Cas1、Cas1B、Cas2、Cas3、Cas4、Cas5、Cas5d、Cas5t、Cas5h、Cas5a、Cas6、Cas7、Cas8、Cas9、Cas10、Csy1、Csy2、Csy3、Csy4、Cse1、Cse2、Cse3、Cse4、Cse5e、Csc1、Csc2、Csa5、Csn1、Csn2、Csm1、Csm2、Csm3、Csm4、Csm5、Csm6、Cmr1、Cmr3、Cmr4、Cmr5、Cmr6、Csb1、Csb2、Csb3、Csx17、Csx14、Csx10、Csx16、CsaX、Csx3、Csx1、Csx1S、Csf1、Csf2、CsO、Csf4、Csd1、Csd2、Cst1、Cst2、Csh1、Csh2、Csa1、Csa2、Csa3、Csa4、Csa5、C2c1、C2c2、C2c3、Cpf1、CARF、DinG、它们的同系物或它们的经修饰型式。在一些情况下,可使用催化性死亡Cas蛋白,例如dCas9。未修饰的CRISPR酶可具有DNA裂解活性,如Cas9。CRISPR酶可指导一条或两条链在靶序列处,如靶序列内和/或靶序列的互补序列内裂解。在一些方面,靶序列的长度是至少约18个核苷酸、至少19个核苷酸、至少20个核苷酸、至少21个核苷酸或至少22个核苷酸。在一些情况下,靶序列的长度是至多17个核苷酸。在一些方面,靶标可选自包含与SEQ ID NO:1至SEQ ID NO:7中的任一个的约50%、60%、70%、80%、90%、95%、96%、97%、98%、99%或高达约100%同源性的序列。The CRISPR enzyme may comprise or be a Cas enzyme. In some aspects, nucleic acids encoding Cas proteins or portions thereof can be used in the embodiments provided herein. Non-limiting examples of Cas enzymes include Cas1, Cas1B, Cas2, Cas3, Cas4, Cas5, Cas5d, Cas5t, Cas5h, Cas5a, Cas6, Cas7, Cas8, Cas9, Cas10, Csy1, Csy2, Csy3, Csy4, Cse1, Cse2, Cse3, Cse4, Cse5e, Csc1, Csc2, Csa5, Csn1, Csn2, Csm1, Csm2, Csm3, Csm4, Csm5, Csm6, Cmr1, Cmr3, Cmr4, Cmr5, Cmr6, Csb1, Csb2, Csb3, Csx17, Csx14, Csx10, Csx16, CsaX, Csx3, Csx1, Csx1S, Csf1, Csf2, CsO, Csf4, Csd1, Csd2, Cst1, Cst2, Csh1, Csh2, Csa1, Csa2, Csa3, Csa4, Csa5, C2c1, C2c2, C2c3, Cpf1, CARF, DinG, their homologs or their modified versions. In some cases, catalytically dead Cas proteins, such as dCas9, can be used. Unmodified CRISPR enzymes can have DNA cleavage activity, such as Cas9. A CRISPR enzyme can direct cleavage of one or both strands at a target sequence, eg, within the target sequence and/or within the complement of the target sequence. In some aspects, the target sequence is at least about 18 nucleotides, at least 19 nucleotides, at least 20 nucleotides, at least 21 nucleotides, or at least 22 nucleotides in length. In some cases, the target sequence is up to 17 nucleotides in length. In some aspects, the target can be selected from the group comprising about 50%, 60%, 70%, 80%, 90%, 95%, 96%, 97% of any one of SEQ ID NO:1 to SEQ ID NO:7 , 98%, 99% or up to about 100% homologous sequences.
在一些方面,靶序列可存在于基因的内含子或外显子内。在一些情况下,CRISPR系统可靶向参与大麻素生物合成途径的基因的外显子。例如,CRISPR酶可指导一条或两条链在距靶序列的第一个或最后一个核苷酸1、2、3、4、5、6、7、8、9、10、15、20、25、50、100、200、500个或更多个碱基对内或约1、2、3、4、5、6、7、8、9、10、15、20、25、50、100、200、500个或更多个碱基对内裂解。例如,CRISPR酶可指导一条或两条链在距PAM序列1、2、3、4、5、6、7、8、9、10、15、20、25、50、100、200、500个或更多个碱基对内或约1、2、3、4、5、6、7、8、9、10、15、20、25、50、100、200、500个或更多个碱基对内裂解。在一些情况下,引导多核苷酸结合距PAM 3至10个核苷酸的靶序列。可使用编码相对于相应的野生型酶突变的CRISPR酶的载体,使得突变的CRISPR酶缺乏裂解含有靶序列的靶多核苷酸的一条或两条链的能力。Cas蛋白可以是高保真Cas蛋白,如Cas9HiFi。在一些情况下,可对Cas蛋白进行修饰。例如,Cas蛋白修饰可包含N7-甲基-Gppp(2'-O-甲基-A)。In some aspects, the target sequence may be present within an intron or exon of a gene. In some cases, the CRISPR system can target exons of genes involved in the cannabinoid biosynthetic pathway. For example, a CRISPR enzyme can direct one or both strands at 1, 2, 3, 4, 5, 6, 7, 8, 9, 10, 15, 20, 25 from the first or last nucleotide of the target sequence , 50, 100, 200, 500 or more base pairs within or about 1, 2, 3, 4, 5, 6, 7, 8, 9, 10, 15, 20, 25, 50, 100, 200 , cleavage within 500 or more base pairs. For example, a CRISPR enzyme can direct one or both
Cas9可指与野生型示例性Cas9多肽(例如,来自酿脓链球菌的Cas9)具有至少或至少约50%、60%、70%、80%、90%、100%序列同一性和/或序列相似性的多肽。Cas9可指与野生型示例性Cas9多肽(例如,来自酿脓链球菌)具有至多或至多约50%、60%、70%、80%、90%、100%序列同一性和/或序列相似性的多肽。Cas9可指Cas9蛋白的野生型或修饰形式,其可包含氨基酸变化,如缺失、插入、取代、变体、突变、融合、嵌合体或它们的任何组合。在一些情况下,可对CRISPR酶(如Cas)进行密码子优化以在植物中表达。Cas9 can refer to at least or at least about 50%, 60%, 70%, 80%, 90%, 100% sequence identity and/or sequence to a wild-type exemplary Cas9 polypeptide (eg, Cas9 from S. pyogenes) similar peptides. Cas9 can refer to at most or at most about 50%, 60%, 70%, 80%, 90%, 100% sequence identity and/or sequence similarity to a wild-type exemplary Cas9 polypeptide (eg, from Streptococcus pyogenes) of polypeptides. Cas9 may refer to a wild-type or modified form of a Cas9 protein, which may contain amino acid changes, such as deletions, insertions, substitutions, variants, mutations, fusions, chimeras, or any combination thereof. In some cases, CRISPR enzymes (eg, Cas) can be codon-optimized for expression in plants.
可对编码核酸内切酶(例如,Cas蛋白,如Cas9)的多核苷酸进行密码子优化以在特定细胞如植物细胞中表达。这种类型的优化可能需要外源(例如重组)DNA的突变以模拟预期宿主生物体或细胞的密码子偏好,同时编码相同蛋白质。Polynucleotides encoding endonucleases (eg, Cas proteins, such as Cas9) can be codon-optimized for expression in specific cells, such as plant cells. This type of optimization may require mutation of exogenous (eg, recombinant) DNA to mimic the codon bias of the intended host organism or cell, while encoding the same protein.
核酸内切酶可包含与野生型示例性位点定向多肽(例如,来自酿脓链球菌的Cas9)的核酸酶结构域具有至少或至少约50%、60%、70%、75%、80%、85%、90%、95%、99%或100%氨基酸序列同一性的氨基酸序列。The endonuclease may comprise at least or at least about 50%, 60%, 70%, 75%, 80% of the nuclease domain of a wild-type exemplary site-directed polypeptide (eg, Cas9 from Streptococcus pyogenes). , 85%, 90%, 95%, 99% or 100% amino acid sequence identity.
酿脓链球菌Cas9(SpCas9)可用作基因组工程化的CRISPR核酸内切酶。在一些情况下,可使用不同的核酸内切酶来靶向某些基因组靶标。在一些情况下,可使用具有非NGGPAM序列的合成SpCas9来源的变体。此外,已经鉴定了来自不同物种的其它Cas9直向同源物,并且这些“非SpCas9”结合也可用于本发明的多种PAM序列。例如,相对较大的SpCas9(大约4kb编码序列)意味着携带SpCas9 cDNA的质粒可能不能在细胞中有效表达。相反,金黄色葡萄球菌Cas9(SaCas9)的编码序列比SpCas9短大约1千碱基,可能使其能够在细胞中有效表达。Streptococcus pyogenes Cas9 (SpCas9) can be used as a CRISPR endonuclease for genome engineering. In some cases, different endonucleases can be used to target certain genomic targets. In some cases, synthetic SpCas9-derived variants with sequences other than NGGPAM can be used. In addition, other Cas9 orthologs from different species have been identified, and these "non-SpCas9" bindings can also be used for various PAM sequences of the present invention. For example, the relatively large size of SpCas9 (approximately 4 kb coding sequence) means that plasmids carrying the SpCas9 cDNA may not be efficiently expressed in cells. In contrast, the coding sequence of Staphylococcus aureus Cas9 (SaCas9) is approximately 1 kilobase shorter than SpCas9, possibly enabling its efficient expression in cells.
酿脓链球菌Cas9的替代方案可包括来自Cpf1家族的RNA引导的核酸内切酶。与Cas9核酸酶不同,Cpf1介导的DNA裂解的结果是具有短3'突出端的双链断裂。Cpf1的交错裂解模式可开辟定向基因转移的可能性,类似于传统的限制酶克隆,这可提高基因编辑的效率。与上述Cas9变体和直向同源物一样,Cpf1也可将可被CRISPR靶向的位点数量扩展至缺乏SpCas9所偏爱的NGG PAM位点的富含AT的区域或富含AT的基因组。An alternative to S. pyogenes Cas9 may include RNA-guided endonucleases from the Cpf1 family. Unlike Cas9 nucleases, Cpf1-mediated DNA cleavage results in double-strand breaks with short 3' overhangs. The staggered cleavage pattern of Cpf1 opens up the possibility of directed gene transfer, similar to traditional restriction enzyme cloning, which can improve the efficiency of gene editing. Like the Cas9 variants and orthologs described above, Cpf1 can also expand the number of sites that can be targeted by CRISPR to AT-rich regions or AT-rich genomes that lack the NGG PAM sites favored by SpCas9.
在一些方面,Cas序列可含有核定位序列(NLS)。核定位序列可来自SV40。NLS可来自以下中的至少一者:SV40、核质蛋白、输入蛋白α、C-myc、EGL-13、TUS、hnRNPA1、Mata2或PY-NLS。NLS可位于Cas蛋白的C末端或N末端。在一些情况下,Cas蛋白可含有1至5个NLS序列。Cas蛋白可含有1、2、3、4、5、6、7、8、9或多达10个NLS序列。Cas蛋白(如Cas9)可含有两个NLS序列。Cas蛋白可含有SV40和核质蛋白NLS序列。Cas蛋白还可含有至少一个非翻译区。In some aspects, the Cas sequence can contain a nuclear localization sequence (NLS). The nuclear localization sequence can be derived from SV40. The NLS can be from at least one of: SV40, nucleoplasmin, importin alpha, C-myc, EGL-13, TUS, hnRNPA1, Mata2, or PY-NLS. The NLS can be located at the C-terminus or the N-terminus of the Cas protein. In some cases, the Cas protein may contain 1 to 5 NLS sequences. Cas proteins can contain 1, 2, 3, 4, 5, 6, 7, 8, 9 or up to 10 NLS sequences. Cas proteins, such as Cas9, can contain two NLS sequences. Cas proteins may contain SV40 and nucleoplasmic protein NLS sequences. Cas proteins may also contain at least one untranslated region.
在一些方面,编码CRISPR酶的载体可含有核定位序列(NLS)序列。在一些方面,载体可包含一个或多个NLS。在一些情况下,载体可含有约1、2、3、4、5、6、7、8、9或10个NLS。例如,CRISPR酶可包含在氨基末端处或附近的多于或多于约1、2、3、4、5、6、7、8、9、10个NLS,在羧基末端处或附近的多于或多于约1、2、3、4、5、6、7、8、9、10个NLS,或这些的任何组合(例如,在氨基末端的一个或多个NLS和在羧基末端的一个或多个NLS)。当存在多于一个NLS时,每个NLS可独立于其它NLS选择,使得单个NLS可存在于多于一个拷贝中和/或与一个或多个其它NLS组合存在于一个或多个拷贝中。In some aspects, a vector encoding a CRISPR enzyme can contain a nuclear localization sequence (NLS) sequence. In some aspects, a carrier may contain one or more NLSs. In some cases, the carrier may contain about 1, 2, 3, 4, 5, 6, 7, 8, 9, or 10 NLS. For example, a CRISPR enzyme can comprise more or more than about 1, 2, 3, 4, 5, 6, 7, 8, 9, 10 NLS at or near the amino terminus, and more than about 1, 2, 3, 4, 5, 6, 7, 8, 9, 10 NLS at or near the carboxy terminus or more than about 1, 2, 3, 4, 5, 6, 7, 8, 9, 10 NLS, or any combination of these (e.g., one or more NLS at the amino terminus and one or more at the carboxy terminus multiple NLS). When there is more than one NLS, each NLS may be selected independently of the other NLSs, such that a single NLS may exist in more than one copy and/or in one or more copies in combination with one or more other NLSs.
NLS可以是单分的或二分的。在一些情况下,与单分NLS相比,二分NLS可具有间隔区序列。NLS可来自以下中的至少一者:SV40、核质蛋白、输入蛋白α、C-myc、EGL-13、TUS、hnRNPA1、Mata2或PY-NLS。NLS可位于多肽链内的任何位置,例如靠近N或C末端。例如,NLS可在距N或C末端沿多肽链的1、2、3、4、5、10、15、20、25、30、40、50个氨基酸内或约1、2、3、4、5、10、15、20、25、30、40、50个氨基酸内。有时NLS可在距N或C末端的50个氨基酸或更多个氨基酸内或约50个氨基酸或更多个氨基酸内,例如100、200、300、400、500、600、700、800、900或1000个氨基酸。NLS can be one-point or two-point. In some cases, a bipartite NLS may have a spacer sequence compared to a unipartite NLS. The NLS can be from at least one of: SV40, nucleoplasmin, importin alpha, C-myc, EGL-13, TUS, hnRNPA1, Mata2, or PY-NLS. The NLS can be located anywhere within the polypeptide chain, eg, near the N- or C-terminus. For example, the NLS can be within or about 1, 2, 3, 4, 5, 10, 15, 20, 25, 30, 40, 50 amino acids along the polypeptide chain from the N- or C-terminus. Within 5, 10, 15, 20, 25, 30, 40, 50 amino acids. Sometimes the NLS can be within or about 50 amino acids or more from the N- or C-terminus, such as 100, 200, 300, 400, 500, 600, 700, 800, 900 or 1000 amino acids.
可将任何功能浓度的Cas蛋白引入细胞。例如,可将15微克的Cas mRNA引入细胞。在其它情况下,可引入0.5微克至100微克的Cas mRNA。可引入0.5、5、10、15、20、25、30、35、40、45、50、55、60、65、70、75、80、85、90、95或100微克的Cas mRNA。Cas protein can be introduced into cells at any functional concentration. For example, 15 micrograms of Cas mRNA can be introduced into cells. In other cases, 0.5 micrograms to 100 micrograms of Cas mRNA can be introduced. 0.5, 5, 10, 15, 20, 25, 30, 35, 40, 45, 50, 55, 60, 65, 70, 75, 80, 85, 90, 95 or 100 micrograms of Cas mRNA can be introduced.
在一些情况下,双切口酶方法可用于引入双链断裂或基因组断裂。Cas蛋白可在任一核酸酶结构域内的已知氨基酸处发生突变,从而缺失一个核酸酶结构域的活性并产生能够产生单链断裂的切口酶Cas蛋白。切口酶连同靶向相对链的两种不同引导RNA可用于在靶位点内产生双链断裂(DSB)(通常称为“双切口”或“双切口酶”CRISPR系统)。这种方法可显著提高靶标特异性,因为在足够接近的距离内产生两个脱靶切口以引起DSB是不太可能的。In some cases, the double nickase method can be used to introduce double strand breaks or genomic breaks. Cas proteins can be mutated at known amino acids within either nuclease domain, thereby deleting the activity of one nuclease domain and producing a nickase Cas protein capable of generating single-strand breaks. Nickases, along with two different guide RNAs targeting opposite strands, can be used to create double-strand breaks (DSBs) within the target site (often referred to as "double nick" or "double nickase" CRISPR systems). This approach can significantly improve target specificity, as it is unlikely that two off-target nicks will be generated in close enough proximity to cause DSBs.
可在使用前测试核酸酶(如Cas9)的身份和效力。例如,可使用分光光度分析、RNA琼脂糖凝胶分析、LC-MS、内毒素分析和无菌试验中的至少一者来确定身份和效力。在一些情况下,可对核酸酶序列(如Cas9序列)进行测序以确认其身份。在一些情况下,可在临床或治疗性使用之前对Cas蛋白(如Cas9蛋白)进行测序。例如,可通过聚丙烯酰胺凝胶电泳评估纯化的体外转录产物,以验证临床产品中除Cas9外不存在其它mRNA种类或基本上不存在其它mRNA种类。此外,编码Cas蛋白(如Cas9)的纯化mRNA可通过逆转录、随后测序步骤进行验证,以在核苷酸水平下验证身份。可通过聚丙烯酰胺凝胶电泳(PAGE)评估纯化的体外转录产物,以验证mRNA是对于Cas9所预期的大小,并且临床或治疗产品中基本上不存在其它mRNA种类。Nucleases such as Cas9 can be tested for identity and potency prior to use. For example, identity and potency can be determined using at least one of spectrophotometric analysis, RNA sepharose analysis, LC-MS, endotoxin analysis, and sterility testing. In some cases, the nuclease sequence (eg, the Cas9 sequence) can be sequenced to confirm its identity. In some cases, Cas proteins (eg, Cas9 proteins) can be sequenced prior to clinical or therapeutic use. For example, purified in vitro transcripts can be assessed by polyacrylamide gel electrophoresis to verify the absence or substantial absence of other mRNA species other than Cas9 in the clinical product. Furthermore, purified mRNA encoding Cas proteins such as Cas9 can be verified by reverse transcription followed by a sequencing step to verify identity at the nucleotide level. Purified in vitro transcripts can be assessed by polyacrylamide gel electrophoresis (PAGE) to verify that the mRNA is the size expected for Cas9 and that other mRNA species are substantially absent in clinical or therapeutic products.
在一些情况下,可确定核酸酶(如Cas9)的内毒素水平。临床上/治疗上可接受的内毒素水平可小于3EU/mL。临床上/治疗上可接受的内毒素水平可小于2EU/mL。临床上/治疗上可接受的内毒素水平可小于1EU/mL。临床上/治疗上可接受的内毒素水平可小于0.5EU/mL。In some cases, endotoxin levels of nucleases (eg, Cas9) can be determined. Clinically/therapeutic acceptable endotoxin levels may be less than 3 EU/mL. Clinically/therapeutic acceptable endotoxin levels may be less than 2 EU/mL. Clinically/therapeutic acceptable endotoxin levels may be less than 1 EU/mL. Clinically/therapeutic acceptable endotoxin levels may be less than 0.5 EU/mL.
在一些情况下,诸如Cas9的核酸酶可进行无菌试验。无菌试验的临床上/治疗上可接受的水平可以是0或由培养物上无生长表示。无菌试验的临床上/治疗上可接受的水平可以是小于0.5%、0.3%、0.1%或0.05%生长。In some cases, nucleases such as Cas9 can be tested for sterility. A clinically/therapeutic acceptable level for sterility testing can be zero or indicated by no growth in culture. A clinically/therapeutic acceptable level for sterility testing can be less than 0.5%, 0.3%, 0.1% or 0.05% growth.
引导多核酸guide polynucleotide
引导多核酸可以是DNA或RNA。引导多核酸可以是单链的或双链的。在一些情况下,引导多核酸可含有单链区域和双链区域的区。引导多核酸也可形成二级结构。如本文所用,术语“引导RNA(gRNA)”及其语法等效物可指可对靶DNA具有特异性并且可与Cas蛋白形成复合物的RNA。引导RNA可包含指定靶位点并将RNA/Cas复合物引导至指定的靶DNA以进行裂解的引导序列或间隔区序列。例如,引导RNA可使CRISPR复合物靶向靶基因或其部分并进行靶向双链断裂。靶DNA的位点特异性裂解在通过1)引导RNA与靶DNA(也称为原型间隔区)之间的碱基配对互补性和2)靶DNA中称为原型间隔区相邻基序(PAM)的短基序确定的位置处发生。在一些情况下,可使用算法来设计gRNA,所述算法可鉴定位于常见表达的转录物内的早期外显子中的gRNA。The guide polynucleic acid can be DNA or RNA. The guide polynucleic acid can be single-stranded or double-stranded. In some cases, the guide polynucleic acid may contain regions of single-stranded and double-stranded regions. Guide polynucleic acids can also form secondary structures. As used herein, the term "guide RNA (gRNA)" and its grammatical equivalents can refer to RNAs that can be specific for target DNA and that can form complexes with Cas proteins. The guide RNA may comprise a guide sequence or a spacer sequence that designates the target site and guides the RNA/Cas complex to the designated target DNA for cleavage. For example, guide RNAs can target a CRISPR complex to a target gene or portion thereof and make targeted double-strand breaks. Site-specific cleavage of target DNA occurs through 1) base-pairing complementarity between guide RNA and target DNA (also known as protospacer) and 2) a protospacer adjacent motif (PAM) in the target DNA ) at the position determined by the short motif. In some cases, gRNAs can be designed using algorithms that identify gRNAs located in early exons within commonly expressed transcripts.
在一些情况下,引导多核苷酸可与编码以下的基因的靶序列互补:甲基转移酶、羟化酶、单加氧酶、激酶、脱羧酶、转录调控因子、转运蛋白、吲哚胺2,3-双加氧酶(IDO)、色氨酸2,3-双加氧酶(TDO)、TrpM、磷酸-2-脱氢-3-脱氧庚酸醛缩酶、3-脱氢奎尼酸合酶、3-脱氢奎尼酸脱水酶、莽草酸脱氢酶、3-磷酸莽草酸1-羧基乙烯基转移酶、莽草酸激酶1、莽草酸激酶2、分支酸合酶、色氨酸合酶α链、色氨酸合酶β链、邻氨基苯甲酸磷酸核糖基转移酶和邻氨基苯甲酸合酶组分。在一些情况下,gRNA或gDNA可结合与SEQ ID NO:1-5或任何上述基因同源或互补的靶序列。In some cases, the guide polynucleotide can be complementary to a target sequence encoding a gene encoding a methyltransferase, hydroxylase, monooxygenase, kinase, decarboxylase, transcriptional regulator, transporter,
将功能基因拷贝、基因变体和假基因进行作图和比对,以产生用于CRISPR设计的序列模板。在一些情况下,多个引导RNA靶向序列在THCA合酶的所比对拷贝中保守,并且被设计为破坏早期编码序列并在所述编码序列中引入突变,如移码突变插入缺失。在一些情况下,可选择在大麻和火麻基因组中其它地方的脱靶位点发生率较低的引导RNA。Functional gene copies, gene variants, and pseudogenes are mapped and aligned to generate sequence templates for CRISPR design. In some cases, multiple guide RNA targeting sequences are conserved among the aligned copies of THCA synthase, and are designed to disrupt early coding sequences and introduce mutations in the coding sequences, such as frameshift indels. In some cases, guide RNAs can be selected that have a lower incidence of off-target sites elsewhere in the cannabis and hemp genomes.
在一个方面,可产生CRISPR gRNA文库并用于通过DNA分析筛选变体植物。多重CRISPR工程化可产生多种基因型的新型大麻素生产大麻植物。在一些情况下,这些植物产生升高水平的少量、稀有和/或研究不足的大麻素。In one aspect, CRISPR gRNA libraries can be generated and used to screen variant plants by DNA analysis. Multiplex CRISPR engineering yields multiple genotypes of novel cannabinoid-producing cannabis plants. In some cases, these plants produce elevated levels of small, rare and/or understudied cannabinoids.
在一些情况下,gRNA可被设计为靶向参与大麻素生物合成途径的基因的外显子。在一些情况下,gRNA可被设计为破坏早期编码序列。在一个方面,主题引导RNA可分为两类:旨在通过靶向在这些基因中具有早期位置的编码序列以引入移码突变插入缺失来破坏功能性蛋白质的产生的那些(KO引导);以及靶序列散布在基因调控区域内的那些(表达调节引导)。此外,可选择在大麻和火麻基因组中其它地方的脱靶位点发生率最低的引导RNA。In some cases, gRNAs can be designed to target exons of genes involved in the cannabinoid biosynthetic pathway. In some cases, gRNAs can be designed to disrupt early coding sequences. In one aspect, the subject guide RNAs can be divided into two categories: those designed to disrupt the production of functional proteins by targeting coding sequences with early positions in these genes to introduce frameshift mutational indels (KO guides); and Those whose target sequences are interspersed within gene regulatory regions (expression regulation guides). In addition, guide RNAs with the lowest incidence of off-target sites elsewhere in the cannabis and hemp genomes can be selected.
在一些情况下,可基于其插入靶基因中的插入缺失模式来选择gRNA。候选gRNA可使用评分系统按脱靶潜力进行排序,所述评分系统可考虑:(a)gRNA序列与任何紧密匹配的基因组序列之间的错配总数;(b)相对于PAM位点的错配位置,其与靠近PAM位点的错配对活性的负面影响相关;(c)错配之间的距离,以解释相邻错配在破坏引导DNA相互作用中的累积效应;以及它们的任何组合。在一些情况下,gRNA与基因组靶位点之间的更多错配可产生CRISPR介导的对所述位点的裂解的较低可能性。在一些情况下,错配位置与PAM位点直接相邻。在其它情况下,错配位置可距PAM位点1个核苷酸至100千碱基。在一些情况下,包含错配的候选gRNA可能不与PAM相邻。在其它情况下,包含错配的至少两种候选gRNA可彼此相距1个核苷酸至100千碱基结合基因组。错配可以是核苷酸的取代。例如,在一些情况下,将用G取代T。gRNA与基因组之间的错配可允许降低的CRISPR基因编辑保真度。在一些情况下,阳性评分gRNA的长度可以是约110个核苷酸,并且可能不含与互补基因组序列的错配。在其它情况下,阳性评分gRNA的长度可以是约110个核苷酸,并且可含有与互补基因组序列的至多3个错配。在其它情况下,阳性评分gRNA的长度可以是约110个核苷酸,并且可含有与互补基因组序列的至多20个错配。在一些情况下,引导多核酸可含有可以是硫代磷酸酯的核苷酸间键联。可存在任何数量的硫代磷酸酯。例如,引导多核酸序列中可存在1至约100个硫代磷酸酯。在一些情况下,存在1至10个硫代磷酸酯。在一些情况下,引导多核酸序列中存在8个硫代磷酸酯。In some cases, a gRNA can be selected based on its indel pattern into the target gene. Candidate gRNAs can be ranked by off-target potential using a scoring system that considers: (a) the total number of mismatches between the gRNA sequence and any closely matched genomic sequence; (b) the position of mismatches relative to the PAM site , which correlates with the negative impact of mismatch pairing activity close to the PAM site; (c) the distance between mismatches, to account for the cumulative effect of adjacent mismatches in disrupting guided DNA interactions; and any combination thereof. In some cases, more mismatches between the gRNA and the genomic target site can create a lower likelihood of CRISPR-mediated cleavage of that site. In some cases, the mismatch position is directly adjacent to the PAM site. In other cases, the mismatch position can be from 1 nucleotide to 100 kilobases from the PAM site. In some cases, candidate gRNAs containing mismatches may not be adjacent to the PAM. In other cases, at least two candidate gRNAs comprising mismatches can bind the genome from 1 nucleotide to 100 kilobases apart from each other. Mismatches can be substitutions of nucleotides. For example, in some cases, T will be replaced by G. Mismatches between gRNAs and genomes can allow for reduced fidelity of CRISPR gene editing. In some cases, a positive scoring gRNA can be about 110 nucleotides in length and may not contain mismatches to complementary genomic sequences. In other cases, a positive scoring gRNA can be about 110 nucleotides in length and can contain up to 3 mismatches to complementary genomic sequences. In other cases, a positive scoring gRNA can be about 110 nucleotides in length and can contain up to 20 mismatches to complementary genomic sequences. In some cases, the guide polynucleic acid can contain internucleotide linkages that can be phosphorothioates. Any number of phosphorothioates may be present. For example, from 1 to about 100 phosphorothioates may be present in the guide polynucleotide sequence. In some cases, 1 to 10 phosphorothioates are present. In some cases, 8 phosphorothioates are present in the guide polynucleotide sequence.
在一些情况下,可设计和选择最高得分gRNA,并且可在植物细胞中通过实验方式评估每种gRNA的中靶编辑效率。在一些情况下,如通过TiDE分析确定的编辑效率可超过至少约20%。在其它情况下,编辑效率可以是约20%至约50%、约50%至约80%、约80%至约100%。在一些情况下,可在试验GMP运行中确定插入缺失百分比。例如,可通过桑格测序和TIDE分析来分析最终细胞产物的中靶插入缺失形成。基因组DNA可从来自对照和实验样品的约1x106个细胞中提取,并使用位于已被破坏的基因(如参与大麻素生物合成途径的基因)侧翼的引物进行PCR。可使用TIDE软件程序分析桑格测序色谱图,所述软件程序可通过比较对照样品和敲除样品来定量插入缺失频率和插入缺失的大小分布。In some cases, the highest scoring gRNAs can be designed and selected, and the on-target editing efficiency of each gRNA can be assessed experimentally in plant cells. In some cases, editing efficiencies, as determined by TiDE analysis, can exceed at least about 20%. In other cases, the editing efficiency can be about 20% to about 50%, about 50% to about 80%, about 80% to about 100%. In some cases, the percentage of indels can be determined in an experimental GMP run. For example, the final cellular product can be analyzed for on-target indel formation by Sanger sequencing and TIDE analysis. Genomic DNA can be extracted from approximately1x106 cells from control and experimental samples and PCR performed using primers flanking genes that have been disrupted, such as those involved in the cannabinoid biosynthetic pathway. Sanger sequencing chromatograms can be analyzed using the TIDE software program that can quantify indel frequency and indel size distribution by comparing control and knockout samples.
本文公开的方法还可包括将至少一种引导RNA或核酸(例如编码至少一种引导RNA的DNA)引入细胞或植物胚中。引导RNA可与RNA引导的核酸内切酶相互作用以将核酸内切酶导向至特定靶位点,在所述位点处,引导RNA的5'端与染色体序列中的特定原型间隔区序列碱基配对。The methods disclosed herein may also include introducing at least one guide RNA or nucleic acid (eg, DNA encoding at least one guide RNA) into the cell or plant embryo. Guide RNAs can interact with RNA-guided endonucleases to direct the endonuclease to a specific target site where the 5' end of the guide RNA is linked to a specific protospacer sequence base in the chromosomal sequence base pairing.
引导RNA可包含两种RNA,例如CRISPR RNA(crRNA)和反式激活crRNA(tracrRNA)。引导RNA有时可包含由crRNA和tracrRNA的一部分(例如,功能部分)融合形成的单引导RNA(sgRNA)。引导RNA也可以是包含crRNA和tracrRNA的双RNA。引导RNA可包含crRNA并且缺少tracrRNA。此外,crRNA可与靶DNA或原型间隔区序列杂交。Guide RNAs can comprise two types of RNAs, such as CRISPR RNA (crRNA) and transactivating crRNA (tracrRNA). Guide RNAs may sometimes comprise single guide RNAs (sgRNAs) formed by the fusion of crRNA and a portion (eg, a functional portion) of tracrRNA. The guide RNA can also be a double RNA comprising crRNA and tracrRNA. The guide RNA may contain crRNA and lack tracrRNA. In addition, crRNA can hybridize to target DNA or protospacer sequences.
如上所述,引导RNA可以是表达产物。例如,编码引导RNA的DNA可以是包含编码引导RNA的序列的载体。通过用分离的引导RNA或包含编码引导RNA的序列和启动子的质粒DNA转染细胞或植物胚,可将引导RNA转移至细胞或生物体中。在一些方面,启动子可选自由以下组成的组:叶特异性启动子、花特异性启动子、THCA合酶启动子、CaMV35S启动子、FMV35S启动子和tCUP启动子。引导RNA也可以其它方式(如使用粒子轰击)转移至细胞或植物胚中。As mentioned above, the guide RNA can be the product of expression. For example, the DNA encoding the guide RNA can be a vector comprising the sequence encoding the guide RNA. Guide RNAs can be transferred into cells or organisms by transfecting cells or plant embryos with an isolated guide RNA or plasmid DNA comprising a sequence encoding the guide RNA and a promoter. In some aspects, the promoter can be selected from the group consisting of a leaf-specific promoter, a flower-specific promoter, a THCA synthase promoter, a CaMV35S promoter, an FMV35S promoter, and a tCUP promoter. Guide RNAs can also be transferred into cells or plant embryos by other means, such as using particle bombardment.
可分离引导RNA。例如,引导RNA可以分离的RNA的形式转染到细胞或植物胚中。可使用任何体外转录系统通过体外转录制备引导RNA。引导RNA可以分离的RNA的形式而不是以包含引导RNA的编码序列的质粒的形式转移至细胞中。Guide RNA can be isolated. For example, guide RNA can be transfected into cells or plant embryos in the form of isolated RNA. Guide RNA can be prepared by in vitro transcription using any in vitro transcription system. The guide RNA can be transferred to the cell in the form of an isolated RNA rather than a plasmid containing the coding sequence for the guide RNA.
引导RNA可包含DNA靶向区段和蛋白质结合区段。DNA靶向区段(或DNA靶向序列,或间隔区序列)包含可与靶DNA内的特定序列(例如,原型间隔区)互补的核苷酸序列。蛋白质结合区段(或“蛋白质结合序列”)可与定点修饰多肽,例如RNA引导的核酸内切酶如Cas蛋白相互作用。“区段”意指分子的区段/部分/区域,例如RNA中的一段连续核苷酸。区段还可意指复合物的区域/部分,以使得区段可包含多于一个分子的区域。例如,在一些情况下,靶向DNA的RNA的蛋白质结合区段是一个RNA分子并且因此蛋白质结合区段包含所述RNA分子的区域。在其它情况下,靶向DNA的RNA的蛋白质结合区段包含沿着具有互补性的区域杂交的两个分开的分子。The guide RNA can comprise a DNA targeting segment and a protein binding segment. A DNA targeting segment (or DNA targeting sequence, or spacer sequence) comprises a nucleotide sequence that is complementary to a specific sequence (eg, a protospacer) within the target DNA. A protein-binding segment (or "protein-binding sequence") can interact with a site-directed modifying polypeptide, eg, an RNA-guided endonuclease such as a Cas protein. "Segment" means a segment/portion/region of a molecule, eg, a contiguous stretch of nucleotides in RNA. A segment may also mean a region/portion of a complex, such that a segment may comprise a region of more than one molecule. For example, in some cases, the protein-binding segment of a DNA-targeting RNA is an RNA molecule and thus the protein-binding segment comprises a region of the RNA molecule. In other cases, the protein-binding segment of the DNA-targeting RNA comprises two separate molecules that hybridize along regions of complementarity.
引导RNA可包含两个分开的RNA分子或单个RNA分子。示例性单分子引导RNA包含DNA靶向区段和蛋白质结合区段两者。The guide RNA can comprise two separate RNA molecules or a single RNA molecule. Exemplary single-molecule guide RNAs comprise both DNA targeting segments and protein binding segments.
示例性两分子靶向DNA的RNA可包含crRNA样(“CRISPR RNA”或“靶向物-RNA”或“crRNA”或“crRNA重复”)分子和对应的tracrRNA样(“反式作用CRISPR RNA”或“激活物-RNA”或“tracrRNA”)分子。第一RNA分子可以是crRNA样分子(靶向物-RNA),其可包含DNA靶向区段(例如,间隔区)和可形成包含引导RNA的蛋白质结合区段的双链RNA(dsRNA)双链体的一半的核苷酸序列段。第二RNA分子可以是对应的tracrRNA样分子(激活物-RNA),其可包含可形成引导RNA的蛋白质结合区段的dsRNA双链体的另一半的核苷酸序列段。换言之,crRNA样分子的核苷酸序列段与tracrRNA样分子的核苷酸序列段可互补并且可杂交以形成引导RNA的蛋白质结合结构域的dsRNA双链体。因此,每个crRNA样分子均可被称作具有对应的tracrRNA样分子。crRNA样分子另外可提供单链DNA靶向区段或间隔区序列。因此,crRNA样和tracrRNA样分子(作为对应的一对)可杂交以形成引导RNA。主题两分子引导RNA可包含任何对应的crRNA和tracrRNA对。An exemplary two-molecule DNA-targeting RNA may comprise a crRNA-like ("CRISPR RNA" or "targeter-RNA" or "crRNA" or "crRNA repeat") molecule and a corresponding tracrRNA-like ("trans-acting CRISPR RNA") molecule. or "activator-RNA" or "tracrRNA") molecule. The first RNA molecule can be a crRNA-like molecule (targeter-RNA), which can comprise a DNA targeting segment (eg, a spacer) and a double-stranded RNA (dsRNA) duplex that can form a protein-binding segment comprising a guide RNA. A stretch of nucleotide sequence that is half of the chain. The second RNA molecule can be a corresponding tracrRNA-like molecule (activator-RNA), which can comprise a stretch of nucleotide sequences that can form the other half of the dsRNA duplex of the protein-binding segment of the guide RNA. In other words, the nucleotide sequence of the crRNA-like molecule is complementary to the nucleotide sequence of the tracrRNA-like molecule and can hybridize to form a dsRNA duplex of the protein-binding domain of the guide RNA. Thus, each crRNA-like molecule can be said to have a corresponding tracrRNA-like molecule. crRNA-like molecules may additionally provide single-stranded DNA targeting segments or spacer sequences. Thus, crRNA-like and tracrRNA-like molecules (as a corresponding pair) can hybridize to form guide RNAs. A subject two-molecule guide RNA can comprise any corresponding crRNA and tracrRNA pair.
引导RNA的DNA靶向区段或间隔区序列可与染色体序列中的靶位点处的序列(例如原型间隔区序列)互补,使得引导RNA的DNA靶向区段可与靶位点或原型间隔区碱基配对。在一些情况下,引导RNA的DNA靶向区段可包含10个核苷酸或约10个核苷酸至25个核苷酸或约25个核苷酸或更多个核苷酸。例如,引导RNA的第一区与染色体序列中的靶位点之间的碱基配对区的长度可以是或可以是约10、11、12、13、14、15、16、17、18、19、20、22、23、24、25个或超过25个核苷酸。有时,引导RNA的第一区的长度可以是或可以是约19、20或21个核苷酸。The DNA targeting segment or spacer sequence of the guide RNA can be complementary to a sequence at the target site in the chromosomal sequence (eg, a protospacer sequence), such that the DNA targeting segment of the guide RNA can be complementary to the target site or protospacer Region base pairing. In some cases, the DNA targeting segment of the guide RNA can comprise from 10 nucleotides or about 10 nucleotides to 25 nucleotides or about 25 nucleotides or more. For example, the length of the base-pairing region between the first region of the guide RNA and the target site in the chromosomal sequence can be or can be about 10, 11, 12, 13, 14, 15, 16, 17, 18, 19 , 20, 22, 23, 24, 25 or more than 25 nucleotides. Sometimes, the first region of the guide RNA can be or can be about 19, 20 or 21 nucleotides in length.
引导RNA可靶向20个核苷酸或约20个核苷酸的核酸序列。靶核酸可少于或少于约20个核苷酸。靶核酸可以是至少或至少约5、10、15、16、17、18、19、20、21、22、23、24、25、30个或更多个核苷酸。靶核酸可以是至多或至多约5、10、15、16、17、18、19、20、21、22、23、24、25、30个或更多个核苷酸。靶核酸序列可以是紧邻PAM的第一个核苷酸的5'的20个碱基或可以是紧邻PAM的第一个核苷酸的5'的约20个碱基。引导RNA可靶向编码参与大麻素生物合成途径的蛋白质的基因的核酸序列。在一些情况下,引导多核酸(如引导RNA)可结合距PAM约1个碱基对至约20个碱基对的基因组区域。引导可结合距PAM约1、2、3、4、5、6、7、8、9、10、11、12、13、14、15、16、17、18、19或高达约20个碱基对的基因组区域。Guide RNAs can target nucleic acid sequences of 20 nucleotides or about 20 nucleotides. The target nucleic acid can be less than or less than about 20 nucleotides. The target nucleic acid can be at least or at least about 5, 10, 15, 16, 17, 18, 19, 20, 21, 22, 23, 24, 25, 30 or more nucleotides. The target nucleic acid can be at most or at most about 5, 10, 15, 16, 17, 18, 19, 20, 21, 22, 23, 24, 25, 30 or more nucleotides. The target nucleic acid sequence can be 20 bases immediately 5' of the first nucleotide of the PAM or can be about 20 bases immediately 5' of the first nucleotide of the PAM. Guide RNAs can target nucleic acid sequences of genes encoding proteins involved in the cannabinoid biosynthetic pathway. In some cases, the guide polynucleic acid (eg, guide RNA) can bind to a genomic region from about 1 base pair to about 20 base pairs from the PAM. Guides can bind about 1, 2, 3, 4, 5, 6, 7, 8, 9, 10, 11, 12, 13, 14, 15, 16, 17, 18, 19 or up to about 20 bases from the PAM pair of genomic regions.
引导核酸(例如引导RNA)可指可与另一种核酸,例如细胞基因组中的靶核酸或原型间隔区杂交的核酸。引导核酸可以是RNA。引导核酸可以是DNA。引导核酸可被编程或设计为与核酸序列位点特异性地结合。引导核酸可包含多核苷酸链并且可被称为单引导核酸。引导核酸可包含两个多核苷酸链并且可被称为双引导核酸。A guide nucleic acid (eg, guide RNA) can refer to a nucleic acid that can hybridize to another nucleic acid, such as a target nucleic acid or a protospacer in the genome of a cell. The guide nucleic acid can be RNA. The guide nucleic acid can be DNA. Guide nucleic acids can be programmed or designed to bind site-specifically to nucleic acid sequences. A guide nucleic acid may comprise a polynucleotide chain and may be referred to as a single guide nucleic acid. A guide nucleic acid may comprise two polynucleotide strands and may be referred to as a dual guide nucleic acid.
引导核酸可包含一种或多种修饰以提供具有新的或增强的特征的核酸。引导核酸可包含核酸亲和标签。引导核酸可包含合成核苷酸、合成核苷酸类似物、核苷酸衍生物和/或经修饰的核苷酸。引导核酸可例如在5'端或3'端处或附近包含可与靶核酸中的序列(例如,原型间隔区)杂交的核苷酸序列(例如,间隔区)。引导核酸的间隔区可经由杂交(即,碱基配对)以序列特异性方式与靶核酸相互作用。间隔区序列可与位于原型间隔区相邻基序(PAM)的5'或3'的靶核酸杂交。间隔区序列的长度可以是至少或至少约5、10、15、16、17、18、19、20、21、22、23、24、25、30个或更多个核苷酸。间隔区序列的长度可以是至多或至多约5、10、15、16、17、18、19、20、21、22、23、24、25、30个或更多个核苷酸。The guide nucleic acid may contain one or more modifications to provide a nucleic acid with new or enhanced characteristics. The guide nucleic acid may comprise a nucleic acid affinity tag. Guide nucleic acids can comprise synthetic nucleotides, synthetic nucleotide analogs, nucleotide derivatives, and/or modified nucleotides. The guide nucleic acid can comprise a nucleotide sequence (eg, a spacer) that can hybridize to a sequence (eg, a protospacer) in the target nucleic acid, eg, at or near the 5' end or the 3' end. The spacer region of the guide nucleic acid can interact with the target nucleic acid in a sequence-specific manner via hybridization (ie, base pairing). The spacer sequence can hybridize to a target nucleic acid located 5' or 3' to the protospacer adjacent motif (PAM). The length of the spacer sequence can be at least or at least about 5, 10, 15, 16, 17, 18, 19, 20, 21, 22, 23, 24, 25, 30 or more nucleotides in length. The length of the spacer sequence can be at most or at most about 5, 10, 15, 16, 17, 18, 19, 20, 21, 22, 23, 24, 25, 30 or more nucleotides in length.
引导RNA还可包含形成二级结构的dsRNA双链体区域。例如,由引导RNA形成的二级结构可包含茎(或发夹)和环。环和茎的长度可变化。例如,环的长度可在约3至约10个核苷酸的范围内,并且茎的长度可在约6至约20个碱基对的范围内。茎可包含一个或多个1至约10个核苷酸的凸起。第二区域的总长度可在约16至约60个核苷酸长度的范围内。例如,环的长度可以是或可以是约4个核苷酸,并且茎可以是或可以是约12个碱基对。dsRNA双链体区域可包含可与RNA结合蛋白,如RNA引导的核酸内切酶,例如Cas蛋白形成复合物的蛋白质结合区段。The guide RNA may also comprise a dsRNA duplex region that forms secondary structure. For example, the secondary structure formed by the guide RNA may comprise stems (or hairpins) and loops. The lengths of the loops and stems can vary. For example, the length of the loop can range from about 3 to about 10 nucleotides and the length of the stem can range from about 6 to about 20 base pairs. The stem may contain one or more bulges of 1 to about 10 nucleotides. The overall length of the second region can range from about 16 to about 60 nucleotides in length. For example, the loop can be or can be about 4 nucleotides in length, and the stem can be or can be about 12 base pairs in length. The dsRNA duplex region can comprise a protein-binding segment that can form a complex with an RNA-binding protein, such as an RNA-guided endonuclease, eg, a Cas protein.
引导RNA还可在5'或3'端包含尾区,所述尾区可基本上是单链的。例如,尾区有时与目标细胞中的任何染色体序列不互补,并且有时与引导RNA的其余部分不互补。此外,尾区的长度可变化。尾区的长度可多于或多于约4个核苷酸。例如,尾区的长度可在5或约5至60或约60个核苷酸的范围内。The guide RNA may also comprise a tail region at the 5' or 3' end, which tail region may be substantially single-stranded. For example, the tail region is sometimes not complementary to any chromosomal sequence in the target cell, and sometimes is not complementary to the rest of the guide RNA. Furthermore, the length of the tail region can vary. The tail region can be more or more than about 4 nucleotides in length. For example, the length of the tail region can range from at or about 5 to at or about 60 nucleotides.
引导RNA可以RNA分子形式引入细胞或胚中。例如,RNA分子可在体外转录和/或可化学合成。引导RNA然后可以RNA分子形式引入细胞或胚中。引导RNA也可以非RNA核酸分子,例如DNA分子的形式引入细胞或胚中。例如,编码引导RNA的DNA能够可操作地连接至启动子控制序列,以用于在目标细胞或胚中表达所述引导RNA。RNA编码序列能够可操作地连接至由RNA聚合酶III(Pol III)识别的启动子序列。Guide RNAs can be introduced into cells or embryos in the form of RNA molecules. For example, RNA molecules can be transcribed in vitro and/or can be chemically synthesized. The guide RNA can then be introduced into the cell or embryo in the form of an RNA molecule. Guide RNAs can also be introduced into cells or embryos in the form of non-RNA nucleic acid molecules, such as DNA molecules. For example, DNA encoding a guide RNA can be operably linked to a promoter control sequence for expression of the guide RNA in a target cell or embryo. The RNA coding sequence can be operably linked to a promoter sequence recognized by RNA polymerase III (Pol III).
编码引导RNA的DNA分子还可以是线性的。编码引导RNA的DNA分子还可以是环状的。编码引导RNA的DNA分子还可以是载体的一部分。载体的一些实例可包括质粒载体、噬菌粒、粘粒、人工/微型染色体、转座子和病毒载体。例如,编码RNA引导的核酸内切酶的DNA存在于质粒载体中。合适的质粒载体的其它非限制性实例包括pUC、pBR322、pET、pBluescript以及它们的变体。此外,载体可包含另外的表达控制序列(例如,增强子序列、Kozak序列、聚腺苷酸化序列、转录终止序列等)、选择性标记物序列(例如,抗生素抗性基因)、复制起点等。The DNA molecule encoding the guide RNA can also be linear. The DNA molecule encoding the guide RNA can also be circular. The DNA molecule encoding the guide RNA can also be part of the vector. Some examples of vectors may include plasmid vectors, phagemids, cosmids, artificial/minichromosomes, transposons, and viral vectors. For example, DNA encoding an RNA-guided endonuclease is present in a plasmid vector. Other non-limiting examples of suitable plasmid vectors include pUC, pBR322, pET, pBluescript and variants thereof. In addition, the vector may contain additional expression control sequences (eg, enhancer sequences, Kozak sequences, polyadenylation sequences, transcription termination sequences, etc.), selectable marker sequences (eg, antibiotic resistance genes), origins of replication, and the like.
当RNA引导的核酸内切酶和引导RNA以DNA分子的形式引入细胞时,各自可以是单独分子(例如,含有融合蛋白编码序列的一个载体和含有引导RNA编码序列的第二载体)的一部分,或者两者可以是同一分子(例如,含有融合蛋白和引导RNA两者的编码(和调控)序列的一个载体)的一部分。When the RNA-guided endonuclease and guide RNA are introduced into a cell as DNA molecules, each can be part of a separate molecule (e.g., one vector containing the fusion protein coding sequence and a second vector containing the guide RNA coding sequence), Alternatively both can be part of the same molecule (eg, one vector containing the coding (and regulatory) sequences for both the fusion protein and the guide RNA).
Cas蛋白(如Cas9蛋白或其任何衍生物)可与引导RNA预先复合以形成核糖核蛋白(RNP)复合物。RNP复合物可被引入植物细胞中。RNP复合物的引入可为时控的。细胞可在细胞周期的G1、S和/或M期与其它细胞同步。RNP复合物可在细胞阶段递送,使得HDR增强。RNP复合物可促进同源定向修复。A Cas protein (eg, Cas9 protein or any derivative thereof) can be precomplexed with guide RNA to form a ribonucleoprotein (RNP) complex. RNP complexes can be introduced into plant cells. The introduction of the RNP complex can be time-controlled. Cells can synchronize with other cells during the G1, S and/or M phases of the cell cycle. The RNP complex can be delivered at the cellular stage, resulting in enhanced HDR. The RNP complex promotes homology-directed repair.
还可对引导RNA进行修饰。修饰可包括化学改变、合成修饰、核苷酸添加和/或核苷酸消减。所述修饰还可增强CRISPR基因组工程化。修饰可改变gRNA的手性。在一些情况下,在修饰后手性可以是均一的或立体纯的。可合成引导RNA。合成的引导RNA可增强CRISPR基因组工程化。还可截短引导RNA。截短可用于减少不合需要的脱靶诱变。截短可包含任何数量的核苷酸缺失。例如,截短可包含1、2、3、4、5、10、15、20、25、30、40、50个或更多个核苷酸。引导RNA可包含任何长度的靶互补性区域。例如,靶互补性区域的长度可小于20个核苷酸。靶互补性区域的长度可多于20个核苷酸。靶互补性区域可靶向与PAM序列直接相邻的约5bp至约20bp。靶互补性区域可靶向与PAM序列直接相邻的约13bp。如本文所述的多核酸可经修饰。可在多核酸的任何位置进行修饰。可对单一多核酸进行超过一种修饰。多核酸可在修饰后进行质量控制。在一些情况下,质量控制可包括PAGE、HPLC、MS或它们的任何组合。修饰可以是取代、插入、缺失、化学修饰、物理修饰、稳定化、纯化或它们的任何组合。多核酸也可通过以下各项进行修饰:5'腺苷酸、5'鸟苷-三磷酸帽、5’N7-甲基鸟苷-三磷酸帽、5'三磷酸帽、3'磷酸、3'硫代磷酸、5'磷酸、5'硫代磷酸、Cis-Syn胸苷二聚体、三聚体、C12间隔区、C3间隔区、C6间隔区、dSpacer、PC间隔区、rSpacer、间隔区18、间隔区9,3’-3’修饰、5'-5'修饰、无碱基、吖啶、偶氮苯、生物素、生物素BB、生物素TEG、胆固醇基TEG、脱硫生物素TEG、DNPTEG、DNP-X、DOTA、dT-生物素、双重生物素、PC生物素、补骨脂素C2、补骨脂素C6、TINA、3’DABCYL、黑洞淬灭剂1、黑洞淬灭剂2、DABCYL SE、dT-DABCYL、IRDye QC-1、QSY-21、QSY-35、QSY-7、QSY-9、羧基接头、硫醇接头、2'脱氧核糖核苷类似物嘌呤、2'脱氧核糖核苷类似物嘧啶、核糖核苷类似物、2'-0-甲基核糖核苷类似物、糖修饰的类似物、摆动/通用碱基、荧光染料标记、2'氟RNA、2'O-甲基RNA、膦酸甲酯、磷酸二酯DNA、磷酸二酯RNA、硫代磷酸酯DNA、硫代磷酸酯RNA、UNA、假尿苷-5'-三磷酸、5-甲基胞苷-5'-三磷酸或它们的任何组合。在一些情况下,修饰可以是永久性的。在其它情况下,修饰可以是短暂的。在一些情况下,对多核酸进行多种修饰。多核酸修饰可改变核苷酸的物理化学性质,如它们的构象、极性、疏水性、化学反应性、碱基配对相互作用或它们的任何组合。在一些方面,gRNA可经修饰。在一些情况下,修饰是在5'端上、3'端上、从5'端至3'端、单碱基修饰、2'-核糖修饰或它们的任何组合。修饰可选自由以下组成的组:碱基取代、插入、缺失、化学修饰、物理修饰、稳定化、纯化以及它们的任何组合。在一些情况下,修饰是化学修饰。Guide RNAs can also be modified. Modifications can include chemical changes, synthetic modifications, nucleotide additions, and/or nucleotide deletions. The modifications may also enhance CRISPR genome engineering. Modifications can alter the chirality of the gRNA. In some cases, the chirality can be homogeneous or stereopure after modification. Guide RNA can be synthesized. Synthetic guide RNAs enhance CRISPR genome engineering. Guide RNAs can also be truncated. Truncations can be used to reduce unwanted off-target mutagenesis. Truncations can include deletions of any number of nucleotides. For example, a truncation can comprise 1, 2, 3, 4, 5, 10, 15, 20, 25, 30, 40, 50 or more nucleotides. Guide RNAs can comprise regions of target complementarity of any length. For example, the target complementarity region can be less than 20 nucleotides in length. The target complementarity region can be more than 20 nucleotides in length. The region of target complementarity can be targeted from about 5 bp to about 20 bp directly adjacent to the PAM sequence. The target complementarity region can be targeted to about 13 bp directly adjacent to the PAM sequence. Polynucleic acids as described herein can be modified. Modifications can be made at any position in the polynucleic acid. More than one modification can be made to a single polynucleic acid. Polynucleic acids can be modified for quality control. In some cases, quality control can include PAGE, HPLC, MS, or any combination thereof. Modifications can be substitutions, insertions, deletions, chemical modifications, physical modifications, stabilization, purification, or any combination thereof. Polynucleic acids can also be modified by: 5' adenylate, 5'guanosine-triphosphate cap,5'N7 -methylguanosine-triphosphate cap, 5'triphosphate cap, 3'phosphate, 3' phosphorothioate, 5' phosphate, 5' phosphorothioate, Cis-Syn thymidine dimer, trimer, C12 spacer, C3 spacer, C6 spacer, dSpacer, PC spacer, rSpacer, spacer Region 18, Spacer 9, 3'-3' Modified, 5'-5' Modified, Abasic, Acridine, Azobenzene, Biotin, Biotin BB, Biotin TEG, Cholesteryl TEG, Dethiobiotin TEG, DNPTEG, DNP-X, DOTA, dT-biotin, dual biotin, PC biotin, psoralen C2, psoralen C6, TINA, 3'DABCYL, black hole quencher 1, black hole quencher Agent 2, DABCYL SE, dT-DABCYL, IRDye QC-1, QSY-21, QSY-35, QSY-7, QSY-9, carboxyl linker, thiol linker, 2' deoxyribonucleoside analog purine, 2' Deoxyribonucleoside analogs pyrimidine, ribonucleoside analogs, 2'-O-methyl ribonucleoside analogs, sugar-modified analogs, wobble/universal bases, fluorescent dye labels, 2' fluoroRNA, 2' O-methyl RNA, methyl phosphonate, phosphodiester DNA, phosphodiester RNA, phosphorothioate DNA, phosphorothioate RNA, UNA, pseudouridine-5'-triphosphate, 5-methylcytosine glycoside-5'-triphosphate or any combination thereof. In some cases, the modification can be permanent. In other cases, modifications may be transient. In some cases, various modifications are made to the polynucleic acid. Polynucleic acid modifications can alter the physicochemical properties of nucleotides, such as their conformation, polarity, hydrophobicity, chemical reactivity, base pairing interactions, or any combination thereof. In some aspects, the gRNA can be modified. In some cases, the modification is on the 5' end, on the 3' end, from the 5' end to the 3' end, a single base modification, a 2'-ribose modification, or any combination thereof. Modifications can be selected from the group consisting of base substitutions, insertions, deletions, chemical modifications, physical modifications, stabilization, purification, and any combination thereof. In some cases, the modification is a chemical modification.
在一些情况下,修饰是表示为“m”的2-O-甲基3硫代磷酸酯添加。硫代磷酸酯主链可表示为“(ps)”。可从1个碱基至150个碱基进行2-O-甲基3硫代磷酸酯添加。可从1个碱基至4个碱基进行2-O-甲基3硫代磷酸酯添加。可在2个碱基上进行2-O-甲基3硫代磷酸酯添加。可在4个碱基上进行2-O-甲基3硫代磷酸酯添加。修饰也可以是截短。截短可以是5个碱基的截短。在一些情况下,修饰可位于C末端和N末端核苷酸。In some cases, the modification is the addition of 2-O-methyl phosphorothioate denoted "m". The phosphorothioate backbone can be represented as "(ps)". 2-O-methyl phosphorothioate addition can be performed from 1 base to 150 bases. 2-O-Methyl phosphorothioate addition can be performed from 1 base to 4 bases. 2-O-Methyl phosphorothioate addition can be done on 2 bases. 2-O-Methyl phosphorothioate addition can be done at 4 bases. Modifications can also be truncations. The truncation can be a 5 base truncation. In some cases, modifications can be at the C-terminal and N-terminal nucleotides.
修饰也可以是硫代磷酸酯替代物。在一些情况下,天然磷酸二酯键可易于被细胞核酸酶快速降解,并且;使用硫代磷酸酯(PS)键替代物对核苷酸间键联的修饰对于通过细胞降解水解可更稳定。修饰可增加多核酸的稳定性。修饰还可增强生物活性。在一些情况下,硫代磷酸酯增强的RNA多核酸可抑制RNA酶A、RNA酶T1、小牛血清核酸酶或它们的任何组合。这些性质可允许PS-RNA多核酸用于在体内或体外暴露于核酸酶的可能性较高的应用中。例如,可在多核酸的5'或3'端的最后3-5个核苷酸之间引入硫代磷酸酯(PS)键,其可抑制核酸外切酶降解。在一些情况下,可在整个多核酸中添加硫代磷酸酯键以减少核酸内切酶的攻击。Modifications can also be phosphorothioate replacements. In some cases, native phosphodiester linkages may be susceptible to rapid degradation by cellular nucleases, and; modification of internucleotide linkages using phosphorothioate (PS) linkage substitutes may be more stable to hydrolysis by cellular degradation. Modifications can increase the stability of the polynucleic acid. Modifications can also enhance biological activity. In some cases, the phosphorothioate-enhanced RNA polynucleic acid can inhibit RNase A, RNase T1, calf serum nuclease, or any combination thereof. These properties may allow PS-RNA polynucleic acids to be used in applications with a high potential for exposure to nucleases in vivo or in vitro. For example, phosphorothioate (PS) linkages, which inhibit exonuclease degradation, can be introduced between the last 3-5 nucleotides at the 5' or 3' end of the polynucleic acid. In some cases, phosphorothioate linkages can be added throughout the polynucleic acid to reduce attack by endonucleases.
在另一个实施方案中,对真菌进行遗传修饰包括将(i)包含至少一种核定位信号的至少一种RNA引导的核酸内切酶或编码包含至少一种核定位信号的至少一种RNA引导的核酸内切酶的核酸、(ii)至少一种引导RNA或编码至少一种引导RNA的DNA和任选地(iii)至少一种供体多核苷酸如条形码引入真菌或其细胞中以增加色胺衍生的物质,如二甲基色胺、裸盖菇素或脱磷酸裸盖菇素;并且培养所述真菌或其细胞,使得每种引导RNA将RNA引导的核酸内切酶导向至染色体序列中的靶向位点,其中所述RNA引导的核酸内切酶在所述靶向位点中引入双链断裂,并且通过DNA修复过程修复所述双链断裂,从而修饰所述染色体序列,其中所述靶向位点位于编码甲基转移酶、羟化酶、单加氧酶、激酶、脱羧酶、推定转录调控因子和推定转运蛋白的基因中的任一者中,并且所述染色体修饰中断或干扰所述基因的转录和/或翻译。In another embodiment, genetically modifying the fungus comprises directing (i) at least one RNA-guided endonuclease comprising at least one nuclear localization signal or encoding at least one RNA-guided comprising at least one nuclear localization signal The endonuclease nucleic acid, (ii) at least one guide RNA or DNA encoding at least one guide RNA, and optionally (iii) at least one donor polynucleotide such as a barcode, are introduced into fungi or cells thereof to increase a tryptamine-derived substance, such as dimethyltryptamine, psilocybin, or psilocybin dephosphorylated; and culturing the fungus or cell thereof such that each guide RNA guides an RNA-guided endonuclease to a chromosome A targeting site in a sequence, wherein the RNA-guided endonuclease introduces a double-strand break in the targeting site and repairs the double-strand break through a DNA repair process, thereby modifying the chromosomal sequence, wherein the targeting site is located in any of the genes encoding methyltransferases, hydroxylases, monooxygenases, kinases, decarboxylases, putative transcriptional regulators, and putative transporters, and the chromosomal modification Interrupts or interferes with the transcription and/or translation of the gene.
在一些情况下,可进行GUIDE-Seq分析以确定工程化引导RNA的特异性。通过CRISPR系统核酸酶进行的脱靶裂解的GUIDE-Seq谱分析的一般机制和方案在Tsai,S.等人,“GUIDE-Seq enables genome-wide profiling of off-target cleavage by CRISPRsystem nucleases,”Nature,33:187-197(2015)中进行了论述。为了通过下一代测序评估脱靶频率,可用Cas9 mRNA和引导RNA转染细胞。可在转染后约72小时从经转染细胞中分离基因组DNA,并在潜在脱靶位点进行PCR扩增。可使用威康信托基金会桑格研究所(WellcomeTrust Sanger Institute)基因组编辑数据库(WGE)算法预测潜在脱靶位点。可基于与中靶位点的序列同源性来选择候选脱靶位点。在一些情况下,可使用在gRNA与基因组靶位点之间具有约4个或更少错配的位点。对于每个候选脱靶位点,可设计两个引物对。PCR扩增子可从未处理的(对照)细胞和Cas9/gRNA处理的细胞两者获得。可合并PCR扩增子。可使用TruSeq Nano DNA文库制备试剂盒(Illumina)制备NGS文库。可使用250bp配对末端工作流程在Illumina HiSeq机器上分析样品。在一些情况下,可从每个gRNA文库中获取约4000万个可映射NGS读数。这可相当于对于gRNA的每个候选脱靶位点约450,000个读数的平均数量。在一些情况下,在任何基因组基因座处CRISPR介导的破坏的检测可处于低至0.1%的频率。In some cases, GUIDE-Seq analysis can be performed to determine the specificity of the engineered guide RNA. General mechanism and protocol for GUIDE-Seq profiling of off-target cleavage by CRISPR system nucleases in Tsai, S. et al., "GUIDE-Seq enables genome-wide profiling of off-target cleavage by CRISPR system nucleases," Nature, 33 : 187-197 (2015). To assess off-target frequencies by next-generation sequencing, cells can be transfected with Cas9 mRNA and guide RNA. Genomic DNA can be isolated from transfected cells approximately 72 hours after transfection and PCR amplified at potential off-target sites. Potential off-target sites can be predicted using the Wellcome Trust Sanger Institute Genome Editing Database (WGE) algorithm. Candidate off-target sites can be selected based on sequence homology to the on-target site. In some cases, sites with about 4 or fewer mismatches between the gRNA and the genomic target site can be used. For each candidate off-target site, two primer pairs can be designed. PCR amplicons were obtained from both untreated (control) cells and Cas9/gRNA-treated cells. PCR amplicons can be pooled. NGS libraries can be prepared using the TruSeq Nano DNA Library Prep Kit (Illumina). Samples can be analyzed on an Illumina HiSeq machine using a 250bp paired-end workflow. In some cases, approximately 40 million mappable NGS reads can be obtained from each gRNA library. This may correspond to an average number of about 450,000 reads per candidate off-target site for the gRNA. In some cases, detection of CRISPR-mediated disruption at any genomic locus can be at a frequency as low as 0.1%.
计算预测可用于选择可能是靶向基因的最安全选择的候选gRNA。然后可使用由潜在脱靶位点的计算预测操纵的聚焦方法对候选gRNA进行经验性测试。在一些情况下,对gRNA脱靶安全性的评估可采用下一代深度测序方法以分析通过CRISPR设计工具针对每种gRNA预测的潜在脱靶位点。在一些情况下,可选择与基因组中的任何序列具有少于3个错配的gRNA(完美匹配的预期靶标除外)。在一些情况下,可选择与基因组中的任何序列具有少于50、40、30、20、10、5、4、3、2或1个错配的gRNA。在一些情况下,可使用计算机系统或软件来提供候选gRNA的建议与低脱靶潜力的预测。Computational prediction can be used to select candidate gRNAs that may be the safest choice for targeting genes. Candidate gRNAs can then be empirically tested using a focused approach manipulated by computational prediction of potential off-target sites. In some cases, the assessment of gRNA off-target safety can employ next-generation deep sequencing methods to analyze potential off-target sites predicted for each gRNA by the CRISPR design tool. In some cases, gRNAs can be selected that have fewer than 3 mismatches with any sequence in the genome (except for a perfect match to the intended target). In some cases, gRNAs can be selected that have less than 50, 40, 30, 20, 10, 5, 4, 3, 2, or 1 mismatches with any sequence in the genome. In some cases, computer systems or software can be used to provide suggestions for candidate gRNAs with predictions of low off-target potential.
在一些情况下,可通过以下中的至少一者来鉴定潜在脱靶位点:GUIDE-Seq和靶向PCR扩增以及下一代测序。此外,可对经修饰的细胞(如Cas9/gRNA处理的细胞)进行核型分析,以鉴定任何染色体重排或易位。In some cases, potential off-target sites can be identified by at least one of GUIDE-Seq and targeted PCR amplification and next-generation sequencing. In addition, modified cells (eg, Cas9/gRNA treated cells) can be karyotyped to identify any chromosomal rearrangements or translocations.
可以任何功能浓度引入gRNA。例如,gRNA可以10微克引入细胞。在其它情况下,可引入0.5微克至100微克的gRNA。可引入0.5、5、10、15、20、25、30、35、40、45、50、55、60、65、70、75、80、85、90、95或100微克的gRNA。The gRNA can be introduced at any functional concentration. For example, gRNA can be introduced into cells at 10 micrograms. In other cases, 0.5 micrograms to 100 micrograms of gRNA can be introduced. 0.5, 5, 10, 15, 20, 25, 30, 35, 40, 45, 50, 55, 60, 65, 70, 75, 80, 85, 90, 95 or 100 micrograms of gRNA can be introduced.
引导多核酸可具有任何碱基频率。例如,引导多核酸可具有29As、17Cs、23Gs、23Us、3mGs、1mCs和4mUs。引导多核酸可具有约1至约100个核苷酸。引导多核酸可具有约1至30个单一多核苷酸。引导多核酸可具有约1至10、10至20或20至30个单核苷酸。The guide polynucleic acid can have any base frequency. For example, the guide polynucleic acid can have 29As, 17Cs, 23Gs, 23Us, 3mGs, 1mCs, and 4mUs. The guide polynucleic acid can have from about 1 to about 100 nucleotides. A guide polynucleotide can have about 1 to 30 single polynucleotides. The guide polynucleic acid can have about 1 to 10, 10 to 20, or 20 to 30 single nucleotides.
可在使用前测试引导多核酸的身份和效力。例如,可使用分光光度分析、RNA琼脂糖凝胶分析、LC-MS、内毒素分析和无菌试验中的至少一者来确定身份和效力。在一些情况下,身份测试可确定临床/治疗性使用的可接受水平。例如,可接受的分光光度分析结果可以是在5.0±0.5mg/mL下14±2μL/瓶。可接受的分光光度分析结果也可以是在5.0±0.5mg/mL下约10-20±2μL/瓶或在约3.0至7.0±0.5mg/mL下约10-20±2μL/瓶。引导多核酸的可接受的临床/治疗大小可以是约100个碱基。引导多核酸的临床/治疗大小可以是约5个碱基至约150个碱基。引导多核酸的临床/治疗大小可以是约20个碱基至约150个碱基。引导多核酸的临床/治疗大小可以是约40个碱基至约150个碱基。引导多核酸的临床/治疗大小可以是约60个碱基至约150个碱基。引导多核酸的临床/治疗大小可以是约80个碱基至约150个碱基。引导多核酸的临床/治疗大小可以是约100个碱基至约150个碱基。引导多核酸的临床/治疗大小可以是约110个碱基至约150个碱基。引导多核酸的临床/治疗大小可以是约120个碱基至约150个碱基。The identity and potency of the guide polynucleic acid can be tested prior to use. For example, identity and potency can be determined using at least one of spectrophotometric analysis, RNA sepharose analysis, LC-MS, endotoxin analysis, and sterility testing. In some cases, an identity test can determine acceptable levels for clinical/therapeutic use. For example, an acceptable spectrophotometric analysis result may be 14±2 μL/vial at 5.0±0.5 mg/mL. Acceptable spectrophotometric analysis results can also be about 10-20 ± 2 μL/vial at 5.0 ± 0.5 mg/mL or about 10-20 ± 2 μL/vial at about 3.0 to 7.0 ± 0.5 mg/mL. An acceptable clinical/therapeutic size of the guide polynucleic acid may be about 100 bases. The clinical/therapeutic size of the guide polynucleic acid can be from about 5 bases to about 150 bases. The clinical/therapeutic size of the guide polynucleic acid can be from about 20 bases to about 150 bases. The clinical/therapeutic size of the guide polynucleic acid can be from about 40 bases to about 150 bases. The clinical/therapeutic size of the guide polynucleic acid can be from about 60 bases to about 150 bases. The clinical/therapeutic size of the guide polynucleic acid can be from about 80 bases to about 150 bases. The clinical/therapeutic size of the guide polynucleic acid can be from about 100 bases to about 150 bases. The clinical/therapeutic size of the guide polynucleic acid can be from about 110 bases to about 150 bases. The clinical/therapeutic size of the guide polynucleic acid can be from about 120 bases to about 150 bases.
在一些情况下,可确定引导多核酸的质量。质量可通过LC-MS测定来确定。质量可以是约32,461.0amu。引导多核酸可具有约30,000amu至约50,000amu的质量。引导多核酸可具有约30,000amu至40,000amu、约40,000amu至约50,000amu的质量。质量可以是引导多核酸的钠盐。In some cases, the quality of the guide polynucleic acid can be determined. Mass can be determined by LC-MS measurement. The mass may be about 32,461.0 amu. The guide polynucleic acid can have a mass of about 30,000 amu to about 50,000 amu. The guide polynucleic acid can have a mass of about 30,000 amu to 40,000 amu, about 40,000 amu to about 50,000 amu. The mass can be the sodium salt of the guide polynucleic acid.
在一些情况下,可确定引导多核酸的内毒素水平。临床上/治疗上可接受的内毒素水平可小于3EU/mL。临床上/治疗上可接受的内毒素水平可小于2EU/mL。临床上/治疗上可接受的内毒素水平可小于1EU/mL。临床上/治疗上可接受的内毒素水平可小于0.5EU/mL。In some cases, endotoxin levels of the guide polynucleic acid can be determined. Clinically/therapeutic acceptable endotoxin levels may be less than 3 EU/mL. Clinically/therapeutic acceptable endotoxin levels may be less than 2 EU/mL. Clinically/therapeutic acceptable endotoxin levels may be less than 1 EU/mL. Clinically/therapeutic acceptable endotoxin levels may be less than 0.5 EU/mL.
在一些情况下,引导多核酸可进行无菌试验。无菌试验的临床上/治疗上可接受的水平可以是0或由培养物上无生长表示。无菌试验的临床上/治疗上可接受的水平可以是小于0.5%生长。In some cases, the guide polynucleic acid can be tested for sterility. A clinically/therapeutic acceptable level for sterility testing can be zero or indicated by no growth in culture. A clinically/therapeutic acceptable level for sterility testing may be less than 0.5% growth.
引导多核酸可通过多种方法,例如通过自动化固相合成组装。可使用标准固相DNA/RNA合成构建多核酸。也可使用合成程序构建多核酸。也可手动或以全自动方式合成多核酸。在一些情况下,合成程序可包括5'-羟基寡核苷酸可首先转化为相应的5'-H-膦酸酯单酯,随后在咪唑存在下氧化为激活的5'-phosphorimidazolidate,并且最后在固相载体上与焦磷酸酯反应。此程序可包括合成后的纯化步骤,如PAGE、HPLC、MS或它们的任何组合。Guide polynucleic acids can be assembled by a variety of methods, such as by automated solid phase synthesis. Polynucleic acids can be constructed using standard solid phase DNA/RNA synthesis. Polynucleic acids can also be constructed using synthetic procedures. Polynucleic acids can also be synthesized manually or in a fully automated fashion. In some cases, the synthetic procedure can include that the 5'-hydroxy oligonucleotide can be first converted to the corresponding 5'-H-phosphonate monoester, then oxidized to the activated 5'-phosphorimidazolidate in the presence of imidazole, and finally Reacts with pyrophosphate on a solid support. This procedure may include post-synthesis purification steps such as PAGE, HPLC, MS, or any combination thereof.
供体序列Donor sequence
在一些情况下,可将供体序列引入真菌、酵母、植物或其部分的基因组中。在一些情况下,将供体插入基因组断裂中。在一些方面,供体包含与位于靶序列侧翼的序列的同源性。引入供体序列的方法是本领域技术人员已知的,但可包括使用同源臂。例如,供体序列可包含与包含基因组断裂的基因组的至少一部分的同源臂。在一些情况下,将供体序列随机插入大麻或火麻植物细胞基因组的基因组中。In some cases, the donor sequence can be introduced into the genome of a fungus, yeast, plant or part thereof. In some cases, the donor is inserted into the genome break. In some aspects, the donor comprises homology to sequences flanking the target sequence. Methods of introducing donor sequences are known to those of skill in the art, but may include the use of homology arms. For example, the donor sequence may comprise homology arms to at least a portion of the genome comprising the genomic break. In some cases, the donor sequence is randomly inserted into the genome of the cannabis or hemp plant cell genome.
在一些情况下,可使用同源重组以定点方式引入供体序列。同源重组允许内源性基因中的位点特异性修饰,并且因此可校正遗传性或获得性突变,和/或可将新的改变工程化到基因组中。植物中的同源重组和定点整合在例如美国专利号5,451,513、5,501,967和5,527,695中进行了论述。In some cases, the donor sequence can be introduced in a site-directed fashion using homologous recombination. Homologous recombination allows site-specific modifications in endogenous genes, and thus inherited or acquired mutations can be corrected, and/or new changes can be engineered into the genome. Homologous recombination and site-directed integration in plants are discussed, for example, in US Pat. Nos. 5,451,513, 5,501,967 and 5,527,695.
在一些方面,供体序列包含启动子序列。增加设计的基因产物的表达可通过调节启动子区域或在所需基因序列上游插入更强的启动子来综合地增加表达而实现。在一些方面,可引入在拟南芥和其它植物中具有高度功能性的启动子如35s和Ubi10。在一些情况下,引入在大麻和/或火麻中具有高度功能性的启动子。In some aspects, the donor sequence comprises a promoter sequence. Increased expression of the designed gene product can be achieved by modulating the promoter region or by inserting a stronger promoter upstream of the desired gene sequence to comprehensively increase expression. In some aspects, promoters such as 35s and Ubi10 that are highly functional in Arabidopsis and other plants can be introduced. In some cases, promoters that are highly functional in cannabis and/or hemp are introduced.
在一些情况下,条形码可包含非天然序列。在一些方面,条形码含有天然序列。在一些方面,条形码可用于允许通过基因分型鉴定转基因生物体。在一些方面,供体序列可以是标记物。选择性标记物基因可包括例如光合作用基因(atpB、tscA、psaA/B、petB、petA、ycf3、rpoA、rbcL)、抗生素抗性基因(rrnS、rrnL、aadA、nptII、aphA-6)、除草剂抗性基因(psbA、bar、AHAS(ALS)、EPSPS、HPPD、sul)和代谢基因(BADH、codA、ARG8、ASA2)。来自细菌的sul基因具有除草剂磺胺类药物不敏感的二氢蝶酸合酶活性,并且当使蛋白质产物靶向植物线粒体时可用作选择性标记物(美国专利号US 6121513)。在一些实施方案中,可将编码标记物的序列并入经遗传修饰的细胞或生物体,例如本文所述的真菌、酵母或植物中。在一些实施方案中,可随后从转化的基因组中除去编码标记物的并入序列。在编码标记物的区域之前和之后存在同向重复序列可促进编码标记物的序列的除去。编码标记物的序列的除去可通过细胞器的内源性同源重组系统或通过使用位点特异性重组酶系统(如cre-lox或FLP/FRT)进行。In some cases, barcodes may contain non-native sequences. In some aspects, the barcode contains native sequence. In some aspects, barcodes can be used to allow identification of transgenic organisms by genotyping. In some aspects, the donor sequence can be a marker. Selectable marker genes can include, for example, photosynthesis genes (atpB, tscA, psaA/B, petB, petA, ycf3, rpoA, rbcL), antibiotic resistance genes (rrnS, rrnL, aadA, nptII, aphA-6), herbicidal Drug resistance genes (psbA, bar, AHAS (ALS), EPSPS, HPPD, sul) and metabolic genes (BADH, codA, ARG8, ASA2). The sul gene from bacteria has herbicide sulfonamide-insensitive dihydropteroate synthase activity and can be used as a selectable marker when targeting protein products to plant mitochondria (US Patent No. US 6121513). In some embodiments, sequences encoding markers can be incorporated into genetically modified cells or organisms, such as fungi, yeast, or plants as described herein. In some embodiments, the incorporated sequence encoding the marker can then be removed from the transformed genome. The presence of direct repeats before and after the region encoding the marker can facilitate removal of the sequence encoding the marker. Removal of the sequence encoding the marker can be performed by the organelle's endogenous homologous recombination system or by using a site-specific recombinase system such as cre-lox or FLP/FRT.
在一些情况下,标记物可指能够检测的标记,例如放射性同位素、荧光化合物、生物发光化合物、化学发光化合物、金属螯合剂或酶。可检测标记物的实例包括但不限于以下:荧光标记(例如,FITC、罗丹明、镧系元素磷光体)、酶标记(例如,辣根过氧化物酶、β-半乳糖苷酶、荧光素酶、碱性磷酸酶)、化学发光基团、生物素基团、由二级报告基因识别的预定多肽表位(例如,亮氨酸拉链对序列、二级抗体的结合位点、金属结合结构域、表位标签)。In some cases, a label can refer to a detectable label, such as a radioisotope, fluorescent compound, bioluminescent compound, chemiluminescent compound, metal chelator, or enzyme. Examples of detectable labels include, but are not limited to the following: fluorescent labels (eg, FITC, rhodamine, lanthanide phosphors), enzymatic labels (eg, horseradish peroxidase, beta-galactosidase, luciferin enzymes, alkaline phosphatase), chemiluminescent groups, biotin groups, predetermined polypeptide epitopes recognized by secondary reporter genes (e.g., leucine zipper pair sequences, binding sites for secondary antibodies, metal-binding structures domain, epitope tags).
选择性或可检测标记物通常包含允许通常在特定条件下鉴定细胞或目标细胞内用“标签”标记的分子的DNA区段。此类标记物可编码选自但不限于RNA、肽或蛋白质的产生的活性,或者标记物可为RNA、肽、蛋白质、无机和有机化合物或复合物等提供键合位点。例如,选择性标记物包括但不限于包含限制酶裂解点的DNA区段;包含荧光探针的DNA区段;编码提供对另外有毒的化合物(包括抗生素,例如壮观霉素、氨苄青霉素、卡那霉素、四环素)的抗性的产物的DNA区段;BASTA;新霉素-磷酸转移酶II(NEO)和潮霉素-磷酸转移酶(HPT);编码目标植物靶细胞在自然条件下不具有的产物的DNA区段,例如tRNA基因、营养缺陷型标记物等;编码可容易鉴定的产物的DNA区段,特别是光学可观察到的标记物,例如表型标记物,如-半乳糖苷酶、GUS、荧光蛋白,例如绿色荧光蛋白(GFP)和其它荧光蛋白,例如蓝色(CFP)、黄色(YFP)或红色(RFP)荧光蛋白,以及表面蛋白,其中表现出高荧光强度的那些荧光蛋白特别令人感兴趣,因为如果可分析复杂植物靶结构或植物材料或包含多种类型组织或细胞的植物而不是单个细胞,则这些蛋白质也可在更深的组织层中鉴定;用于PCR的新的引物位点;根据本公开不能通过限制性核酸内切酶或其它DNA修饰的酶或效应结构域修饰的DNA序列的记录;用于特定修饰(例如表观遗传修饰,例如甲基化)的DNA序列;和携带可通过根据本公开的合适CRISPR系统鉴定的PAM基序的DNA序列;以及还有不具有PAM基序,如可天然存在于内源性植物基因组序列中的DNA序列。Selective or detectable labels typically comprise DNA segments that allow the identification of molecules labeled with a "tag" within a cell or target cell, usually under specific conditions. Such labels may encode an activity selected from, but not limited to, the production of RNA, peptides or proteins, or the labels may provide binding sites for RNA, peptides, proteins, inorganic and organic compounds or complexes, and the like. For example, selectable markers include, but are not limited to, DNA segments comprising restriction enzyme cleavage sites; DNA segments comprising fluorescent probes; encoding compounds that provide additional toxicity to compounds (including antibiotics such as spectinomycin, ampicillin, kana DNA segment of the product of resistance to tetracycline, tetracycline); BASTA; neomycin-phosphotransferase II (NEO) and hygromycin-phosphotransferase (HPT); encoding the target plant target cells do not under natural conditions DNA segments with products such as tRNA genes, auxotrophic markers, etc; Glycosidases, GUS, fluorescent proteins such as green fluorescent protein (GFP) and other fluorescent proteins such as blue (CFP), yellow (YFP) or red (RFP) fluorescent proteins, and surface proteins, which exhibit high fluorescence intensity Those fluorescent proteins are of particular interest because they can also be identified in deeper tissue layers if complex plant target structures or plant material or plants containing multiple types of tissues or cells rather than individual cells can be analyzed; for Novel primer sites for PCR; recording of DNA sequences that cannot be modified by restriction endonucleases or other DNA-modifying enzymes or effector domains according to the present disclosure; for specific modifications (e.g., epigenetic modifications, such as methyl and DNA sequences that carry a PAM motif that can be identified by suitable CRISPR systems according to the present disclosure; and also DNA sequences that do not have a PAM motif, such as may naturally occur in endogenous plant genomic sequences .
在一个实施方案中,供体包含可选择、可筛选或可评分标记物基因或其部分。在一些情况下,充当选择或筛选装置的标记物可在可再生的经遗传修饰的生物体中发挥作用以产生将赋予所述生物体中的组织对另外有毒的化合物的抗性的化合物。用作可选择、可筛选或可评分标记物的目标基因将包括但不限于gus;绿色荧光蛋白(gfp);荧光素酶(lux);赋予对诸如卡那霉素(Dekeyser等人,1989)或壮观霉素的抗生素的耐受性的基因(例如壮观霉素氨基糖苷腺苷酰转移酶(aadA);编码给予对诸如草甘膦(例如5-烯醇丙酮酰莽草酸-3-磷酸合酶(EPSPS);草甘膦氧化还原酶(GOX);草甘膦脱羧酶;或草甘膦N-乙酰转移酶(GAT))、茅草枯(例如赋予对2,2-二氯丙酸的耐受性的编码2,2-二氯丙酸脱卤素酶的dehI)、溴苯腈(用于赋予对溴苯腈的耐受性的卤芳基腈水解酶(Bxn))、磺酰基除草剂(例如乙酰羟基酸合酶或乙酰乳酸合酶,赋予对诸如磺酰脲、咪唑啉酮、三唑并嘧啶、嘧啶基氧基苯甲酸酯和苯酞的乙酰乳酸合酶抑制剂的耐受性;编码ALS、GST-II)、双丙氨膦或草丁膦或衍生物(例如赋予对草丁膦或草铵膦、阿特拉津的耐受性的草丁膦乙酰转移酶(bar)(编码GST-III))、麦草畏(麦草畏单加氧酶)或稀禾定(用于赋予对环己二酮(稀禾定)和芳氧基苯氧基丙酸酯(吡氟氯禾灵)的耐受性的经修饰的乙酰辅酶A羧化酶)的除草剂的耐受性的酶的基因等。也可实施其它选择程序,包括阳性选择机制(例如使用大肠杆菌的manA基因,从而允许在甘露糖存在下生长)和双重选择(例如同时使用75-100ppm壮观霉素和3-10ppm草铵膦,或75ppm壮观霉素和0.2-0.25ppm麦草畏)。也可考虑使用浓度为约25-1000ppm,如约150ppm的壮观霉素。在一个实施方案中,可检测标记物可通过各种长度的间隔臂连接以降低潜在位阻。In one embodiment, the donor comprises a selectable, screenable or scoreable marker gene or portion thereof. In some cases, markers that serve as selection or screening devices can function in reproducible genetically modified organisms to produce compounds that will confer resistance to tissues in the organism against otherwise toxic compounds. Genes of interest for use as selectable, screenable or scoreable markers would include, but are not limited to, gus; green fluorescent protein (gfp); luciferase (lux); or spectinomycin antibiotic resistance genes (eg spectinomycin aminoglycoside adenylyltransferase (aadA); coding for administration of a gene that responds to antibiotics such as glyphosate (eg 5-enolpyruvylshikimate-3-phosphate). Enzymes (EPSPS); Glyphosate Oxidoreductase (GOX); Glyphosate Decarboxylase; or Glyphosate N-Acetyltransferase (GAT)), togra (e.g., conferring responsiveness to 2,2-dichloropropionic acid)
在一些情况下,供体多核苷酸包含与位于靶序列侧翼的序列的同源性。在一些情况下,供体多核苷酸将终止密码子引入本文提供的基因中,例如以阻断非裸盖菇素色胺的合成。在一些情况下,供体多核苷酸包含条形码、报告基因或选择标记物。In some cases, the donor polynucleotide comprises homology to sequences flanking the target sequence. In some cases, the donor polynucleotide introduces a stop codon into the genes provided herein, eg, to block the synthesis of non-psilocybin tryptamines. In some cases, the donor polynucleotide comprises a barcode, reporter gene or selectable marker.
转化convert
适当的转化技术可包括但不限于:真菌原生质体的电穿孔;脂质体介导的转化;聚乙二醇(PEG)介导的转化;使用病毒进行的转化;细胞的显微注射;细胞的微粒轰击;真空渗入;和根癌农杆菌介导的转化。转化意指将核苷酸序列以引起所述序列的稳定或瞬时表达的方式引入细胞中。Suitable transformation techniques may include, but are not limited to: electroporation of fungal protoplasts; liposome-mediated transformation; polyethylene glycol (PEG)-mediated transformation; transformation using viruses; microinjection of cells; of microparticle bombardment; vacuum infiltration; and Agrobacterium tumefaciens-mediated transformation. Transforming means introducing a nucleotide sequence into a cell in a manner that results in stable or transient expression of the sequence.
在转化之后,可使用并入转化载体中的显性选择性标记物来选择真菌或其它生物体。在某些实施方案中,此类标记物赋予经转化的真菌或其它生物体抗生素或除草剂抗性,并且可通过将所述真菌或其它生物体暴露于适当浓度的抗生素或除草剂来完成转化体的选择。在选择经转化的真菌或其它生物体并使其生长至成熟后,鉴定表现出经修饰的性状的那些真菌和其它生物体。经修饰的性状可以是上述那些性状中的任一者。此外,本发明的多肽或多核苷酸的表达水平或活性可通过使用RNA印迹、RT-PCR、RNA seq或微阵列分析mRNA表达,或使用免疫印迹或蛋白质印迹或凝胶迁移测定分析蛋白质表达来确定。Following transformation, a dominant selectable marker incorporated into the transformation vector can be used to select for fungi or other organisms. In certain embodiments, such markers confer antibiotic or herbicide resistance to the transformed fungi or other organisms, and transformation can be accomplished by exposing the fungi or other organisms to appropriate concentrations of antibiotics or herbicides body selection. After the transformed fungi or other organisms are selected and grown to maturity, those fungi and other organisms that exhibit modified traits are identified. The modified trait can be any of those traits described above. Furthermore, the expression level or activity of a polypeptide or polynucleotide of the invention can be determined by analyzing mRNA expression using Northern blot, RT-PCR, RNA seq, or microarray, or analyzing protein expression using immunoblotting or Western blotting or gel shift assays. Sure.
用于与本发明一起使用的用于转化真菌或其它细胞的合适方法被认为实际上包括可将DNA引入细胞中的任何方法,如通过直接递送DNA,如通过PEG介导的原生质体转化、通过干燥/抑制介导的DNA摄取、通过电穿孔、通过用碳化硅纤维搅拌、通过农杆菌介导的转化以及通过DNA包被颗粒的加速。尽管应用了诸如这些的技术,但是实际上可稳定地转化任何真菌物种的细胞,并且这些细胞发育成转基因真菌。Suitable methods for transforming fungi or other cells for use with the present invention are considered to include virtually any method by which DNA can be introduced into cells, such as by direct delivery of DNA, such as by PEG-mediated protoplast transformation, by Drying/inhibition-mediated DNA uptake, by electroporation, by stirring with silicon carbide fibers, by Agrobacterium-mediated transformation, and by acceleration of DNA-coated particles. Despite the application of techniques such as these, cells of virtually any fungal species can be stably transformed and developed into transgenic fungi.
农杆菌介导的转化Agrobacterium-mediated transformation
农杆菌介导的转移是用于将基因引入真菌细胞的广泛适用的系统,因为可将DNA引入完整真菌组织中,从而避免从原生质体再生完整植物的需要。使用农杆菌介导的真菌整合载体来将例如包含CRISPR系统或供体序列的DNA引入真菌细胞中是本领域公知的。Agrobacterium-mediated transfer is a widely applicable system for introducing genes into fungal cells because DNA can be introduced into intact fungal tissue, thereby avoiding the need to regenerate intact plants from protoplasts. The use of Agrobacterium-mediated fungal integration vectors to introduce DNA, eg, comprising CRISPR systems or donor sequences, into fungal cells is well known in the art.
此外,农杆菌介导的转化在其它生物体如双子叶植物中可以是有效的,并且可用于转化双子叶植物,包括拟南芥、烟草、番茄、苜蓿和马铃薯。事实上,虽然农杆菌介导的转化已常规用于双子叶植物多年。在一些情况下,农杆菌介导的转化可用于单子叶植物。例如,农杆菌介导的转化技术现已应用于水稻、小麦、大麦、苜蓿和玉米。In addition, Agrobacterium-mediated transformation can be effective in other organisms such as dicots, and can be used to transform dicots, including Arabidopsis, tobacco, tomato, alfalfa, and potato. In fact, although Agrobacterium-mediated transformation has been routinely used in dicots for many years. In some cases, Agrobacterium-mediated transformation can be used in monocotyledonous plants. For example, Agrobacterium-mediated transformation techniques are now used in rice, wheat, barley, alfalfa, and maize.
现代农杆菌转化载体能够在大肠杆菌以及农杆菌中复制,从而允许如所描述的方便操作。此外,用于农杆菌介导的基因转移的载体的最新技术进步改进了载体中基因和限制性位点的排列,以促进能够表达各种多肽编码基因的载体的构建。在一些方面,载体可具有方便的多接头区域,所述多接头区域侧接启动子和聚腺苷酸化位点以用于直接表达插入的多肽编码基因并且适用于本文所述的目的。此外,含有武装的(armed)和解除的(disarmed)Ti基因的农杆菌可用于转化。Modern Agrobacterium transformation vectors are capable of replicating in E. coli as well as in Agrobacterium, allowing convenient manipulation as described. In addition, recent technological advances in vectors for Agrobacterium-mediated gene transfer have improved the arrangement of genes and restriction sites in the vector to facilitate the construction of vectors capable of expressing various polypeptide-encoding genes. In some aspects, the vector may have a convenient polylinker region flanking a promoter and polyadenylation sites for direct expression of the inserted polypeptide-encoding gene and suitable for the purposes described herein. In addition, Agrobacterium containing both armed and disarmed Ti genes can be used for transformation.
电穿孔electroporation
在一些方面,可使用电穿孔来修饰真菌、酵母、植物或其细胞。为了通过电穿孔进行转化,可使用易碎组织,如细胞或胚性愈伤组织的悬浮培养物,或者可替代地可直接转化未成熟胚或其它有组织的组织。在这项技术中,将部分降解所选细胞的细胞壁,这通过使它们暴露于果胶降解酶(果胶裂解酶)或以受控方式机械损伤进行。In some aspects, electroporation can be used to modify fungi, yeast, plants, or cells thereof. For transformation by electroporation, fragile tissues such as suspension cultures of cells or embryogenic callus can be used, or alternatively immature embryos or other organized tissues can be transformed directly. In this technique, the cell walls of selected cells will be partially degraded, either by exposing them to pectin-degrading enzymes (pectin lyases) or by mechanical damage in a controlled manner.
可使用任何转染系统。在一些情况下,可使用Neon转染系统。Neon系统可以是三组件电穿孔仪,其包括中央控制模块、可通过3英尺长的电线连接至中央控制模块的电穿孔室和专用移液器。在一些情况下,专用移液器可配备有可更换和/或一次性无菌尖端。在一些情况下,电穿孔室可配备有可更换/一次性无菌电穿孔比色皿。在一些情况下,可用GMP合格的溶液和缓冲液替代由系统(如Neon系统)的制造商提供的标准电穿孔缓冲液。在一些情况下,可用GMP级磷酸盐缓冲盐水(PBS)替代标准电穿孔缓冲液。在开始样品电穿孔之前,可对控制模块执行自诊断系统检查,以确保Neon系统正常运行。在一些情况下,可在cGMP设施中的10,000级洁净室内的1,000级生物安全柜中进行转染。在一些情况下,可改变电穿孔脉冲电压以优化转染效率和/或细胞活力。在一些情况下,可改变电穿孔脉冲宽度以优化转染效率和/或细胞活力。在一些情况下,可改变电穿孔脉冲数以优化转染效率和/或细胞活力。在一些情况下,电穿孔可包括单脉冲。在一些情况下,电穿孔可包括多于一个脉冲。在一些情况下,电穿孔可包括2个脉冲、3个脉冲、4个脉冲、5个脉冲、6个脉冲、7个脉冲、8个脉冲、9个脉冲或10个或更多个脉冲。Any transfection system can be used. In some cases, the Neon Transfection System can be used. The Neon system can be a three-component electroporation machine that includes a central control module, an electroporation chamber that can be connected to the central control module by a 3-foot cord, and a dedicated pipette. In some cases, specialized pipettes may be equipped with replaceable and/or disposable sterile tips. In some cases, the electroporation chamber can be equipped with replaceable/disposable sterile electroporation cuvettes. In some cases, standard electroporation buffers provided by the manufacturer of the system (eg, the Neon system) can be replaced with GMP-qualified solutions and buffers. In some cases, standard electroporation buffers can be replaced with GMP grade phosphate buffered saline (PBS). Before beginning sample electroporation, a self-diagnostic system check can be performed on the control module to ensure proper functioning of the Neon system. In some cases, transfection can be performed in a class 1,000 biosafety cabinet in a class 10,000 cleanroom in a cGMP facility. In some cases, the electroporation pulse voltage can be varied to optimize transfection efficiency and/or cell viability. In some cases, the electroporation pulse width can be varied to optimize transfection efficiency and/or cell viability. In some cases, the number of electroporation pulses can be varied to optimize transfection efficiency and/or cell viability. In some cases, electroporation can include a single pulse. In some cases, electroporation may include more than one pulse. In some cases, electroporation can include 2 pulses, 3 pulses, 4 pulses, 5 pulses, 6 pulses, 7 pulses, 8 pulses, 9 pulses, or 10 or more pulses.
在一些方面,真菌和/或植物的原生质体可用于电穿孔转化。In some aspects, fungal and/or plant protoplasts can be used for electroporation transformation.
微粒轰击particle bombardment
根据本发明用于将转化DNA区段递送至真菌细胞和源自其它生物体的细胞的另一种方法是微粒轰击。在这种方法中,颗粒可用核酸包被并通过推进力递送至细胞中。示例性颗粒包括含有钨、铂且优选金的那些颗粒。考虑在一些情况下,DNA沉淀到金属颗粒上对于使用微粒轰击将DNA递送至受体细胞将不是必要的。然而,考虑颗粒可含有DNA而不是被DNA包被。在一些方面,DNA包被的颗粒可通过粒子轰击增加DNA递送的水平。对于轰击,将悬浮的细胞在过滤器或固体培养基上浓缩。可替代地,可将未成熟胚或其它靶细胞排列在固体培养基上。待轰击的细胞位于微粒挡板下方的适当距离处。Another method for delivering transforming DNA segments to fungal cells and cells derived from other organisms according to the present invention is microprojectile bombardment. In this approach, particles can be coated with nucleic acid and delivered into cells by propulsion. Exemplary particles include those containing tungsten, platinum, and preferably gold. It is contemplated that in some cases, precipitation of DNA onto metal particles will not be necessary for delivery of DNA to recipient cells using microprojectile bombardment. However, it is contemplated that the particles may contain DNA rather than be coated with DNA. In some aspects, DNA-coated particles can increase the level of DNA delivery by particle bombardment. For bombardment, cells in suspension are concentrated on filters or solid medium. Alternatively, immature embryos or other target cells can be arrayed on solid medium. The cells to be bombarded are located at an appropriate distance below the particle barrier.
通过加速将DNA递送至真菌物细胞中的方法的说明性实施方案是生物射弹粒子递送系统,所述系统可用于推动用DNA包被的颗粒或细胞通过筛网(如不锈钢或Nytex筛网)到覆盖有悬浮培养的单子叶植物细胞的过滤器表面上。筛网使颗粒分散,以使得它们不会以大的聚集体形式递送至受体细胞。An illustrative embodiment of a method of accelerating DNA delivery into fungal cells is a biolistic particle delivery system that can be used to propel DNA-coated particles or cells through a mesh (eg, stainless steel or Nytex mesh) onto a filter surface covered with suspension-cultured monocot cells. The mesh disperses the particles so that they are not delivered to recipient cells as large aggregates.
其它转化方法Other transformation methods
其它转化方法包括但不限于磷酸钙沉淀、聚乙二醇处理、电穿孔以及这些处理的组合。Other transformation methods include, but are not limited to, calcium phosphate precipitation, polyethylene glycol treatment, electroporation, and combinations of these treatments.
为了转化不能从原生质体成功再生的真菌,可使用将DNA引入完整细胞或组织中的其它方式。例如,从未成熟胚或外植体再生植物可如所述实现。此外,碳化硅纤维介导的转化可在有或没有原生质体的情况下使用。使用这种技术的转化可通过将碳化硅纤维与细胞一起在DNA溶液中搅拌来完成。当细胞被刺穿时,DNA被动地进入。To transform fungi that cannot successfully regenerate from protoplasts, other means of introducing DNA into intact cells or tissues can be used. For example, regeneration of plants from immature embryos or explants can be accomplished as described. Additionally, silicon carbide fiber-mediated transformation can be used with or without protoplasts. Transformation using this technique can be accomplished by stirring the silicon carbide fibers together with the cells in a DNA solution. When the cell is punctured, the DNA enters passively.
在一些情况下,可改变用于基因组编辑的起始细胞密度以优化编辑效率和/或细胞活力。在一些情况下,用于基因组编辑的起始细胞密度可小于约1x105个细胞。在一些情况下,用于电穿孔的起始细胞密度可以是至少约1x105个细胞、至少约2x105个细胞、至少约3x105个细胞、至少约4x105个细胞、至少约5x105个细胞、至少约6x105个细胞、至少约7x105个细胞、至少约8x105个细胞、至少约9x105个细胞、至少约1x106个细胞、至少约1.5x106个细胞、至少约2x106个细胞、至少约2.5x106个细胞、至少约3x106个细胞、至少约3.5x106个细胞、至少约4x106个细胞、至少约4.5x106个细胞、至少约5x106个细胞、至少约5.5x106个细胞、至少约6x106个细胞、至少约6.5x106个细胞、至少约7x106个细胞、至少约7.5x106个细胞、至少约8x106个细胞、至少约8.5x106个细胞、至少约9x106个细胞、至少约9.5x106个细胞、至少约1x107个细胞、至少约1.2x107个细胞、至少约1.4x107个细胞、至少约1.6x107个细胞、至少约1.8x107个细胞、至少约2x107个细胞、至少约2.2x107个细胞、至少约2.4x107个细胞、至少约2.6x107个细胞、至少约2.8x107个细胞、至少约3x107个细胞、至少约3.2x107个细胞、至少约3.4x107个细胞、至少约3.6x107个细胞、至少约3.8x107个细胞、至少约4x107个细胞、至少约4.2x107个细胞、至少约4.4x107个细胞、至少约4.6x107个细胞、至少约4.8x107个细胞或至少约5x107个细胞。In some cases, the starting cell density for genome editing can be varied to optimize editing efficiency and/or cell viability. In some cases, the starting cell density for genome editing can be less than about1 x 105 cells. In some cases, the starting cell density for electroporation can be at least about1x105 cells, at least about2x105 cells, at least about3x105 cells, at least about4x105 cells, at least about5x105 cells , at least about6x105 cells, at least about7x105 cells, at least about8x105 cells, at least about9x105 cells, at least about1x106 cells, at least about1.5x106 cells, at least about2x106 cells , at least about2.5x10 cells, at least about 3x10 cells, at least about3.5x10 cells, at least about4x10 cells, at least about4.5x10 cells, at least about5x10 cells, at least about5.5x106 cells, at least about6x106 cells, at least about6.5x106 cells, at least about7x106 cells, at least about7.5x106 cells, at least about8x106 cells, at least about8.5x106 cells, at least about about9x10 cells, at least about9.5x10 cells, at least about 1x10 cells, at least about1.2x10 cells, at least about1.4x10 cells, at least about1.6x10 cells, at least about1.8x10cells cells, at least about 2x10 cells, at least about2.2x10 cells, at least about2.4x10 cells, at least about2.6x10 cells, at least about2.8x10 cells, at least about3x10cells , at least about about 3.2x10 cells, at least about3.4x10 cells, at least about3.6x10 cells, at least about3.8x10 cells, at least about4x10 cells, at least about4.2x10 cells, at least about4.4x107 cells, at least about4.6x107 cells, at least about4.8x107 cells, or at least about5x107 cells.
使用本文所述的任何核酸递送平台,植物或其任何部分(包括但不限于细胞)的基因组破坏的效率可导致如通过核酸或蛋白质分析测量的基因或其部分的约20%、25%、30%、35%、40%、45%、50%、55%、60%、65%、70%、75%、80%、85%、90%、91%,92%、93%、94%、95%、96%、97%、98%、99%、99.5%、99.9%或高达约100%破坏。Using any of the nucleic acid delivery platforms described herein, the efficiency of genome disruption of a plant or any part thereof (including but not limited to a cell) can result in about 20%, 25%, 30% of the gene or part thereof as measured by nucleic acid or protein analysis. %, 35%, 40%, 45%, 50%, 55%, 60%, 65%, 70%, 75%, 80%, 85%, 90%, 91%, 92%, 93%, 94%, 95%, 96%, 97%, 98%, 99%, 99.5%, 99.9% or up to about 100% failure.
生物体育种biological species
在一些实施方案中,本公开的真菌、酵母或植物可用于产生新的植物品种。在一些实施方案中,所述植物用于开发具有所需表型的新的、独特的且优良的品种或杂种。在一些实施方案中,选择方法(例如分子标记物辅助选择)可与育种方法组合以加速所述过程。在一些实施方案中,方法包括(i)将本文提供的包含表达盒的任何生物体作为供体与受体生物体品系杂交以产生FI群体;(ii)选择具有表达盒的后代。任选地,可通过测试目标基因的表达来进一步选择后代。在一些实施方案中,转移供体生物体的完整染色体。例如,具有表达盒的转基因生物体可充当异花授粉中的父本或母本,以通过从供体接受转基因来产生后代,从而产生具有表达盒的后代。在用于产生具有表达盒的生物体的方法中,原生质体融合也可用于将转基因从供体转移至受体。原生质体融合是两个或更多个原生质体(通过酶处理除去细胞壁的细胞)之间的诱导或自发结合,如体细胞杂交,以产生单个双核或多核细胞。将甚至可用在自然界中不能混种的物种获得的融合细胞组织培养成表现出合乎需要的性状组合的杂种生物体。更具体地,可从具有表达盒的生物体获得第一原生质体。可从第二生物体,任选地从另一种物种或品种,或从同一物种或品种获得第二原生质体,所述物种或品种包含商业上合乎需要的特征,如但不限于抗病性、抗虫性等。然后使用本领域已知的传统原生质体融合程序使所述原生质体融合以产生杂交。可替代地,胚挽救可用于将表达盒从供体转移至受体。胚挽救可用作分离胚和对所述胚进行组织培养的程序。In some embodiments, the fungi, yeasts or plants of the present disclosure can be used to generate new plant species. In some embodiments, the plants are used to develop new, unique and elite varieties or hybrids with a desired phenotype. In some embodiments, selection methods (eg, molecular marker-assisted selection) can be combined with breeding methods to expedite the process. In some embodiments, the method comprises (i) crossing any of the organisms provided herein comprising an expression cassette as a donor with a recipient organism strain to generate a population of FI; (ii) selecting progeny having the expression cassette. Optionally, progeny can be further selected by testing the expression of the gene of interest. In some embodiments, the complete chromosome of the donor organism is transferred. For example, a transgenic organism with an expression cassette can serve as the male or female parent in cross-pollination to produce offspring by receiving the transgene from a donor, thereby producing offspring with the expression cassette. In methods for generating organisms with expression cassettes, protoplast fusion can also be used to transfer transgenes from a donor to a recipient. Protoplast fusion is the induced or spontaneous association, such as somatic hybridization, between two or more protoplasts (cells whose cell walls have been removed by enzymatic treatment) to produce a single binucleated or multinucleated cell. Fusion cells obtained even from species that do not interbreed in nature can be tissue cultured into hybrid organisms that exhibit a desirable combination of traits. More specifically, the first protoplast can be obtained from an organism having an expression cassette. A second protoplast can be obtained from a second organism, optionally from another species or variety, or from the same species or variety, which species or variety contains commercially desirable characteristics, such as, but not limited to, disease resistance , insect resistance, etc. The protoplasts are then fused to produce a hybrid using conventional protoplast fusion procedures known in the art. Alternatively, embryo rescue can be used to transfer the expression cassette from the donor to the recipient. Embryos rescue can be used as a procedure for isolating embryos and subjecting them to tissue culture.
在一些情况下,可使用群体改良方法。群体改良方法自然分为两类,基于纯粹表型选择的那些(通常称为混合选择)和基于用后代测试进行选择的那些。群体间改良利用开放育种群体的概念;从而允许基因从一个群体流向另一个群体。通过从两种来源分离包含合乎需要的性状的植物,可应用选择来改良一个(或有时两个)群体。In some cases, population improvement methods may be used. Population improvement methods naturally fall into two categories, those based on purely phenotypic selection (often referred to as mixed selection) and those based on selection with progeny testing. Interpopulation improvement exploits the concept of an open breeding population; thereby allowing genes to flow from one population to another. Selection can be applied to improve one (or sometimes both) populations by isolating plants containing desirable traits from both sources.
在另一方面,可利用混合选择。在混合选择中,选择、收获合乎需要的个体植物,并在没有后代测试的情况下使种子复合以产生下一代。由于选择仅基于母本,并且不存在对授粉的控制,因此混合选择相当于随机交配与选择形式。如本文所述,混合选择的目的是增加优良基因型在群体中的比例。虽然有时使用混合选择,但多杂交通常优选后代测试,因为它们操作简单并且与目标明显相关,即在合成物中利用一般配合力。On the other hand, hybrid options are available. In mixed selection, desired individual plants are selected, harvested, and seed compounded to produce the next generation without progeny testing. Since selection is based only on the female parent and there is no control over pollination, mixed selection is equivalent to a form of random mating and selection. As described herein, the purpose of mixed selection is to increase the proportion of superior genotypes in the population. Although mixed selection is sometimes used, multiple crosses are usually preferred for progeny tests because they are simple to perform and clearly related to the goal of utilizing general combining ability in the composition.
在一些实施方案中,育种可利用分子标记物。基于本申请的植物的基因组设计和制造分子标记物。在一些实施方案中,分子标记物选自同工酶电泳、限制性片段长度多态性(RFLP)、随机扩增多态性DNA(RAPD)、任意引物聚合酶链反应(AP-PCR)、DNA扩增指纹分析(DAF)、特征序列扩增区域(SCAR)。扩增片段长度多态性(AFLP)和简单序列重复序列(SSR),其也称为微卫星等。开发分子标记物的方法及其应用由Avise(Molecular markers,natural history,and evolution,Publisher:Sinauer Associates,2004,ISBN0878930418,9780878930418)、Snvastava等人(Plant biotechnology and molecularmarkers,Publisher:Springer,2004,ISBN1402019114,9781402019111)和Vienne(Molecular markers in plant genetics and biotechnology,Publisher:SciencePublishers,2003)描述,所述文献出于所有目的各自以引用的方式整体并入。分子标记物可用于分子标记物辅助育种。In some embodiments, molecular markers can be utilized for breeding. Molecular markers are designed and manufactured based on the genomes of the plants of the present application. In some embodiments, the molecular marker is selected from isoenzyme electrophoresis, restriction fragment length polymorphism (RFLP), random amplified polymorphic DNA (RAPD), arbitrary primer polymerase chain reaction (AP-PCR), DNA Amplification Fingerprint Analysis (DAF), Signature Sequence Amplification Region (SCAR). Amplified fragment length polymorphisms (AFLPs) and simple sequence repeats (SSRs), which are also known as microsatellites and the like. Methods for developing molecular markers and their applications were developed by Avise (Molecular markers, natural history, and evolution, Publisher: Sinauer Associates, 2004, ISBN0878930418, 9780878930418), Snvastava et al. (Plant biotechnology and molecularmarkers, Publisher: Springer, 2004, ISBN1402019114, 9781402019111) and Vienne (Molecular markers in plant genetics and biotechnology, Publisher: Science Publishers, 2003), each of which is incorporated by reference in its entirety for all purposes. Molecular markers can be used in molecular marker-assisted breeding.
本文提供的还可以是用于产生转基因真菌的方法。在一些方面,本文提供的方法可包括(a)使真菌细胞与核酸内切酶或编码核酸内切酶的多肽接触。在一些情况下,核酸内切酶在真菌细胞的基因组中引入遗传修饰,所述遗传修饰导致式I-IV、其衍生物或类似物的量与没有遗传修饰的可比对照中所述相同化合物的量相比增加。在一些方面,方法还可包括培养已如前所述进行遗传修饰的真菌细胞以产生转基因真菌。制造转基因真菌的方法可包括电穿孔、农杆菌介导的转化、生物射弹粒子轰击或原生质体转化。在一些方面,方法还可包括培养真菌细胞以产生真菌。Also provided herein are methods for producing transgenic fungi. In some aspects, the methods provided herein can include (a) contacting a fungal cell with an endonuclease or a polypeptide encoding an endonuclease. In some cases, the endonuclease introduces a genetic modification in the genome of a fungal cell that results in an amount of formula I-IV, a derivative or analog thereof, that is the same as the amount of the same compound described in a comparable control without the genetic modification amount increased. In some aspects, the methods may further comprise culturing the fungal cells that have been genetically modified as previously described to produce transgenic fungi. Methods of making transgenic fungi may include electroporation, Agrobacterium-mediated transformation, biolistic particle bombardment, or protoplast transformation. In some aspects, the method may further comprise culturing the fungal cells to produce the fungus.
在一些方面,本文提供的还可以是用于产生转基因植物的方法,所述方法包括使植物细胞与核酸内切酶或编码核酸内切酶的多肽接触。核酸内切酶可引入遗传修饰,所述遗传修饰导致裸盖菇素、脱磷酸裸盖菇素或二甲基色胺(DMT)、其衍生物或类似物的量与没有遗传修饰的可比对照中所述相同化合物的量相比增加。Also provided herein, in some aspects, are methods for producing transgenic plants comprising contacting plant cells with an endonuclease or a polypeptide encoding an endonuclease. Endonucleases can introduce genetic modifications that result in amounts of psilocybin, dephosphorylated psilocybin, or dimethyltryptamine (DMT), derivatives or analogs thereof, compared to controls without genetic modification The amount of the same compound described in increases compared to .
在一些方面,本文提供的还可以是用于产生转基因动物的方法,所述方法包括使动物细胞与核酸内切酶或编码核酸内切酶的多肽接触。核酸内切酶可引入遗传修饰,所述遗传修饰导致裸盖菇素、脱磷酸裸盖菇素或二甲基色胺(DMT)、其衍生物或类似物的量与没有遗传修饰的可比对照中所述相同化合物的量相比增加。Also provided herein, in some aspects, are methods for producing a transgenic animal comprising contacting an animal cell with an endonuclease or a polypeptide encoding an endonuclease. Endonucleases can introduce genetic modifications that result in amounts of psilocybin, dephosphorylated psilocybin, or dimethyltryptamine (DMT), derivatives or analogs thereof, compared to controls without genetic modification The amount of the same compound described in increases compared to .
在一些方面,本文提供的还可以是用于产生转基因昆虫的方法,所述方法包括使昆虫细胞与核酸内切酶或编码核酸内切酶的多肽接触。核酸内切酶可引入遗传修饰,所述遗传修饰导致裸盖菇素、脱磷酸裸盖菇素或二甲基色胺(DMT)、其衍生物或类似物的量与没有遗传修饰的可比对照中所述相同化合物的量相比增加。Also provided herein, in some aspects, are methods for producing transgenic insects, the methods comprising contacting insect cells with an endonuclease or a polypeptide encoding an endonuclease. Endonucleases can introduce genetic modifications that result in amounts of psilocybin, dephosphorylated psilocybin, or dimethyltryptamine (DMT), derivatives or analogs thereof, compared to controls without genetic modification The amount of the same compound described in increases compared to .
在一些方面,本文提供的还可以是用于产生转基因酵母的方法,所述方法包括使酵母细胞与核酸内切酶或编码核酸内切酶的多肽接触。核酸内切酶可引入遗传修饰,所述遗传修饰导致裸盖菇素、脱磷酸裸盖菇素或二甲基色胺(DMT)、其衍生物或类似物的量与没有遗传修饰的可比对照中所述相同化合物的量相比增加。Also provided herein, in some aspects, are methods for producing transgenic yeast comprising contacting a yeast cell with an endonuclease or a polypeptide encoding an endonuclease. Endonucleases can introduce genetic modifications that result in amounts of psilocybin, dephosphorylated psilocybin, or dimethyltryptamine (DMT), derivatives or analogs thereof, compared to controls without genetic modification The amount of the same compound described in increases compared to .
在一些方面,本文提供的还可以是用于产生转基因大肠杆菌的方法,所述方法包括使大肠杆菌细胞与核酸内切酶或编码核酸内切酶的多肽接触。核酸内切酶可引入遗传修饰,所述遗传修饰导致裸盖菇素、脱磷酸裸盖菇素或二甲基色胺(DMT)、其衍生物或类似物的量与没有遗传修饰的可比对照中所述相同化合物的量相比增加。Also provided herein, in some aspects, are methods for producing transgenic E. coli comprising contacting an E. coli cell with an endonuclease or a polypeptide encoding an endonuclease. Endonucleases can introduce genetic modifications that result in amounts of psilocybin, dephosphorylated psilocybin, or dimethyltryptamine (DMT), derivatives or analogs thereof, compared to controls without genetic modification The amount of the same compound described in increases compared to .
包括真菌细胞基因组的修饰的方法可导致:与没有基因组修饰的可比对照相比,转基因真菌中按干重测量的多5%、10%、15%、20%、25%、30%、35%、40%、45%、50%、55%、60%、65%、70%、75%或高达约80%的(式IV)。包括修饰的方法还可导致与没有修饰的可比对照相比,转基因真菌中按干重测量的多约1%、5%、10%、15%、20%、25%、30%、35%、40%、45%、50%、55%、60%、65%、70%、80%、90%、100%或高达约200%的(式I)。此外,包括修饰的方法还可导致与没有修饰的可比对照相比,转基因真菌中按干重测量的多约1%、5%、10%、15%、20%、25%、30%、35%、40%、45%、50%、55%、60%、65%、70%、80%、90%、100%或高达约200%的裸盖菇素或脱磷酸裸盖菇素。A method involving modification of the fungal cell genome results in: 5%, 10%, 15%, 20%, 25%, 30%, 35% more measured by dry weight in transgenic fungi compared to a comparable control without the genome modification , 40%, 45%, 50%, 55%, 60%, 65%, 70%, 75% or up to about 80% (Formula IV). Methods including modifications can also result in about 1%, 5%, 10%, 15%, 20%, 25%, 30%, 35%, 30%, 35% more, measured by dry weight, in the transgenic fungus compared to a comparable control without the modification. 40%, 45%, 50%, 55%, 60%, 65%, 70%, 80%, 90%, 100% or up to about 200% (Formula I). In addition, methods including modifications can also result in about 1%, 5%, 10%, 15%, 20%, 25%, 30%, 35% more measured by dry weight in transgenic fungi compared to comparable controls without modification %, 40%, 45%, 50%, 55%, 60%, 65%, 70%, 80%, 90%, 100% or up to about 200% psilocybin or dephosphorylated psilocybin.
本文提供的还可以是包含基因的破坏的经遗传修饰的细胞,所述破坏导致化合物(式IV)、其衍生物或类似物的量与没有所述遗传修饰的可比对照细胞中所述相同化合物的量相比增加。此外,本文提供的还可以是包含基因的破坏的经遗传修饰的细胞,所述破坏导致化合物(式I)、其衍生物或类似物的量与没有所述遗传修饰的可比对照细胞中所述相同化合物的量相比增加。此外,本文提供的还可以是包含基因的破坏的经遗传修饰的细胞,所述破坏导致裸盖菇素和/或脱磷酸裸盖菇素、其衍生物或类似物的量与没有所述遗传修饰的可比对照细胞中所述相同化合物的量相比增加。可替代地,经遗传修饰的细胞是植物细胞、真菌细胞、细菌细胞、动物细胞或昆虫细胞。Also provided herein can be genetically modified cells comprising disruption of a gene that results in a compound The amount of (Formula IV), a derivative or analog thereof, is increased compared to the amount of the same compound in a comparable control cell without the genetic modification. In addition, provided herein can also be genetically modified cells comprising disruption of a gene that results in a compound The amount of (Formula I), a derivative or analog thereof, is increased compared to the amount of the same compound in a comparable control cell without the genetic modification. In addition, provided herein can also be genetically modified cells comprising disruption of a gene that results in psilocybin and/or psilocybin dephosphorylated psilocybin, derivatives or analogs thereof in amounts comparable to those without the genetic The amount of the same compound in the modified comparable control cells is increased compared to that of the control cells. Alternatively, the genetically modified cells are plant cells, fungal cells, bacterial cells, animal cells or insect cells.
另外,本文提供的还可以是包含核酸内切酶或编码能够引入遗传修饰的所述核酸内切酶的多核苷酸的组合物,其中所述遗传修饰导致与没有所述遗传修饰的可比对照细胞相比,裸盖菇素或脱磷酸裸盖菇素、它们的衍生物或类似物的量增加。Additionally, provided herein can also be compositions comprising an endonuclease or a polynucleotide encoding the endonuclease capable of introducing a genetic modification, wherein the genetic modification results in a control cell comparable to a control cell without the genetic modification In comparison, the amount of psilocybin or dephosphorylated psilocybin, their derivatives or analogs is increased.
裸盖菇素合成基因转基因方法和组合物Method and composition for transgenic psilocybin synthesis gene
本文提供的可以是用裸盖菇素合成基因转化蘑菇的方法。在一些实施方案中,合成4种主要裸盖菇素合成基因的编码序列并克隆到在35S启动子控制下的过表达载体系统pGWB5中。在一些实施方案中,还产生了具有驱动这些基因的表达的不同启动子(包括Gpd、EF1a和肌动蛋白)的另外载体。Provided herein may be a method of transforming mushrooms with a psilocybin synthesis gene. In some embodiments, the coding sequences for the four major psilocybin synthesis genes are synthesized and cloned into the overexpression vector system pGWB5 under the control of the 35S promoter. In some embodiments, additional vectors with different promoters (including Gpd, EF1a, and actin) driving the expression of these genes are also generated.
在一些情况下,使用pGWB5转化担子菌纲真菌,以测试转化效率并制定方案。在一些情况下,转化包括单独和组合的不同Psi基因,以观察裸盖菇素产生增加的潜力。在一些情况下,产生并测试多顺反子载体内串联的四种Psi基因的一体化表达载体。In some cases, pGWB5 was used to transform Basidiomycete fungi to test transformation efficiency and develop protocols. In some cases, transformations included different Psi genes, alone and in combination, to see the potential for increased psilocybin production. In some cases, an integrated expression vector of four Psi genes in tandem within a polycistronic vector was generated and tested.
在一些实施方案中,能够在不同的底物上繁殖和生长古巴裸盖菇,以产生成熟的结实蘑菇和菌丝体。在一些实施方案中,从蘑菇菌褶中提取组织并通过农杆菌介导的转化来转化Psi基因。在一些实施方案中,由菌丝体产生原生质体,并且进行PEG介导的Psi基因转化以及农杆菌介导的菌丝体转化。在一些实施方案中,使古巴裸盖菇在室温下在PDA琼脂或大麦-珍珠岩堆肥中生长7天。在一些情况下,在转化前收获菌丝体和子实体以用于组织提取和细胞分离。In some embodiments, psilocybin can be propagated and grown on different substrates to produce mature fruity mushrooms and mycelium. In some embodiments, tissue is extracted from mushroom gills and the Psi gene is transformed by Agrobacterium-mediated transformation. In some embodiments, protoplasts are produced from mycelium, and PEG-mediated Psi gene transformation and Agrobacterium-mediated mycelium transformation are performed. In some embodiments, psilocybin is grown in PDA agar or barley-perlite compost for 7 days at room temperature. In some cases, mycelium and fruiting bodies are harvested for tissue extraction and cell isolation prior to transformation.
在一些实施方案中,Psi基因过表达是在两种不同启动子类型(35S启动子、广泛使用的植物过表达启动子)和两种真菌特异性过表达启动子GPD和CcDED1的控制下(表4,图3,图4)。In some embodiments, Psi gene overexpression is under the control of two different promoter types (35S promoter, the widely used plant overexpression promoter) and two fungal specific overexpression promoters, GPD and CcDED1 (Table 1). 4, Figure 3, Figure 4).
表4.基因表达载体Table 4. Gene Expression Vectors
在一些实施方案中,PsiD基因过表达包括在35S启动子控制下表达PsiD基因的载体(表5:SEQ ID NO:18,17,647bp;图3A)。在一些实施方案中,PsiH基因过表达包括在35S启动子控制下表达PsiH基因的载体(表5:SEQ ID NO:17,18,494bp;图3B)。在一些实施方案中,PsiK基因过表达包括在35S启动子控制下表达PsiK基因的载体(表5:SEQ ID NO:16,17,420bp;图3C)。在一些实施方案中,PsiM基因过表达包括在35S启动子控制下表达PsiM基因的载体(表5:SEQ ID NO:15,17,267bp;图3D)。In some embodiments, PsiD gene overexpression comprises a vector expressing the PsiD gene under the control of the 35S promoter (Table 5: SEQ ID NO: 18, 17,647 bp; Figure 3A). In some embodiments, PsiH gene overexpression comprises a vector expressing the PsiH gene under the control of the 35S promoter (Table 5: SEQ ID NO: 17, 18,494 bp; Figure 3B). In some embodiments, PsiK gene overexpression comprises a vector expressing the PsiK gene under the control of the 35S promoter (Table 5: SEQ ID NO: 16, 17,420 bp; Figure 3C). In some embodiments, PsiM gene overexpression comprises a vector expressing the PsiM gene under the control of the 35S promoter (Table 5: SEQ ID NO: 15, 17,267 bp; Figure 3D).
在一些实施方案中,Psi基因过表达包括在GcDED1启动子控制下表达Psi基因的载体(表5:SEQ ID NO:19,9,462bp;图4A)。在一些实施方案中,Psi基因过表达包括在GPD启动子控制下表达Psi基因的载体(表5:SEQ ID NO:20,8,067bp;图4B)。In some embodiments, Psi gene overexpression comprises a vector expressing the Psi gene under the control of the GcDED1 promoter (Table 5: SEQ ID NO: 19, 9,462 bp; Figure 4A). In some embodiments, Psi gene overexpression comprises a vector expressing the Psi gene under the control of a GPD promoter (Table 5: SEQ ID NO: 20, 8,067 bp; Figure 4B).
药物和营养食品组合物以及方法Pharmaceutical and nutraceutical compositions and methods
本文提供的可以是药物或营养食品组合物,所述药物或营养食品组合物包含本文所述的经遗传修饰的细胞、生物体、真菌或植物或它们的提取物或产物。本文提供的还可以是药物或营养食品试剂,使用所述药物或营养食品试剂的方法,以及制备包含本文所述的经遗传修饰的细胞、生物体、真菌或植物或它们的提取物或产物的药物或营养食品组合物的方法。本文还提供了本文所述的药学上和营养食品适合的细胞、生物体或植物或它们的提取物、衍生物或产物。Provided herein can be a pharmaceutical or nutraceutical composition comprising a genetically modified cell, organism, fungus or plant described herein or an extract or product thereof. Also provided herein are pharmaceutical or nutraceutical agents, methods of using the pharmaceutical or nutraceutical agents, and preparations comprising the genetically modified cells, organisms, fungi or plants described herein, or extracts or products thereof Methods of pharmaceutical or nutraceutical compositions. Also provided herein are cells, organisms or plants or extracts, derivatives or products thereof suitable for the pharmaceutically and nutraceuticals described herein.
在一些情况下,本文所述的经遗传修饰的细胞、生物体、真菌或植物或它们的提取物或产物可用作药物或营养食品剂。在一些情况下,包含此类药物或营养食品剂的组合物可用于治疗或稳定疾患或与疾患相关的症状,所述疾患如抑郁、焦虑、创伤后应激、成瘾或戒断相关的副作用(如戒烟)和心理困扰(包括癌症相关的心理困扰)。具体而言,本文所述的经遗传修饰的细胞、生物体、真菌或植物或它们的提取物、衍生物或产物可用于缓解与精神障碍和疾患相关的各种症状。In some cases, the genetically modified cells, organisms, fungi or plants described herein, or extracts or products thereof, are useful as pharmaceuticals or nutraceuticals. In some instances, compositions comprising such drugs or nutraceuticals can be used to treat or stabilize disorders or symptoms associated with disorders, such as depression, anxiety, post-traumatic stress, addiction or withdrawal-related side effects (eg smoking cessation) and psychological distress (including cancer-related psychological distress). In particular, the genetically modified cells, organisms, fungi or plants described herein or extracts, derivatives or products thereof can be used to alleviate various symptoms associated with psychiatric disorders and conditions.
在一些方面,本文所述的细胞、生物体或植物或它们的提取物或产物可用于治疗特定症状。例如,疼痛、恶心、体重减轻、消瘦、多发性硬化症、过敏、感染、血管收缩、抑郁症、偏头痛、高血压、中风后神经保护以及抑制肿瘤生长、抑制血管生成和抑制转移、抗氧化剂和神经保护剂。在一些方面,本文所述的细胞、生物体或植物或它们的提取物或产物可用于治疗另外的症状。例如,持续性肌肉痉挛(包括为多发性硬化症的特征的那些)、严重关节炎、周围神经病变、顽固性疼痛、偏头痛、需要临终照护的终末疾病、伴有顽固性头痛的脑积水、顽固性头痛综合征、神经性面部疼痛、带状疱疹、慢性非恶性疼痛、灼性神经痛、慢性炎症性脱髓鞘性多发性神经病、膀胱痛、肌阵挛、脑震荡后综合征、残肢疼痛、阻塞性睡眠呼吸暂停、创伤性脑损伤(TBI)、眼内压升高、阿片类药物(opioid)或阿片剂(opiate)戒断和/或食欲不振。In some aspects, the cells, organisms or plants described herein, or extracts or products thereof, can be used to treat a particular condition. For example, pain, nausea, weight loss, weight loss, multiple sclerosis, allergies, infections, vasoconstriction, depression, migraine, hypertension, neuroprotection after stroke and tumor growth inhibition, angiogenesis and metastasis inhibition, antioxidants and neuroprotective agents. In some aspects, the cells, organisms or plants described herein, or extracts or products thereof, can be used to treat additional symptoms. For example, persistent muscle spasms (including those that are characteristic of multiple sclerosis), severe arthritis, peripheral neuropathy, intractable pain, migraine, terminal illness requiring end-of-life care, encephalopathy with intractable headache Water, intractable headache syndrome, neuropathic facial pain, herpes zoster, chronic non-malignant pain, causalgia, chronic inflammatory demyelinating polyneuropathy, bladder pain, myoclonus, post-concussion syndrome , stump pain, obstructive sleep apnea, traumatic brain injury (TBI), elevated intraocular pressure, opioid or opiate withdrawal and/or loss of appetite.
在一些情况下,本文所述的细胞、生物体或植物或它们的提取物或产物还可包含其它药学上或营养食品上相关的化合物和提取物,包括类黄酮、单胺氧化酶抑制剂和植物甾醇(例如,芹菜素、槲皮素、大麻黄素(cannflavin)A、β-谷固醇等)。In some cases, the cells, organisms, or plants described herein, or extracts or products thereof, may also include other pharmaceutically or nutraceutically relevant compounds and extracts, including flavonoids, monoamine oxidase inhibitors, and phytosterols ( For example, apigenin, quercetin, cannflavin A, beta-sitosterol, etc.).
在一些情况下,它们的提取物或产物可经受包括保存裸盖菇素(psilocybene)、二甲基色胺或脱磷酸裸盖菇素(psilocene)的提取物的方法。本公开的提取物被设计为产生供人或动物通过吸入(通过燃烧、汽化和雾化)、口腔内颊吸收、口服施用和局部施加递送方法消耗的产品。本公开教导了一种优化方法,在所述方法中通过在干燥收获植物或真菌达到5%、10%或15%水重时进行提取来提取目标化合物。由于发生蒸发,茎通常仍然“凉爽”且“橡胶状”。此时间范围(或者如果在过程中的这一点冷冻)允许提取器最大限度地减少活性剂蒸发损失。凉爽/缓慢、-干燥与精油保存之间存在直接关联。因此,与干燥过快、或过热条件或简单地干燥过度(<10%H20)的花中的EO损失存在直接关联。本文所述的细胞、生物体或植物或它们的提取物或产物的化学提取可在不同压力和温度下使用不同相的极性和非极性溶剂来完成以选择性地或完全地提取其它具有风味、香味或药理价值的化合物,以单独或组合用于产品的配制中。提取物可成型并形成单剂量或多剂量包装,例如大麻浓缩物(dab)、小丸和load。用于选择性提取我们的栽培品种的溶剂可包括水、二氧化碳、1,1,1,2-四氟乙烷、丁烷、丙烷、乙醇、异丙醇、己烷和柠檬烯,组合或系列。本公开的提取物也可与提取物的目标纯化合物(例如大麻素或萜)组合,以进一步增强或改变所得制剂的香味、风味或药理学。在一些实施方案中,提取物补充有萜或大麻素以针对提取过程中这些化合物的任何损失进行调整。In some cases, their extracts or products can be subjected to methods comprising preserving extracts of psilocybene, dimethyltryptamine, or psilocene dephosphorylated. The extracts of the present disclosure are designed to produce products for human or animal consumption by inhalation (by combustion, vaporization, and aerosolization), intraoral buccal absorption, oral administration, and topical delivery methods. The present disclosure teaches an optimized method in which a compound of interest is extracted by extraction when the dry harvested plant or fungus reaches 5%, 10% or 15% water weight. Stems are usually still "cool" and "rubbery" due to evaporation. This time frame (or if freezing at this point in the process) allows the extractor to minimize active agent evaporative losses. There is a direct correlation between cool/slow, -drying and essential oil preservation. Therefore, there is a direct correlation to EO losses in flowers that dry too quickly, or in overheated conditions, or simply too dry (<10% H20). Chemical extraction of cells, organisms or plants or their extracts or products described herein can be accomplished using different phases of polar and non-polar solvents at different pressures and temperatures to selectively or completely extract other A compound of flavor, aroma or pharmacological value, used alone or in combination in the formulation of a product. Extracts can be shaped and formed into single-dose or multi-dose packages, such as cannabis concentrates (dabs), pellets and loads. Solvents used for selective extraction of our cultivars may include water, carbon dioxide, 1,1,1,2-tetrafluoroethane, butane, propane, ethanol, isopropanol, hexane, and limonene, in combinations or series. The extracts of the present disclosure can also be combined with the target pure compounds of the extracts (eg, cannabinoids or terpenes) to further enhance or alter the aroma, flavor, or pharmacology of the resulting formulation. In some embodiments, the extract is supplemented with terpenes or cannabinoids to adjust for any loss of these compounds during extraction.
在一些方面,本公开的经遗传修饰的生物体、衍生物或提取物可用于蒸发、生产用于电子烟的电子烟油或酊剂,或用于生产其它消费品,如食用品、香膏或局部涂抹物。在一个方面,本文提供的经修饰的组合物可用作补充剂,例如食品补充剂。在一些实施方案中,本文所述的细胞、生物体或植物或它们的提取物或产物可用于制造食用品。可食用食谱可从提取大麻素和萜开始,所述大麻素和萜然后用作各种可食用食谱的成分。用于食用品的提取方法包括提取到食用油、牛奶、奶油、香树油、面粉和黄油中。富含脂质的提取介质/食用品被认为有助于吸收到血流中。脂质可作为赋形剂与本文提供的各种组合物组合使用。在其它方面,本文提供的组合物可包括:口服形式、透皮形式、油制剂、可食用食品或食品基质、水性分散液、乳液、溶液、悬浮液、酏剂、凝胶、糖浆、气雾剂、喷雾剂、粉末、片剂、锭剂、凝胶、洗剂、糊剂、配制棒、香膏、乳膏或软膏。In some aspects, the genetically modified organisms, derivatives or extracts of the present disclosure can be used in vaporization, in the production of e-liquids or tinctures for e-cigarettes, or in the production of other consumer products such as edibles, balms or topicals smear. In one aspect, the modified compositions provided herein can be used as supplements, such as food supplements. In some embodiments, the cells, organisms or plants described herein, or extracts or products thereof, can be used to manufacture edibles. Edible recipes can start with the extraction of cannabinoids and terpenes, which are then used as ingredients in various edible recipes. Extraction methods for edibles include extraction into edible oils, milk, cream, sesame oil, flour and butter. Lipid-rich extraction media/edibles are thought to aid absorption into the bloodstream. Lipids can be used as excipients in combination with the various compositions provided herein. In other aspects, the compositions provided herein can include: oral forms, transdermal forms, oil formulations, edible food or food bases, aqueous dispersions, emulsions, solutions, suspensions, elixirs, gels, syrups, aerosols dose, spray, powder, tablet, lozenge, gel, lotion, paste, stick, balm, cream or ointment.
本文还提供了包括本文提供的组合物的药盒。药盒可包括包装、说明书和本文提供的各种组合物。在一些方面,药盒还可含有用于产生本文提供的各种植物和植物部分的另外组合物,如花盆、土壤、肥料、水和培养工具。Also provided herein are kits comprising the compositions provided herein. Kits can include packaging, instructions, and the various compositions provided herein. In some aspects, the kits may also contain additional compositions for producing the various plants and plant parts provided herein, such as pots, soil, fertilizers, water, and culturing tools.
虽然本文已经显示和描述了本公开的优选实施方案,但是对于本领域技术人员显而易见的是,此类实施方案仅以举例的方式提供。在不偏离本公开的情况下,本领域技术人员现在将想到许多变化、改变和替代。应理解的是,本文所述的本公开的实施方案的各种替代方案可用于实施本公开。这意味着以下权利要求书限定本公开的范围并且因此涵盖这些权利要求及其等效物范围内的方法和结构。While preferred embodiments of the present disclosure have been shown and described herein, it will be obvious to those skilled in the art that such embodiments are provided by way of example only. Numerous variations, changes, and substitutions will now occur to those skilled in the art without departing from this disclosure. It should be understood that various alternatives to the embodiments of the disclosure described herein may be employed in practicing the disclosure. It is intended that the following claims define the scope of the disclosure and that methods and structures within the scope of these claims and their equivalents be covered accordingly.
实施例Example
实施例1:在古巴裸盖菇中过表达Psi基因的策略Example 1: Strategies for overexpression of the Psi gene in psilocybin
步骤1.构建裸盖菇素途径表达载体。
正在构建具有不同强度的不同启动子的一组表达载体。一些启动子是蘑菇特异性的,而其它启动子来自高表达植物系统等(图5A)。然后将由这些表达载体产生农杆菌。A set of expression vectors with different promoters of different strengths are being constructed. Some promoters are mushroom specific, while others are from high expressing plant systems etc. (Fig. 5A). Agrobacterium will then be produced from these expression vectors.
步骤2.制备用于转化的蘑菇材料。
如实施例3-7所示,分离原生质体、分生孢子、菌褶组织和菌丝体以用于转化。适当方案的选择取决于待转化的蘑菇。在此,如实施例3-5和图5B所例示,分离原生质体和提取物菌褶组织。如实施例4所示从菌丝体中提取原生质体。使用农杆菌共培养的菌褶组织转化的方法在实施例6中示出。As shown in Examples 3-7, protoplasts, conidia, gill tissue, and mycelia were isolated for transformation. The choice of the appropriate protocol depends on the mushrooms to be transformed. Here, protoplasts and extract gill tissues were isolated as exemplified in Examples 3-5 and Figure 5B. Protoplasts were extracted from mycelium as shown in Example 4. A method for gill tissue transformation using Agrobacterium co-culture is shown in Example 6.
步骤3.转化
使用各种方案用来自步骤1的质粒DNA转染来自步骤2的培养的原生质体。参见实施例3-5。此外,使用各种方案用来自步骤1的农杆菌转化来自步骤2的菌褶组织。参见实施例6-7。将选择具有质粒DNA或农杆菌并入的转化体,如图5C所示。Cultured protoplasts from
步骤4.再生。
将从步骤3的转化体再生成体蘑菇,如图5D所示。Regenerate somatic mushrooms from the transformants from
步骤5.裸盖菇素分析。
将通过气相色谱/质谱分析经遗传修饰的蘑菇的裸盖菇素含量,如图5E所示。裸盖菇素占未修饰的古巴裸盖菇干重的0.63%。遗传工程化的目标是将裸盖菇素的含量提高至>6%。Genetically modified mushrooms will be analyzed for psilocybin content by gas chromatography/mass spectrometry, as shown in Figure 5E. Psilocybin constitutes 0.63% of the dry weight of unmodified Cuban psilocybin. The goal of genetic engineering is to increase the psilocybin content to >6%.
实施例2:过表达Psi基因的载体构建体Example 2: Vector constructs for overexpressing the Psi gene
已经合成了4种主要裸盖菇素合成基因(psiD/psiH/psiK/psiM)的编码序列并克隆到在35S启动子控制下的过表达载体系统(pGWB5)中。35S启动子是广泛使用的植物过表达启动子。参见表4。例如,将PsiD基因克隆到在35S启动子控制下表达PsiD基因的载体中(表5:SEQ ID NO:18,17,647bp;图3A),将PsiH基因克隆到在35S启动子控制下表达PsiH基因的载体中(表5:SEQ ID NO:17,18,494bp;图3B),将PsiK基因克隆到在35S启动子控制下表达PsiK基因的载体中(表5:SEQ ID NO:16,17,420bp;图3C),将PsiM基因克隆到在35S启动子控制下表达PsiM基因的载体中(表5:SEQ ID NO:15,17,267bp;图3D)。The coding sequences of the four major psilocybin synthesis genes (psiD/psiH/psiK/psiM) have been synthesized and cloned into an overexpression vector system (pGWB5) under the control of the 35S promoter. The 35S promoter is a widely used plant overexpression promoter. See Table 4. For example, the PsiD gene is cloned into a vector that expresses the PsiD gene under the control of the 35S promoter (Table 5: SEQ ID NO: 18, 17,647 bp; Figure 3A), and the PsiH gene is cloned into a vector that expresses the PsiH gene under the control of the 35S promoter. (Table 5: SEQ ID NO: 17, 18,494bp; Figure 3B), the PsiK gene was cloned into a vector expressing the PsiK gene under the control of the 35S promoter (Table 5: SEQ ID NO: 16, 17,420bp; Figure 3C), the PsiM gene was cloned into a vector expressing the PsiM gene under the control of the 35S promoter (Table 5: SEQ ID NO: 15, 17,267 bp; Figure 3D).
此外,还产生了多顺反子载体内串联的四种Psi基因的一体化表达载体,并且目前正在进行测试。In addition, an integrated expression vector of the four Psi genes in tandem within a polycistronic vector has also been generated and is currently being tested.
产生了具有不同启动子(包括GPD、EF1a和肌动蛋白)的其它载体,并且4种主要裸盖菇素合成基因(psiD/psiH/psiK/psiM)将被克隆到这些载体中。例如,GPD和CcDED1启动子是两种真菌特异性过表达启动子。参见表4。Psi基因将被克隆到在GcDED1启动子控制下表达Psi基因的载体中(载体主链表5:SEQ ID NO:19,9,462bp;图4A),或克隆到在GPD启动子控制下表达Psi基因的载体中(表5:SEQ ID NO:20,8,067bp;图4B)。Additional vectors with different promoters (including GPD, EF1a and actin) were generated and the 4 major psilocybin synthesis genes (psiD/psiH/psiK/psiM) will be cloned into these vectors. For example, the GPD and CcDED1 promoters are two fungal-specific overexpression promoters. See Table 4. The Psi gene will be cloned into a vector expressing the Psi gene under the control of the GcDED1 promoter (Vector Master List 5: SEQ ID NO: 19, 9,462 bp; Figure 4A), or into a vector expressing the Psi gene under the control of the GPD promoter vector (Table 5: SEQ ID NO: 20, 8,067 bp; Figure 4B).
实施例3:载体介导的原生质体转染:方案AExample 3: Vector-Mediated Protoplast Transfection: Protocol A
材料Material
将白灵侧耳菌株在25℃下在PDSA培养基(20%马铃薯、2%右旋糖、0.3%KH2PO4、0.15%MgSO4、0.0005%维生素B1、2%琼脂)上生长并保持在4℃。Pleurotus bailing strains were grown on PDSA medium (20% potato, 2% dextrose, 0.3% KH2PO4, 0.15% MgSO4, 0.0005% vitamin B1, 2% agar) at 25°C and maintained at 4°C.
菌丝体的营养培养在25℃下在PDSB培养基(不含琼脂的PDSA培养基)中进行1周。The vegetative culture of mycelia was carried out in PDSB medium (PDSA medium without agar) at 25°C for 1 week.
原生质体提取。Protoplast extraction.
通过尼龙网渗透,收集在PDSB培养基中生长7天的1gr菌丝体。Infiltrated through nylon mesh, 1 gr mycelia grown in PDSB medium for 7 days were collected.
在0.6M的MgSO4中洗涤两次。Wash twice in 0.6M MgSO4.
重悬于含有1.5%溶壁酶(lywallzyme)(广东省微生物研究所)和0.6M的MgSO4的3ml裂解缓冲液中,然后在32℃下孵育2.5小时,轻轻振荡以释放原生质体。Resuspend in 3 ml lysis buffer containing 1.5% lywallzyme (Guangdong Institute of Microbiology) and 0.6M MgSO4, then incubate at 32°C for 2.5 hours with gentle shaking to release protoplasts.
将原生质体通过具有一层1mm松散脱脂棉的玻璃注射器过滤进行纯化,并通过在4℃下以2000gf离心20分钟收集。Protoplasts were purified by filtration through a glass syringe with a layer of 1 mm loose absorbent cotton and collected by centrifugation at 2000 gf for 20 min at 4°C.
用含有0.5M甘露醇和50mM马来酸缓冲液(pH 5.5)的3ml MM缓冲液洗涤两次。Wash twice with 3 ml MM buffer containing 0.5 M mannitol and 50 mM maleic acid buffer (pH 5.5).
在2-3ml的MMC缓冲液(0.5M甘露醇、50mM pH 5.5的马来酸缓冲液、5mM CaCl2)中重悬至108–109个原生质体ml-1的浓度。Resuspend to a concentration of108-109 protoplasts ml-1in 2-3 ml of MMC buffer (0.5M mannitol, 50mM maleic acid buffer pH 5.5, 5mM CaCl2).
原生质体转化Protoplast transformation
将3ug的所需质粒、12.5ul的PTC缓冲液(25%PEG4000、10mM pH 7.5的Tris-HCl、25mM CaCl2)添加至50ul冷却的原生质体悬浮液中并充分混合。3ug of the desired plasmid, 12.5ul of PTC buffer (25% PEG4000, 10mM Tris-HCl pH 7.5, 25mMCaCl2 ) was added to 50ul of the cooled protoplast suspension and mixed well.
将混合物在冰上保持20分钟。The mixture was kept on ice for 20 minutes.
将0.5ml的PTC缓冲液添加至混合物中并轻轻混合,然后在室温下孵育5分钟。0.5 ml of PTC buffer was added to the mixture and mixed gently, then incubated at room temperature for 5 minutes.
原生质体混合物准备好用于涂铺在再生和筛选培养基上。The protoplast mixture is ready for plating on regeneration and selection media.
原生质体再生Protoplast regeneration
将原生质体混合物用1ml STC缓冲液(18.2%山梨糖醇、10mM pH 7.5的Tris-HCl、25mM CaCl2)稀释,并在25℃下涂铺在再生培养基(PDSA加1.0M山梨糖醇)上持续24小时。The protoplast mixture was diluted with 1 ml STC buffer (18.2% sorbitol, 10 mM Tris-HCl pH 7.5, 25 mM CaCl2) and plated on regeneration medium (PDSA plus 1.0 M sorbitol) at 25°C Lasts 24 hours.
在25℃下再生培养24小时后,向每个板中添加20ml筛选培养基(PDSA加0.8M山梨糖醇、80ug/ml潮霉素B、0.8%琼脂)并在25℃下在黑暗中孵育2周。After regeneration at 25°C for 24 hours, add 20ml selection medium (PDSA plus 0.8M sorbitol, 80ug/ml hygromycin B, 0.8% agar) to each plate and incubate at 25°C in the dark Two weeks.
将出现在筛选培养基上的推定转化体在含有80ug/ml潮霉素B的PDSA培养基上进行进一步的五轮继代培养以筛选稳定的转化体。一些再生原生质体在直径1-2mm时停止生长。只有通过1-2mm直径尺寸的那些才被转移至进一步的选择轮次。Putative transformants appearing on the selection medium were subjected to a further five rounds of subculture on PDSA medium containing 80ug/ml hygromycin B to screen for stable transformants. Some regenerated protoplasts stopped growing at 1-2 mm in diameter. Only those that passed the 1-2mm diameter size were transferred to further selection rounds.
平均转化效率是每微克质粒pAN7-1 DNA约3个转化体。The average transformation efficiency was about 3 transformants per microgram of plasmid pAN7-1 DNA.
DNA提取和分析DNA extraction and analysis
通过真菌DNA提取(FDE)方法从白灵侧耳的推定稳定转化体和非转化对照的菌丝体分离基因组DNA。将1克菌丝体在液氮中粉碎成粉末并在68℃下在10ml TESN缓冲液(50mMpH 7.5的Tris-HCl、100mM pH 8.0的EDTA、0.5%SDS、300mM pH 5.2的NaOAc)中消化1小时。添加3.5ml 3M NaOAc(pH 5.2)并在冰上孵育20分钟后,将消化混合物在4℃下以8000g离心20分钟。通过苯酚/氯仿提取方法提取上清液中的DNA。Genomic DNA was isolated by the fungal DNA extraction (FDE) method from the mycelia of putative stable transformants of Pleurotus bailing and non-transformed controls. 1 gram of mycelium was pulverized in liquid nitrogen and digested in 10 ml of TESN buffer (50 mM Tris-HCl pH 7.5, 100 mM EDTA pH 8.0, 0.5% SDS, 300 mM NaOAc pH 5.2) at 68°C for 1 Hour. After adding 3.5 ml of 3M NaOAc (pH 5.2) and incubating on ice for 20 minutes, the digestion mixture was centrifuged at 8000 g for 20 minutes at 4°C. DNA in the supernatant was extracted by the phenol/chloroform extraction method.
实施例4:载体介导的原生质体转化:方案BExample 4: Vector-Mediated Protoplast Transformation: Protocol B
原生质体提取和收集:Protoplast extraction and collection:
步骤1:将小块单核菌丝体接种到CYM培养基(1%麦芽糖、2%葡萄糖、0.2%酵母提取物、0.2%胰蛋白胨、0.05%MgSO47H2O、0.46%KH2PO4)中,并在25℃下生长5天,同时在230rpm下振荡。Step 1: Small pieces of monokaryotic mycelium were inoculated into CYM medium (1% maltose, 2% glucose, 0.2% yeast extract, 0.2% tryptone, 0.05% MgSO47H2O, 0.46% KH2PO4) and incubated at 25°C Grow for 5 days while shaking at 230 rpm.
步骤2:通过离心收获菌丝体,用0.7M NaCl洗涤两次,并在25℃下用酶溶液(在1MMgSO4和0.6M磷酸盐缓冲液中的50mg/ml来自哈茨木霉[Sigma-Aldrich]的裂解酶,pH 6.0)处理2.0至2.5小时。Step 2: Mycelia were harvested by centrifugation, washed twice with 0.7M NaCl, and treated with enzyme solution (50 mg/ml in 1M MgSO and 0.6M phosphate buffer from Trichoderma harzianum [Sigma-Aldrich] at 25°C. ] lyase, pH 6.0) for 2.0 to 2.5 hours.
步骤3:孵育后,通过无菌Miracloth过滤将原生质体与菌丝碎片分离,并通过以3,000×g离心10分钟收集。Step 3: After incubation, protoplasts were separated from hyphal fragments by sterile Miracloth filtration and collected by centrifugation at 3,000 x g for 10 min.
步骤4:将原生质体用1M山梨糖醇洗涤两次,并用1M山梨糖醇将原生质体密度调整至108/ml。Step 4: Wash the protoplasts twice with 1M sorbitol and adjust the protoplast density to 108/ml with 1M sorbitol.
PEG介导的转化:PEG-mediated transformation:
步骤1:将50微升原生质体(108/ml)与10μg每种质粒DNA和12.5μl的PEG溶液(40%PEG 4000,10mM Tris-HCl,pH 8.0,25mM CaCl2;过滤器灭菌)混合。Step 1: Mix 50 μl of protoplasts (108/ml) with 10 μg of each plasmid DNA and 12.5 μl of PEG solution (40
步骤2:将原生质体在冰上孵育20分钟。Step 2: Incubate the protoplasts on ice for 20 minutes.
步骤3:添加500微升PEG溶液,轻轻混合,并在室温下孵育5分钟。Step 3: Add 500 microliters of PEG solution, mix gently, and incubate for 5 minutes at room temperature.
步骤4:添加1毫升的冰冷STC缓冲液(1M山梨糖醇,10mM Tris-HCl,pH 8.0,25mMCaCl2),然后将混合物铺展在含有20ml PDAS再生琼脂培养基(PDA加0.6M蔗糖,pH 6.5)的板上。Step 4: Add 1 ml of ice-cold STC buffer (1 M sorbitol, 10 mM Tris-HCl, pH 8.0, 25 mM CaCl2 ), then spread the mixture on 20 ml of PDAS regeneration agar medium (PDA plus 0.6 M sucrose, pH 6.5) ) on the board.
步骤5:将板在25℃下孵育48小时,然后添加5ml含有600μg/ml潮霉素B(Duchefa,The Netherlands)、600μg/ml腐草霉素(Invitrogen)或60μg/ml萎锈灵(Duchefa,TheNetherlands)的PDAS培养基作为覆盖层,并将板在25℃下进一步孵育,直到出现转化体(5至7天)。Step 5: Incubate the plate at 25°C for 48 hours, then add 5 ml containing 600 μg/ml hygromycin B (Duchefa, The Netherlands), 600 μg/ml phleomycin (Invitrogen) or 60 μg/ml chlorpyrifos (Duchefa) , The Netherlands) with PDAS medium as an overlay, and the plates were further incubated at 25°C until transformants appeared (5 to 7 days).
原生质体再生:Protoplast regeneration:
步骤1:将转化体单独继代培养到含有50μg/ml潮霉素、50μg/ml腐草霉素或5μg/ml萎锈灵的新鲜PDA板上。Step 1: The transformants were individually subcultured onto fresh PDA plates containing 50 μg/ml hygromycin, 50 μg/ml phleomycin, or 5 μg/ml chlortetracycline.
步骤2:在MMP培养基(1%麦芽提取物、0.5%真菌蛋白胨、1.5%琼脂)上与相应的选择剂一起在25℃下培养20至22天后,获得古巴裸盖菇的成熟子实体。Step 2: After culturing on MMP medium (1% malt extract, 0.5% mycopeptone, 1.5% agar) at 25°C for 20 to 22 days with the corresponding selection agents, mature fruiting bodies of Psilocybe cuban were obtained.
实施例5:农杆菌介导的原生质体转化。Example 5: Agrobacterium-mediated transformation of protoplasts.
材料:菌褶组织Material: Gill tissue
从杏鲍菇的子实体切割菌幕,并无菌切除暴露的菌褶组织并切成1.0×0.5cm的片。The tentacles were cut from the fruiting bodies of Pleurotus eryngii, and the exposed gill tissue was aseptically excised and cut into 1.0 x 0.5 cm pieces.
农杆菌制备Agrobacterium preparation
将携带目标质粒载体的GV3101在补充有卡那霉素(50μg/ml)的50ml LB培养基中在28℃下生长2天至600nm处1.6的光密度。通过以4,000g离心30分钟收集细菌,然后用含有100mM MgCl2和100μM乙酰丁香酮的50ml洗涤溶液洗涤一次。在以4,000g再离心30分钟后,将细菌团块重悬于洗涤溶液中至600nm处1.0的光密度。GV3101 carrying the plasmid vector of interest was grown in 50 ml LB medium supplemented with kanamycin (50 μg/ml) for 2 days at 28° C. to an optical density of 1.6 at 600 nm. Bacteria were harvested by centrifugation at 4,000 g for 30 minutes, then washed once with 50 ml of wash solution containing 100 mM MgCl2 and 100 μM acetosyringone. After an additional 30 minutes of centrifugation at 4,000 g, the bacterial pellet was resuspended in the wash solution to an optical density of 1.0 at 600 nm.
转化(这种黑暗培养方法对于生长菌丝体和消除农杆菌非常有效)。Transformation (this dark culture method is very effective for growing mycelium and eliminating Agrobacterium).
将这些片(来自##)真空渗入农杆菌悬浮培养物中两次,持续10分钟。The sheets (from ##) were vacuum infiltrated into Agrobacterium suspension cultures twice for 10 minutes.
将抽真空的组织用三次蒸馏水洗涤,并在无菌条件下在无菌Whatman滤纸上干燥10分钟。The evacuated tissue was washed with thrice distilled water and dried on sterile Whatman filter paper for 10 min under sterile conditions.
然后将组织转移至没有培养基的无菌培养皿中,并在黑暗中在25℃下孵育7-14天。Tissues were then transferred to sterile petri dishes without medium and incubated in the dark at 25°C for 7-14 days.
为了选择,将黑暗培养的活性组织转移至含有50μg/ml潮霉素和100μg/ml头孢噻肟的PDA(马铃薯右旋糖琼脂)培养基(20%马铃薯提取物、2%右旋糖和1.5%琼脂)中并在25℃下在黑暗中培养2-3周。For selection, dark cultured viable tissues were transferred to PDA (potato dextrose agar) medium (20% potato extract, 2% dextrose and 1.5 % agar) and incubated at 25°C in the dark for 2-3 weeks.
然后将推定转化体在25℃下在黑暗中继代培养到PDA培养基上持续1周。最后,菌丝体将在振荡孵育箱中在25℃和130g下在含有PDB(不含琼脂的PDA)的液体培养基上培养2周。Putative transformants were then subcultured onto PDA medium at 25°C in the dark for 1 week. Finally, the mycelia will be cultured on liquid medium containing PDB (PDA without agar) for 2 weeks in a shaking incubator at 25°C and 130 g.
然后将通过Whatman滤纸过滤来分离菌丝体并用于进一步加工。The mycelium will then be isolated by filtration through Whatman filter paper and used for further processing.
DNA提取:将从推定转基因和未转化的蘑菇收集菌丝体,并使用预冷的研钵和研杵在液氮中研磨。在十六烷基三甲基溴化铵(CTAB)后,DNA将从菌丝体中分离出来。DNA extraction: Mycelium will be collected from putatively transgenic and untransformed mushrooms and ground in liquid nitrogen using a pre-chilled mortar and pestle. After cetyltrimethylammonium bromide (CTAB), the DNA will be isolated from the mycelium.
实施例6:农杆菌介导的菌丝体转化。Example 6: Agrobacterium-mediated transformation of mycelium.
将古巴裸盖菇菌丝体在马铃薯右旋糖琼脂(PDA)上常规保持在25℃。在MMP培养基(1%麦芽提取物、0.5%真菌蛋白胨、1.5%琼脂)上在25℃下培养20至22天后,获得古巴裸盖菇的成熟子实体。Psilocybe cuban mycelium was routinely maintained at 25°C on potato dextrose agar (PDA). After culturing on MMP medium (1% malt extract, 0.5% mycopeptone, 1.5% agar) at 25°C for 20 to 22 days, mature fruiting bodies of Psilocybe cuban were obtained.
将含有所需表达载体的根癌农杆菌菌株AGL1在补充有适当抗生素的LB培养基中生长24小时。Agrobacterium tumefaciens strain AGL1 containing the desired expression vector was grown in LB medium supplemented with appropriate antibiotics for 24 hours.
随后在200μM乙酰丁香酮存在下用农杆菌诱导培养基(AIM)(诱导培养基(IM)[含有0.5%(w/v)甘油、0.2mM乙酰丁香酮(AS)、40mM2-(N-吗啉代)乙磺酸(MES),pH 5.3的MM])将细菌培养物稀释至在660nm处0.15的光密度并且再生长5至6小时。Agrobacterium induction medium (AIM) (induction medium (IM) [containing 0.5% (w/v) glycerol, 0.2 mM acetosyringone (AS), 40 mM 2-(N- Lino)ethanesulfonic acid (MES), MM at pH 5.3]) The bacterial culture was diluted to an optical density of 0.15 at 660 nm and grown for an additional 5 to 6 hours.
使用Ultra-Turrax均质器将从通用生长培养基获得的5天龄的古巴裸盖菇菌丝体均质化,并将菌丝片段转移至新鲜的通用生长培养基中并生长24小时以得到均匀的菌丝体浆液。5-day-old Psilocybe cuban mycelia obtained from universal growth medium were homogenized using an Ultra-Turrax homogenizer and the mycelial fragments were transferred to fresh universal growth medium and grown for 24 hours to obtain Homogeneous mycelium slurry.
将100-μl菌丝体悬浮液与100μl的细菌培养物混合,然后铺展在玻璃纸盘上,覆盖在AIM琼脂板上,并在25℃下孵育48小时。The 100-μl mycelial suspension was mixed with 100 μl of the bacterial culture, then spread on cellophane dishes, overlaid on AIM agar plates, and incubated at 25 °C for 48 h.
共培养后,将玻璃纸盘转移至含有200μg/ml特美汀的PDA培养基中以杀死残余农杆菌细胞和含有100μg/ml潮霉素的PDA培养基中以选择真菌转化体。After co-cultivation, cellophane disks were transferred to PDA medium containing 200 μg/ml Timentin to kill residual Agrobacterium cells and PDA medium containing 100 μg/ml hygromycin to select for fungal transformants.
将这些在25℃下孵育直到出现潮霉素抗性菌落。随后将单独菌落转移至含有50μg/ml潮霉素的PDA培养基中。These were incubated at 25°C until hygromycin-resistant colonies appeared. Individual colonies were then transferred to PDA medium containing 50 μg/ml hygromycin.
在MMP培养基(1%麦芽提取物、0.5%真菌蛋白胨、1.5%琼脂)上与相应的选择剂一起在25℃下培养20至22天后,获得古巴裸盖菇的成熟子实体。Mature fruiting bodies of Psilocybe cuban were obtained after culturing on MMP medium (1% malt extract, 0.5% mycopeptone, 1.5% agar) with the corresponding selection agents at 25°C for 20 to 22 days.
实施例7:农杆菌介导的子实体转化。Example 7: Agrobacterium-mediated transformation of fruiting bodies.
将古巴裸盖菇在马铃薯右旋糖琼脂(PDA)上常规保持在25℃。在MMP培养基(1%麦芽提取物、0.5%真菌蛋白胨、1.5%琼脂)上在25℃下培养20至22天后,获得古巴裸盖菇的成熟子实体。Psilocybe cuban was routinely maintained at 25°C on potato dextrose agar (PDA). After culturing on MMP medium (1% malt extract, 0.5% mycopeptone, 1.5% agar) at 25°C for 20 to 22 days, mature fruiting bodies of Psilocybe cuban were obtained.
将含有所需表达载体的根癌农杆菌菌株AGL-1在补充有适当抗生素的LB培养基中生长24小时。Agrobacterium tumefaciens strain AGL-1 containing the desired expression vector was grown in LB medium supplemented with appropriate antibiotics for 24 hours.
随后在200μM乙酰丁香酮存在下用农杆菌诱导培养基(AIM)将细菌培养物稀释至在660nm处0.15的光密度并且再生长5至6小时。The bacterial culture was then diluted to an optical density of 0.15 at 660 nm with Agrobacterium induction medium (AIM) in the presence of 200 μM acetosyringone and grown for an additional 5 to 6 hours.
使用解剖刀从MMP板上切下成熟子实体(成熟但在菌褶暴露之前)并切成小切片。Mature fruiting bodies (mature but before gill exposure) were excised from MMP plates using a scalpel and cut into small sections.
将子实体菌褶组织片与诱导的根癌农杆菌培养物混合并真空渗入,直到不再出现气泡。The fruiting body gill tissue pieces were mixed with the induced A. tumefaciens culture and vacuum infiltrated until no more air bubbles appeared.
将渗入的菌褶片转移至覆盖在AIM琼脂板上的纤维素盘上。如实施例6所述进行转化体的共培养和选择。The infiltrated gill sheets were transferred to cellulose discs covered on AIM agar plates. Co-cultivation and selection of transformants was performed as described in Example 6.
共培养后,将玻璃纸盘转移至含有200μg/ml特美汀的PDA培养基中以杀死残余农杆菌细胞和含有100μg/ml潮霉素的PDA培养基中以选择真菌转化体。After co-cultivation, cellophane disks were transferred to PDA medium containing 200 μg/ml Timentin to kill residual Agrobacterium cells and PDA medium containing 100 μg/ml hygromycin to select for fungal transformants.
将这些在25℃下孵育直到出现潮霉素抗性菌落。随后将单独菌落转移至含有50μg/ml潮霉素的PDA培养基中。These were incubated at 25°C until hygromycin-resistant colonies appeared. Individual colonies were then transferred to PDA medium containing 50 μg/ml hygromycin.
在MMP培养基(1%麦芽提取物、0.5%真菌蛋白胨、1.5%琼脂)上与相应的选择剂一起在25℃下培养20至22天后,获得古巴裸盖菇的成熟子实体。Mature fruiting bodies of Psilocybe cuban were obtained after culturing on MMP medium (1% malt extract, 0.5% mycopeptone, 1.5% agar) with the corresponding selection agents at 25°C for 20 to 22 days.
实施例8:转化、转染和再生Example 8: Transformation, transfection and regeneration
将古巴裸盖菇在不同的底物上繁殖和生长,以产生成熟的结实蘑菇和菌丝体,如图6所示。将古巴裸盖菇在室温下在PDA琼脂(图6A和图6B)以及还在大麦-珍珠岩堆肥(图6C)中生长7天。The psilocybin mushrooms were propagated and grown on different substrates to produce mature firm mushrooms and mycelium, as shown in Figure 6. Psilocybe cuban was grown for 7 days at room temperature on PDA agar (Figures 6A and 6B) and also in barley-perlite compost (Figure 6C).
使用实施例3-7中描述的转化或转染方案,使用实施例2中描述的pGWB5载体转化担子菌纲真菌。转化包括单独和组合的不同Psi基因(使用多个不同的载体,或具有多个Psi基因的载体)。The Basidiomycete fungi were transformed using the pGWB5 vector described in Example 2 using the transformation or transfection protocols described in Examples 3-7. Transformation involves different Psi genes individually and in combination (using multiple different vectors, or vectors with multiple Psi genes).
例如,从蘑菇菌褶中提取组织并通过实施例3-7中描述的农杆菌介导的转化来转化Psi基因。For example, tissue is extracted from mushroom gills and transformed with the Psi gene by Agrobacterium-mediated transformation as described in Examples 3-7.
原生质体由菌丝体产生并用PEG介导的转染转化Psi基因。用农杆菌介导的转化来转化菌丝体。Protoplasts were generated from mycelium and transformed with Psi gene using PEG-mediated transfection. Mycelia were transformed with Agrobacterium-mediated transformation.
在多个转化真菌再生后,将进行多核苷酸分析以确认基因整合并测定RNA表达水平。此外,将测定被破坏的基因的mRNA和蛋白质水平。还将测定植物组织中一种或多种生物活性代谢物如萜或大麻素的含量。例如,裸盖菇素和/或脱磷酸裸盖菇素中的一者或多者的含量将通过本领域普通技术人员已知的程序测定。After regeneration of multiple transformed fungi, polynucleotide analysis will be performed to confirm gene integration and determine RNA expression levels. In addition, the mRNA and protein levels of the disrupted genes will be determined. The content of one or more biologically active metabolites such as terpenes or cannabinoids in plant tissue will also be determined. For example, the content of one or more of psilocybin and/or dephosphorylated psilocybin will be determined by procedures known to those of ordinary skill in the art.
表5.裸盖菇素表达载体序列。Table 5. Sequences of psilocybin expression vector.
| Application Number | Priority Date | Filing Date | Title |
|---|---|---|---|
| US201962909159P | 2019-10-01 | 2019-10-01 | |
| US62/909,159 | 2019-10-01 | ||
| PCT/US2020/053842WO2021067626A2 (en) | 2019-10-01 | 2020-10-01 | Genetic engineering of fungi to modulate tryptamine expression |
| Publication Number | Publication Date |
|---|---|
| CN114787363Atrue CN114787363A (en) | 2022-07-22 |
| Application Number | Title | Priority Date | Filing Date |
|---|---|---|---|
| CN202080084021.XAPendingCN114787363A (en) | 2019-10-01 | 2020-10-01 | Genetically engineering fungi to regulate tryptamine expression |
| Country | Link |
|---|---|
| US (2) | US20220306997A1 (en) |
| EP (1) | EP4038192A4 (en) |
| JP (2) | JP2022550463A (en) |
| KR (1) | KR20220092509A (en) |
| CN (1) | CN114787363A (en) |
| AU (1) | AU2020358720A1 (en) |
| CA (1) | CA3152752A1 (en) |
| IL (1) | IL291839A (en) |
| WO (1) | WO2021067626A2 (en) |
| Publication number | Priority date | Publication date | Assignee | Title |
|---|---|---|---|---|
| CN118754841A (en) | 2020-05-19 | 2024-10-11 | 赛本爱尔兰有限公司 | Deuterated tryptamine derivatives and methods of use |
| WO2023015279A1 (en)* | 2021-08-05 | 2023-02-09 | Miami University | Methods for the production of methylated tryptamine derivatives, intermediates or side products |
| WO2023043942A1 (en)* | 2021-09-15 | 2023-03-23 | Blue Sun Mycology Group, LLC | Methods of producing somatic hybrid and cybrid organisms |
| EP4457336A2 (en) | 2021-12-31 | 2024-11-06 | Empyrean Neuroscience, Inc. | Genetically modified organisms for producing psychotropic alkaloids |
| WO2023164092A1 (en)* | 2022-02-25 | 2023-08-31 | Parow Entheobiosciences Llc | Treatment of psychiatric disorders, brain injuries, and autism spectrum disorder |
| US12060328B2 (en) | 2022-03-04 | 2024-08-13 | Reset Pharmaceuticals, Inc. | Co-crystals or salts of psilocybin and methods of treatment therewith |
| US20250255913A1 (en)* | 2022-08-11 | 2025-08-14 | Luminous Mind Inc. | Non-hallucinogenic psychedelic fungi |
| Publication number | Priority date | Publication date | Assignee | Title |
|---|---|---|---|---|
| WO2017123676A1 (en)* | 2016-01-11 | 2017-07-20 | Synlogic, Inc. | Recombinant bacteria engineered to treat diseases and disorders associated with amino acid metabolism and methods of use thereof |
| US20190282628A1 (en)* | 2016-01-11 | 2019-09-19 | Synlogic Inc. | Recombinant bacteria engineered to treat diseases and disorders associated with amino acid metabolism and methods of use thereof |
| WO2019180309A1 (en)* | 2018-03-19 | 2019-09-26 | Teknologian Tutkimuskeskus Vtt Oy | Heterologous production of psilocybin |
| US20210108238A1 (en)* | 2018-03-08 | 2021-04-15 | New Atlas Biotechnologies Llc | Processes for the production of tryptamines |
| CN114829381A (en)* | 2019-10-01 | 2022-07-29 | 恩派瑞安神经科学公司 | Genetically modified plants and methods for making the same |
| CN116348448A (en)* | 2020-07-24 | 2023-06-27 | 明德赛特制药公司 | Scalable synthetic routes to siloxine and silodosin |
| CN116348106A (en)* | 2020-09-01 | 2023-06-27 | 恩维瑞克生物科学加拿大公司 | Halogenated nupharicin derivatives and methods of use |
| CN117222622A (en)* | 2021-02-12 | 2023-12-12 | 恩维瑞克生物科学加拿大公司 | Polysubstituted galectin derivative and use method thereof |
| WO2024035954A2 (en)* | 2022-08-11 | 2024-02-15 | Luminous Mind Inc. | Non-hallucinogenic psychedelic fungi |
| Publication number | Priority date | Publication date | Assignee | Title |
|---|---|---|---|---|
| LU36879A1 (en) | 1958-02-21 | |||
| ATE506948T1 (en) | 2003-10-03 | 2011-05-15 | Veijlen N V | USE OF IGF-1 SERUM LEVEL-INCREASE INDOLEACETIC ACID DERIVATIVES FOR PRODUCING A MEDICINAL PRODUCT FOR THE TREATMENT OF VARIOUS DISEASES |
| US10183001B1 (en) | 2007-05-22 | 2019-01-22 | Pisgah Laboratories, Inc. | Opioid and attention deficit hyperactivity disorder medications possessing abuse deterrent and anti-dose dumping safety features |
| SI2963031T1 (en) | 2007-11-30 | 2019-04-30 | Zynerba Pharmaceuticals, Inc. | Prodrugs of tetrahydrocannabinol, compositions comprising prodrugs of tetrahydrocannabinol and methods of using the same |
| CA3066426A1 (en) | 2008-01-09 | 2009-07-16 | Charleston Laboratories, Inc. | Pharmaceutical compositions comprising an antiemetic and an opioid analgesic |
| CN102046157A (en) | 2008-06-19 | 2011-05-04 | Lts罗曼治疗方法有限公司 | Cationic active agent transdermal delivery composition |
| EP2258218A1 (en) | 2009-06-02 | 2010-12-08 | Nestec S.A. | Nutritional Composition for Supporting Brain Development and Function of Toddlers |
| CL2009001747A1 (en) | 2009-08-20 | 2010-09-10 | Galvan Gonzalez Tomas Bernardo | Pharmaceutical composition comprising 0.05-0.3% hydrogen peroxide, 0.001-0.03% eugenol, 0.001-0.01% camphor, 0.001-0.5% of a salt of zinc or other heavy metals defined, 1-1.2% sodium fluoride, 2-7% xylitol and excipients; Preparation method; use to prevent and / or treat oral diseases. |
| NZ719881A (en) | 2010-07-22 | 2016-12-23 | Sun Pharmaceutical Ind Australia Pty Ltd | Plant cytochrome p450 |
| PL2731451T3 (en) | 2011-07-12 | 2019-03-29 | Impossible Foods Inc. | Methods and compositions for consumables |
| CN108570464B (en) | 2011-08-08 | 2021-12-21 | 国际香料香精公司 | Compositions and methods for the biosynthesis of vanillin or vanillin beta-D-glucoside |
| WO2014008138A2 (en) | 2012-07-03 | 2014-01-09 | Sio2 Medical Products, Inc. | SiOx BARRIER FOR PHARMACEUTICAL PACKAGE AND COATING PROCESS |
| EP2920273A1 (en) | 2012-11-15 | 2015-09-23 | BASF Corporation | Mulch and potting soil compositions containing microorganisms and related methods |
| KR20150105979A (en) | 2013-01-11 | 2015-09-18 | 임파서블 푸즈 인크. | Non-dairy cheese replica comprising a coacervate |
| RU2670750C9 (en) | 2013-03-10 | 2018-12-13 | Перитек Фарма Лтд. | Topical compositions and methods of treatment of topical disorders |
| EP2810640A1 (en) | 2013-06-03 | 2014-12-10 | Basf Se | Esters of oligohydroxy carboxylic acids and their use |
| US9938314B2 (en) | 2013-11-21 | 2018-04-10 | Somalogic, Inc. | Cytidine-5-carboxamide modified nucleotide compositions and methods related thereto |
| CA2940621C (en) | 2014-03-14 | 2022-03-15 | Raqualia Pharma Inc. | Azaspiro derivatives as trpm8 antagonists |
| US9538418B2 (en) | 2014-05-08 | 2017-01-03 | Intel IP Corporation | Apparatus, system and method of communicating wireless local area network (WLAN) offloading information between cellular managers |
| BR112016026596A2 (en) | 2014-06-26 | 2017-08-15 | Hoffmann La Roche | INDOLIN-2-ONE OR PYROLO-PYRIDIN-2-ONE DERIVATIVES, THEIR USE, PHARMACEUTICAL COMPOSITION AND COMBINATION |
| US9528093B2 (en)* | 2014-08-21 | 2016-12-27 | Mycomagic Biotechnology Co., Ltd. | Recombinant polynucleotide and a transgenic Flammulina velutipes carrying the same |
| KR20180025835A (en) | 2015-06-30 | 2018-03-09 | 다이이찌 산쿄 가부시키가이샤 | Pharmaceutical composition provided with abuse-prevention function |
| EP3371174B1 (en) | 2015-11-06 | 2021-03-17 | H. Hoffnabb-La Roche Ag | Indolin-2-one derivatives |
| CR20180255A (en) | 2015-11-06 | 2018-06-22 | Hoffmann La Roche | DERIVATIVES OF INDOLIN-2-ONA |
| WO2017076931A1 (en) | 2015-11-06 | 2017-05-11 | F. Hoffmann-La Roche Ag | Indolin-2-one derivatives for use in the treatment of cns and related disorders |
| US20220079881A1 (en) | 2016-03-03 | 2022-03-17 | Ctt Pharma Inc. | Orally Administrable Composition |
| US20180021326A1 (en) | 2016-07-23 | 2018-01-25 | Paul Edward Stamets | Compositions and methods for enhancing neuroregeneration and cognition by combining mushroom extracts containing active ingredients psilocin or psilocybin with erinacines or hericenones enhanced with niacin |
| US20210069170A1 (en) | 2016-07-23 | 2021-03-11 | Paul Edward Stamets | Tryptamine compositions for enhancing neurite outgrowth |
| US10596378B2 (en) | 2016-10-18 | 2020-03-24 | Joseph Rustick | Method for treatment of depression using synaptic pathway training |
| WO2018112459A1 (en) | 2016-12-16 | 2018-06-21 | uBiome, Inc. | Method and system for characterizing microorganism-related conditions |
| NL2018190B1 (en) | 2017-01-18 | 2018-07-26 | Procare Beheer B V | Psilocybin or psilocin in combination with cannabinoid |
| US11974984B2 (en) | 2017-02-09 | 2024-05-07 | Caamtech, Inc. | Compositions and methods comprising a combination of serotonergic drugs |
| US12414936B2 (en) | 2017-02-09 | 2025-09-16 | Caamtech, Inc. | Compositions comprising a serotonergic tryptamine compound |
| AU2018217829A1 (en) | 2017-02-09 | 2019-09-12 | CaaMTech, LLC | Compositions and methods comprising a psilocybin derivative |
| GB2571696B (en) | 2017-10-09 | 2020-05-27 | Compass Pathways Ltd | Large scale method for the preparation of Psilocybin and formulations of Psilocybin so produced |
| CA3081751A1 (en) | 2017-11-03 | 2019-05-09 | Aclaris Therapeutics, Inc. | Substituted pyrrolopyrimidine jak inhibitors and methods of making and using the same |
| WO2019109124A1 (en) | 2017-12-04 | 2019-06-13 | Lecouteur David | Compositions and methods for modulating liver endothelial cell fenestrations |
| WO2019162949A1 (en) | 2018-02-26 | 2019-08-29 | Termotera Ltd. | Cooling, heating and humidity stabilization using humidity fluctuations |
| EP3572078A1 (en) | 2018-05-24 | 2019-11-27 | ETH Zurich | Tomm6-interacting extracts and compounds for use in the treatment and prophylaxis of nervous system diseases |
| CA3144504A1 (en) | 2018-06-21 | 2019-12-21 | Robert John Petcavich | Method of inducing dendritic and synaptic genesis in neurodegenerative chronic diseases |
| WO2020023084A1 (en) | 2018-07-26 | 2020-01-30 | Applied Biology, Inc. | Taar receptor agonists for the treatment of alopecia |
| CA3109192A1 (en) | 2018-08-10 | 2020-02-13 | Aclaris Therapeutics, Inc. | Pyrrolopyrimidine itk inhibitors |
| WO2020041329A1 (en) | 2018-08-20 | 2020-02-27 | Yale University | Combination therapy for treating or preventing depression or other mood diseases |
| AU2020215150B8 (en) | 2019-01-30 | 2025-07-03 | Diamond Therapeutics Inc. | Methods and compositions comprising a 5HT receptor agonist for the treatment of psychological, cognitive, behavioral, and/or mood disorders |
| KR20210133986A (en) | 2019-02-22 | 2021-11-08 | 에벨로 바이오사이언시즈, 인크. | bacterial membrane preparations |
| AU2020231231A1 (en) | 2019-03-07 | 2021-10-07 | Arbormentis LLC | Compositions and methods of use comprising substances with neural plasticity actions administered at non-psychedelic/psychotomimetic dosages and formulations |
| CA3138100A1 (en) | 2019-04-17 | 2020-10-22 | Compass Pathfinder Limited | Treatment of depression and other various disorders with psilocybin |
| PH12021552036A1 (en) | 2019-05-02 | 2022-05-23 | Aclaris Therapeutics Inc | Substituted pyrrolopyridines as jak inhibitors |
| US20200352206A1 (en) | 2019-05-08 | 2020-11-12 | Christine Wagner-Salvini | Composition and method for mushroom mycelial compound and botanical mixture |
| WO2020255151A1 (en) | 2019-06-18 | 2020-12-24 | Neelima Anil Malik | A lip posture corrector |
| CA3046911A1 (en) | 2019-06-18 | 2020-12-18 | Douglas A. Whyte | Electronically-active cannabinoids |
| US20210015738A1 (en) | 2019-07-17 | 2021-01-21 | Concept Matrix Solutions | Oral dissolvable film containing psychedelic compound |
| US11766445B2 (en) | 2019-07-18 | 2023-09-26 | Concept Matrix Solutions | Oral soft gel capsule containing psychedelic compound |
| AU2020319012A1 (en) | 2019-07-23 | 2022-02-24 | Caamtech, Inc. | Compositions containing toad secretion compounds |
| CA3050553A1 (en) | 2019-07-25 | 2021-01-25 | Michael D. Forrest | Therapeutic modifiers of the reverse mode of atp synthase |
| AU2019208238A1 (en) | 2019-07-26 | 2021-02-11 | Forrest, Michael David DR | Therapeutic Modifiers of the Reverse Mode of ATP Synthase |
| WO2021052989A1 (en) | 2019-09-16 | 2021-03-25 | Danmarks Tekniske Universitet | Yeast cells and methods for production of tryptophan derivatives |
| WO2021076849A1 (en) | 2019-10-16 | 2021-04-22 | Caamtech Llc | New kratom compositions |
| US11441164B2 (en) | 2019-11-15 | 2022-09-13 | Cb Therapeutics, Inc. | Biosynthetic production of psilocybin and related intermediates in recombinant organisms |
| AU2020386445A1 (en) | 2019-11-19 | 2022-06-02 | Paul Edward Stamets | Tryptamine compositions for enhancing neurite outgrowth |
| CA3166524A1 (en) | 2019-12-31 | 2021-07-08 | Cure Pharmaceutical Holding Corp. | Oral dissolvable film and method of manufacturing and using the same |
| US20210236523A1 (en) | 2020-02-05 | 2021-08-05 | Yale University | Psychedelic treatment for headache disorders |
| US11780808B2 (en) | 2020-02-27 | 2023-10-10 | Caamtech, Inc. | Crystalline bis-miprocin fumarate |
| US20210267977A1 (en) | 2020-02-28 | 2021-09-02 | Universitätsspital Basel | Controlling effects after 5ht2a agonists administration |
| US20220071946A1 (en) | 2020-03-03 | 2022-03-10 | Alte Verde Llc | Cannabis Treatment of Insomnia, Pain, and Skin Conditions |
| US11801278B2 (en) | 2020-03-05 | 2023-10-31 | Cure Pharmaceutical, Inc. | Method for obtaining an extract of a plant biomass |
| AU2021237646B2 (en) | 2020-03-19 | 2023-05-11 | Caamtech, Inc. | Crystalline norpsilocin compounds |
| EP4120820A4 (en) | 2020-03-19 | 2024-04-17 | Caamtech, Inc. | CRYSTALLINE PSILACETIN DERIVATIVES |
| US20230115209A1 (en) | 2020-03-20 | 2023-04-13 | Orthogonal Thinker, Inc. | Psilocybin and psilocin containing compositions and methods of using and making the same |
| US11358934B2 (en) | 2020-03-23 | 2022-06-14 | Caamtech, Inc. | Crystalline forms of psilacetin |
| WO2021202730A1 (en) | 2020-04-01 | 2021-10-07 | The Regents Of The University Of California | Molecularly-initiated, experientially-delivered treatments and systems for practicing same |
| EP4132527A4 (en) | 2020-04-07 | 2024-04-24 | Caamtech, Inc. | CRYSTALLINE 5-METHOXY-N,N-DIALLYLTRYPTAMINE COMPOUNDS |
| US20210392933A1 (en) | 2020-04-10 | 2021-12-23 | Daniel Lilly | Medicinal food products and methods for producing said products |
| CA3175211A1 (en) | 2020-04-13 | 2021-10-21 | Matthias Emanuel LIECHTI | Lsd dose identification |
| MX2022012537A (en) | 2020-04-16 | 2022-11-07 | Pike Therapeutics Inc | Transdermal micro-dosing delivery of psychedelics derivatives. |
| EP4135713A4 (en) | 2020-04-17 | 2024-04-17 | Revive Therapeutics Ltd. | USE OF PSILOCYBIN IN THE TREATMENT OF NEUROLOGICAL BRAIN INJURY AND MIGRAINE |
| EP4138801A4 (en) | 2020-04-20 | 2024-07-10 | Lobe Sciences Ltd. | METHODS FOR TREATING MILD TRAUMATIC BRAIN INJURY, POST-TRAUMATIC STRESS DISORDER AND MILD TRAUMATIC BRAIN INJURY |
| JP2023526776A (en) | 2020-05-01 | 2023-06-23 | エマージェクス ユーエスエー コーポレーション | Transdermal drug delivery device with microprojections coated with psilocybin, lysergic acid diethylamide or 3,4-methylenedioxymethamphetamine |
| US11858896B2 (en) | 2020-05-04 | 2024-01-02 | Caamtech, Inc. | Crystalline dimethyl tryptamine analogues |
| KR20230006554A (en) | 2020-05-05 | 2023-01-10 | 유니버지퇴트슈피탈 바젤 | MDMA treatment to enhance the acute affective effect profile of LSD, psilocybin, or other hallucinogens |
| EP4146198A4 (en) | 2020-05-08 | 2024-05-15 | Psilera Inc. | NEW COMPOSITIONS OF SUBSTANCES AND PHARMACEUTICAL COMPOSITIONS |
| CN118754841A (en) | 2020-05-19 | 2024-10-11 | 赛本爱尔兰有限公司 | Deuterated tryptamine derivatives and methods of use |
| US11926590B2 (en) | 2020-05-20 | 2024-03-12 | Caamtech, Inc. | Crystalline 4-hydroxy-N,N-di-n-propyltryptammonium (4-HO-DPT) salts |
| EP4152959A4 (en) | 2020-05-21 | 2024-07-03 | Chan Zuckerberg Biohub, Inc. | High-complexity synthetic gut bacterial communities |
| WO2021243460A1 (en) | 2020-06-03 | 2021-12-09 | Neonmind Biosciences Inc. | Method for weight loss with therapy |
| CA3181733A1 (en) | 2020-06-06 | 2021-12-09 | Laura Flatauer PEIFFER | Enzymes and regulatory proteins in tryptamine metabolism |
| CA3182182A1 (en) | 2020-06-10 | 2021-12-16 | Florence Wagner | Isotryptamine psychoplastogens and uses thereof |
| CN119613319A (en) | 2020-06-12 | 2025-03-14 | 贝克利心理科技有限公司 | Compositions containing benzoate salt of 5-methoxy-N,N-dimethyltryptamine |
| MX2022016533A (en) | 2020-06-17 | 2023-04-05 | Psilo Scientific Ltd | COMPOSITIONS THAT INCLUDE PSYCHOACTIVE COMPOUNDS OF PSYCHOACTIVE ORGANISMS. |
| CA3124367C (en) | 2020-06-17 | 2022-04-26 | Psilo Scientific Ltd. | Aqueous extraction of psychoactive compounds from psilocybin fungus |
| CA3173030C (en) | 2020-06-17 | 2024-05-14 | Psilo Scientific Ltd. | Predominantly phosphorylated psychoactive alkaloid extraction using alkali |
| US20210407643A1 (en) | 2020-06-25 | 2021-12-30 | Greenway Dna Inc. | Methods and systems for providing a personalized treatment regimen using cannabinoid or psychedelic compounds |
| CN119285526A (en) | 2020-06-30 | 2025-01-10 | 瑞安神经科学公司 | Tryptamine prodrugs |
| US20230277568A1 (en) | 2020-07-10 | 2023-09-07 | Eleusis Therapeutics Us, Inc. | Method of treatment for psilocybin or psilocin infusion |
| WO2022018709A1 (en) | 2020-07-21 | 2022-01-27 | Ai Pharmaceuticals Jamaica Limited | Compositions and methods for treatment of psychoses and psychotic disorders |
| CA3186958A1 (en) | 2020-07-29 | 2022-02-03 | Judith BLUMSTOCK | Extended release 5-ht receptor agonists for neurological conditions |
| US20230241231A1 (en) | 2020-08-03 | 2023-08-03 | Silo Pharma, Inc. | Central nervous system delivery of psilocybin |
| WO2022031552A1 (en) | 2020-08-03 | 2022-02-10 | Silo Pharma, Inc. | Central nervous system delivery of nonsteroidal anti-inflammatory drugs and psilocybin |
| WO2022031907A1 (en) | 2020-08-06 | 2022-02-10 | Apollo Neuroscience, Inc. | Systems and methods of transcutaneous vibration for sexual arousal |
| CN116075499B (en) | 2020-08-21 | 2025-07-25 | 指南针探路者有限公司 | Novel dephosphorylated galectin derivatives with prodrug properties |
| WO2022040802A1 (en) | 2020-08-26 | 2022-03-03 | Magicmed Industries Inc. | Glycosylated psilocybin derivatives and methods of using |
| WO2022047580A1 (en) | 2020-09-01 | 2022-03-10 | Magicmed Industries Inc. | Hydroxylated psilocybin derivatives and methods of using |
| CA3191095A1 (en) | 2020-09-02 | 2022-03-10 | Enveric Biosciences Canada Inc. | Nitrated psilocybin derivatives and use thereof for modulating 5-ht2a receptor and for treating a psychiatric disorder |
| WO2022051578A1 (en) | 2020-09-03 | 2022-03-10 | Yale University | Psilocybin in patients with obsessive-compulsive disorder |
| WO2022061196A1 (en) | 2020-09-18 | 2022-03-24 | Mydecine Innovations Group Inc. | Novel formulations of psilocybin and psilocin compounds as serotonin agonists in combination with 3,4 methylenedioxymethamphetamine (mdma) |
| US20230364115A1 (en) | 2020-10-01 | 2023-11-16 | Mydecine Innovations Group Inc. | Novel psychedelic compositions, delivery systems and therapeutic uses thereof |
| EP4221682A2 (en) | 2020-10-02 | 2023-08-09 | Cybin IRL Limited | Methods for delivery of psychedelic medications by inhalation and systems for performing the methods |
| US11324762B2 (en) | 2020-10-08 | 2022-05-10 | Lennham Pharmaceuticals, Inc. | Deuterated derivatives of psilocybin and uses thereof |
| US11000534B1 (en) | 2020-10-08 | 2021-05-11 | Lennham Pharmaceuticals, Inc. | Deuterated derivatives of psilocybin and uses thereof |
| US20230405028A1 (en) | 2020-10-12 | 2023-12-21 | Goodcap Pharmaceuticals Ltd. | Compositions for reducing inflammation to improve or maintain mental or physical health |
| EP4229036A4 (en) | 2020-10-13 | 2024-09-04 | Caamtech, Inc. | TRYPTAMINE DERIVATIVES AND THEIR THERAPEUTIC USES |
| WO2022082058A1 (en) | 2020-10-16 | 2022-04-21 | Eleusis Therapeutics Us, Inc. | Method of treatment by tryptamine alkaloids |
| WO2022084480A1 (en) | 2020-10-21 | 2022-04-28 | Compass Pathfinder Limited | Use of benzodiazepines to increase sensitivity to psilocybin following a chronic ssri regimen |
| US20220127058A1 (en) | 2020-10-24 | 2022-04-28 | Michael Roth | Food / beverage nootropic amendment apparatus and method of use thereof |
| US20220125810A1 (en) | 2020-10-24 | 2022-04-28 | Mason Cave | Thc container apparatus and method of use thereof |
| US20220125755A1 (en) | 2020-10-24 | 2022-04-28 | Kevin Hazen | Cannabis time release apparatus and method of manufacture thereof |
| US20220125091A1 (en) | 2020-10-24 | 2022-04-28 | Mason Cave | Thc beverage preparation apparatus and method of use thereof |
| US20220211660A1 (en) | 2020-10-24 | 2022-07-07 | Mason Cave | High viscosity thc product and method of manufacture thereof |
| US20230398234A1 (en) | 2020-10-28 | 2023-12-14 | Mydecine Innovations Group Inc. | Novel fungal compoind formulations and their therapeutic methods of use |
| WO2022091051A1 (en) | 2020-10-31 | 2022-05-05 | Ai Pharmaceuticals Jamaica Limited | Cannabis compositions and emulsions |
| WO2022091061A1 (en) | 2020-11-01 | 2022-05-05 | Ai Pharmaceuticals Jamaica Limited | Cannabis compositions and nanoemulsions |
| US20220054402A1 (en) | 2020-11-05 | 2022-02-24 | Richard C Kaufman | Compositions and methods for extracting, stabilizing, and manufacturing stable dosage forms of psilocin, psychedelic drugs, entheogens, and medicinal mushrooms as nano-dimensional drug delivery structures |
| AU2021373520A1 (en) | 2020-11-06 | 2023-06-29 | Mynd Life Sciences Inc. | A method of treating depression by immune modulation |
| US20220151993A1 (en) | 2020-11-16 | 2022-05-19 | New York University | Treatment of anxiety and depression |
| WO2022104475A1 (en) | 2020-11-19 | 2022-05-27 | Magicmed Industries Inc. | Nitrilated psilocybin derivatives and methods of using |
| EP4251139A2 (en) | 2020-11-30 | 2023-10-04 | Wesana Health Inc. | Compositions and methods for treating migraine |
| US11660289B2 (en) | 2020-12-01 | 2023-05-30 | Small Pharma Ltd. | Deuterated or partially deuterated N,N-dimethyltryptamine compounds |
| IL303288A (en) | 2020-12-01 | 2023-07-01 | Small Pharma Ltd | N,N-Dimethyltryptamine compounds partially or fully deuterated |
| WO2022115944A1 (en) | 2020-12-01 | 2022-06-09 | Magicmed Industries Inc. | Carboxylated psilocybin derivatives and methods of using |
| WO2022120289A1 (en) | 2020-12-02 | 2022-06-09 | The Johns Hopkins University | Restoration of motor function post-neurological injury using psychedelics |
| CA3197923A1 (en) | 2020-12-03 | 2022-06-09 | Denton W. Hoyer | Novel psilocin analog compositions and methods of synthesizing the same |
| WO2022115960A1 (en) | 2020-12-04 | 2022-06-09 | Magicmed Industries Inc. | Aldehyde and ketone derivatives of psilocybin and methods of using |
| WO2022123232A1 (en) | 2020-12-07 | 2022-06-16 | Beckley Psytech Limited | Pharmaceutical composition comprising psilocybin or its polymorphs |
| CA3201913A1 (en) | 2020-12-09 | 2022-06-16 | Andrew R. Chadeayne | Dialkyl trytamines and their therapeutic uses |
| WO2022125949A1 (en) | 2020-12-13 | 2022-06-16 | Silo Pharma, Inc. | Use of psilocybin in cancer treatment |
| CA3200255A1 (en) | 2020-12-16 | 2022-06-23 | Andrew R. Chadeayne | Amanita muscaria compounds |
| CA3113240C (en) | 2020-12-28 | 2023-09-05 | Psilo Scientific Ltd. | Transmucosal psychoactive alkaloid composition and preparation thereof |
| WO2021205196A1 (en) | 2020-12-30 | 2021-10-14 | Muhammad Taliah | Compositions and prevention and intervention methods for covid-19 with divine ayats' fitra30 covid-19 protocol |
| WO2022150840A1 (en) | 2021-01-08 | 2022-07-14 | Miami University | Psilocybin and norbaeocystin compositions and methods of treatment |
| CN116963742A (en) | 2021-01-08 | 2023-10-27 | 纽约大学 | Treating suicidal tendencies with psilocin or psilocybin |
| AU2022206419A1 (en) | 2021-01-08 | 2023-07-13 | Caamtech, Inc. | Protected alkyl tryptamines and their therapeutic uses |
| WO2022150854A1 (en) | 2021-01-11 | 2022-07-14 | Miami University | Systems and methods for pharmaceutical production of psilocybin and intermediates or side products |
| CA3204676A1 (en) | 2021-01-11 | 2022-07-14 | Andrew R. Chaddeayne | Quaternary tryptamines and their therapeutic uses |
| WO2022155352A1 (en) | 2021-01-13 | 2022-07-21 | Dyve Biosciences, Inc. | Transdermal penetrant formulations for administration of medicaments |
| CN116981450A (en) | 2021-01-18 | 2023-10-31 | 安泰赛普生物风投二代有限责任公司 | Combination of antidepressants and dextromethorphan for the treatment of neuropsychiatric disorders |
| WO2022155751A1 (en) | 2021-01-22 | 2022-07-28 | Magicmed Industries Inc. | Prenylated psilocybin derivatives and methods of using |
| US11312684B1 (en) | 2021-02-10 | 2022-04-26 | Eleusis Therapeutics Us, Inc. | Pharmaceutically acceptable salts of psilocin and uses thereof |
| US11344564B1 (en) | 2021-08-20 | 2022-05-31 | Lennham Pharmaceuticals, Inc. | Method of treatment based on reduced monoamine oxidase a activity |
| Publication number | Priority date | Publication date | Assignee | Title |
|---|---|---|---|---|
| WO2017123676A1 (en)* | 2016-01-11 | 2017-07-20 | Synlogic, Inc. | Recombinant bacteria engineered to treat diseases and disorders associated with amino acid metabolism and methods of use thereof |
| US20190282628A1 (en)* | 2016-01-11 | 2019-09-19 | Synlogic Inc. | Recombinant bacteria engineered to treat diseases and disorders associated with amino acid metabolism and methods of use thereof |
| US20210108238A1 (en)* | 2018-03-08 | 2021-04-15 | New Atlas Biotechnologies Llc | Processes for the production of tryptamines |
| WO2019180309A1 (en)* | 2018-03-19 | 2019-09-26 | Teknologian Tutkimuskeskus Vtt Oy | Heterologous production of psilocybin |
| US20210010015A1 (en)* | 2018-03-19 | 2021-01-14 | Teknologian Tutkimuskeskus Vtt Oy | Heterologous production of psilocybin |
| CN114829381A (en)* | 2019-10-01 | 2022-07-29 | 恩派瑞安神经科学公司 | Genetically modified plants and methods for making the same |
| CN116348448A (en)* | 2020-07-24 | 2023-06-27 | 明德赛特制药公司 | Scalable synthetic routes to siloxine and silodosin |
| CN116348106A (en)* | 2020-09-01 | 2023-06-27 | 恩维瑞克生物科学加拿大公司 | Halogenated nupharicin derivatives and methods of use |
| CN117222622A (en)* | 2021-02-12 | 2023-12-12 | 恩维瑞克生物科学加拿大公司 | Polysubstituted galectin derivative and use method thereof |
| WO2024035954A2 (en)* | 2022-08-11 | 2024-02-15 | Luminous Mind Inc. | Non-hallucinogenic psychedelic fungi |
| Title |
|---|
| FRICKE, J.等: "Psilocybe cubensis strain FSU 12409 putative monooxygenase (psiH) gene, complete cds", GENBANK, 26 August 2017 (2017-08-26), pages 000993* |
| FRICKE, J.等: "Psilocybe cubensis strain FSU 12409 tryptophan decarboxylase (psiD) mRNA, complete cds", GENBANK, 26 August 2017 (2017-08-26), pages 984101* |
| HOEFGEN SANDRA等: "Facile assembly and fluorescence-based screening method for heterologous expression of bosynthetic pathways in fungi", METABOLIC ENGINEERING, 16 May 2018 (2018-05-16), pages 44 - 51* |
| JANIS FRICKE等: "Enzymatic Synthesis of Psilocybin", ANGEW CHEM INT ED ENGL, vol. 56, no. 40, 25 August 2017 (2017-08-25), pages 12352 - 12355, XP072100364, DOI: 10.1002/anie.201705489* |
| NICHOLS DE等: "Psychedelics as medicines:an emerging new paradigm", CLINCAL PHARMACOLOGY ABD THERAPEUTICS, vol. 101, no. 2, 26 December 2016 (2016-12-26)* |
| Publication number | Publication date |
|---|---|
| EP4038192A4 (en) | 2023-11-01 |
| US20220306997A1 (en) | 2022-09-29 |
| WO2021067626A2 (en) | 2021-04-08 |
| US11905535B2 (en) | 2024-02-20 |
| EP4038192A2 (en) | 2022-08-10 |
| IL291839A (en) | 2022-06-01 |
| JP2022550463A (en) | 2022-12-01 |
| WO2021067626A3 (en) | 2021-05-14 |
| KR20220092509A (en) | 2022-07-01 |
| AU2020358720A1 (en) | 2022-04-21 |
| JP2025078704A (en) | 2025-05-20 |
| CA3152752A1 (en) | 2021-04-08 |
| US20220396780A1 (en) | 2022-12-15 |
| Publication | Publication Date | Title |
|---|---|---|
| US11905535B2 (en) | Genetic engineering of fungi to modulate tryptamine expression | |
| JP5902631B2 (en) | Targeted genome modification | |
| US20220307043A1 (en) | Genetically modified plants and methods of making the same | |
| CN112585269B (en) | Methods for improving genome engineering and regeneration in plants II | |
| BR112020014017A2 (en) | CRISPR / CPF1 SYSTEMS FOR OPTIMIZED PLANTS | |
| JP2015500648A (en) | Compositions and methods for modifying a given target nucleic acid sequence | |
| US20220298523A1 (en) | Genetically modified plants and methods of making the same | |
| CN119265223A (en) | Methods for enhancing genome engineering efficiency | |
| JP2022534381A (en) | Methods and compositions for generating dominant alleles using genome editing | |
| US20190225974A1 (en) | Targeted genome optimization in plants | |
| JP7555825B2 (en) | Genome editing in plants | |
| US11788098B2 (en) | Plant transformation | |
| CN105671075A (en) | Application and fixed-point knockout method of rice OsCSA gene | |
| US20250043295A1 (en) | Modified agrobacteria for editing plants | |
| JP2013247961A (en) | Method for target alteration of double chain acceptor dna sequence in plant cell protoplast | |
| BR112018010681B1 (en) | METHOD FOR MODIFYING A TARGETED SITE, NUCLEIC ACID MODIFICATION ENZYME COMPLEX, AND, NUCLEIC ACID |
| Date | Code | Title | Description |
|---|---|---|---|
| PB01 | Publication | ||
| PB01 | Publication | ||
| SE01 | Entry into force of request for substantive examination | ||
| SE01 | Entry into force of request for substantive examination |